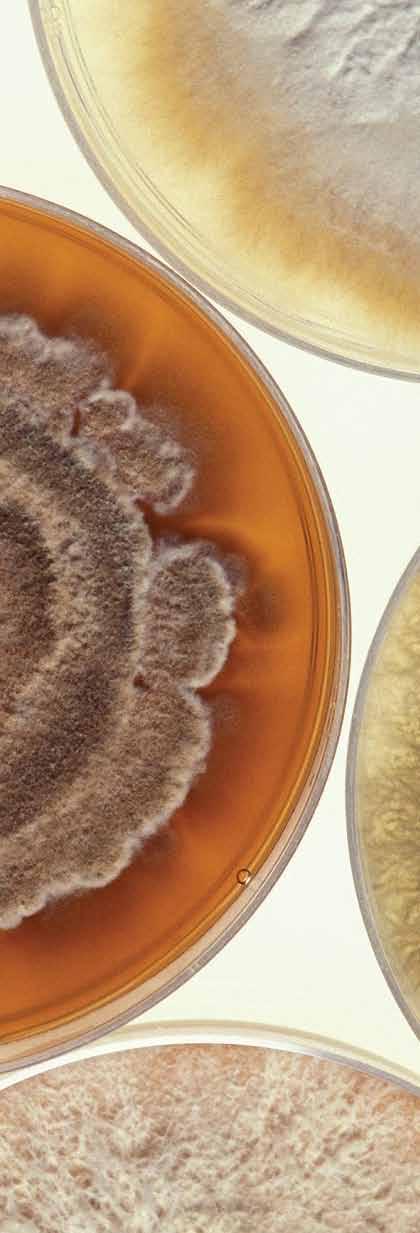

RESEARCH REPORT 2018 A
REPORT
RESEARCH
The Bambara groundnut (Vigna subterrenea) is a widespread yet under-utilised indigenous African crop. The grain legume has tremendous potential as a cash crop, owing to its nutrient-rich composition, significant functional properties and strong antioxidant potential.
CPUT’s Department of Food science and Technology has used the Bambara groundnut as a raw material to create several nutritious and marketable products. These include dairy-substitutes, baked goods, meat-substitutes and beverages, which are all gluten-, lactose- and cholesterol-free.

Contents INTRODUCTION From the Vice-Chancellor 1 From the Deputy Vice-Chancellor: Research, Technology Innovation & Partnerships 7 F RO m T he D IR e CT OR s Research Directorate 12 Centre for Postgraduate Studies 14 Technology Transfer Office 16 RTI Strategic Initiatives & Partnerships 20 CPuT Research Awards 24 DhET Publications Audit 25 National Research Foundation Rating 26 Research Funding 26 D e AN s ’ R e PO RT s Faculty of Applied Sciences 28 Faculty of Business & Management Sciences 32 Faculty of Education 36 Faculty of Engineering & the Built Environment 40 Faculty of health & Wellness Sciences 44 Faculty of Informatics & Design 52 ACAD em IC s UP PORT Centre for Innovative Educational Technology 56 CPuT Libraries 59 Fundani Centre for higher Education Development 61 hIV/Aids unit 64 Student Counselling 66
The Bambara groundnut is able to grow in all weather conditions, including drought, offering an excellent opportunity for South African farmers. The crop’s lead time is just 4-5 months, so more than one harvest can take place each year. The plants are excellent for sustainable farming, with nitrogen-fixing roots that help replenish soil nutrients.
There is a growing consciousness of and demand for healthier diets in our modern world. Among the health benefits of the Bambara groundnut are that it lowers cholesterol, stabilises blood glucose levels and acts as an effective detoxification aid.
Please see page 19 of this report for more information about CPUT’s Bambara groundnut technology portfolio.

C PUT Rese AR C h F OC U s A R e A s FOCUS AREA 1 BIO- e CO NO m Y & BIOT e C h NO LOGY 68 FOCUS AREA 2 s PA C e s CI e NC e & T e C h NO LOGY 89 FOCUS AREA 3 e N e RG Y 97 FOCUS AREA 4 CLI m AT e C h AN G e & e NV IRON me NT 109 FOCUS AREA 5 h U m AN & s OC IAL DYNA m IC s 119 FOCUS AREA 6 e CO NO m IC GROWT h & INT e RN ATIONAL CO m P e TI TIV e N es s 132 FOCUS AREA 7 D es IG N FOR s U s TA INABILITY 145
CPUT is recognised as a leading university of technology and we must continue to build on this to enable future growth

Foreword by the Vice-Chancellor Prof Chris Nhlapo
The year 2018 was an eventful time for the Cape Peninsula University of Technology. The university is very fortunate to have outstanding and committed academic and support staff who take a keen interest in nurturing our research culture. Research and Innovation (RI) is no longer an option but an obligation, and is an integral function of every full-time CPUT academic. Thanks to this, and the trajectory set by our 10-year Research, Technology and Innovation (RTI) Blueprint, our research output has grown in leaps and bounds.
Given the massive growth in RI at CPuT, it would be a challenge to cover all the exciting stories emanating from our research community. Therefore, the selected profiles are from the approved research focus areas aligned to the Sustainable Development Goals, as expressed in the united Nations Agenda 2030, South Africa’s National Development Plan, and CPuT’s own Vision 2030.
The university’s RTI Blueprint and Africa Vision 2030 focus on the following:
• Bio-Economy & Biotechnology
• Space Science & Technology

• Energy
• Climate Change & Environment
• Human & Social Dynamics (including service delivery)
• Economic Growth & International Competitiveness
• Design for Sustainability
There has been a deliberate effort to create an enabling environment in which RI can flourish. This includes investing significantly in human capital and high-end laboratory equipment. Our international research partners have increased over the last year with commendable staff and student mobility. Evidence of this is apparent in the figures below:
CPuT is recognised as a leading university of technology and we must continue to build on this to enable future growth. We are experts at teaching in a practical space, and we understand the world of technology through technological innovation and technology adoption. These strengths make our graduates especially adaptable to the rapidly changing world of work as encapsulated by the Fourth Industrial Revolution.
We are especially proud of the numerous achievements of our Technology Transfer Office. This unit is on its way to becoming one of the most effective of its kind in South Africa.
Postgraduate student numbers increased in 2018 and we are endeavouring to grow them despite the challenges related to throughput rates and supervision capacity. The classification of intervention strategies amongst our researchers into earlycareer, mid-career, established and leading researchers has assisted the institution in effectively supporting our research community, which has also had a positive impact.
Launching the first Vice-Chancellor Prestigious Award on 18 October was also a great catalyst for growth and excellence, and the celebration of World Intellectual Property Day on 25 April also raised awareness around the management of intellectual property and commercialisation of our research endeavours.
The launch of Amaya Space by the Technology Transfer Office was a
special highlight during this period. Amaya Space is primed to be the South African government’s preferred supplier of functional CubeSats fulfilling the nation’s space ambitions. Additionally, ZACube-2, which is South Africa’s most advanced nanosatellite to be launched into space, was built by the Satellite Programme of the CPuT French South African Institute of Technology (F’SATI) and is certainly a sign that CPuT is situated firmly at the heart of Africa’s space ambitions.
None of these achievements would be possible without the dedicated staff, students and stakeholders who work diligently to achieve institutional milestones. External stakeholders and funders are particularly crucial to research success. The Department of Science and Technology (DST) and the Department of higher Education and Training (DhET) can always be relied upon for their unwavering support. I am also grateful to the university Council for always encouraging the leadership and for their continued guidance.
In conclusion, I invite all staff and students, together with our many friends and stakeholders, to join us in continuing to develop CPuT as ‘One Smart university’. Our diversity is our strength, and we need your input to completely harness our full potential.
Prof Chris Nhlapo Vice-Chancellor

RESEARCH REPORT 2018 1
Publications count for 2018 Journal articles (audited) 163.36 Books (submitted) 9.00 Chapters in books (submitted) 23.91 Conference proceedings (submitted) 51.43
Voorwoord deur die Visiekanselier Prof Chris Nhlapo
2018 was ’n bedrywige tyd vir die Cape Peninsula University of Technology. Die universiteit is baie bevoorreg om uitstekende en toegewyde akademiese en ondersteuningspersoneel te hê wat aktief daarin belangstel om ons navorsingskultuur te koester. Navorsing en Innovering is nie meer ’n keuse nie, maar ’n verpligting, en maak ’n integrale deel uit van elke voltydse CPUT akademikus. Dit is te danke hieraan, en aan die trajek wat uitgestippel is in ons Tienjaar Bloudruk vir Navorsing, Tegnologie en Innovering, dat ons navorsingsuitsette met rasse skrede gegroei het.
Gegewe die massiewe groei in navorsing en innovasie by CPuT, is dit ’n uitdaging om al die opwindende stories vanuit ons navorsingsgemeenskap te dek. Om hierdie rede kom die gekose profiele van die goedgekeurde navorsingsfokusareas, soos uiteengesit in die Verenigde Nasies se Agenda 2030, asook Suid-Afrika se Nasionale Ontwikkelingsplan, en ook CPuT se eie Visie 2030.
Die universiteit se Bloudruk vir Navorsing, Tegnologie en Innovering en Afrika Visie 2030 fokus op die volgende:
• Bio-ekonomie en biotegnologie
• Ruimtewetenskap en -tegnologie
• Energie
• Klimaatsverandering en die omgewing
• Menslike en sosiale dinamika (insluitende dienslewering)
• Ekonomiese groei en inter nasionale mededingendheid
• Ontwerp vir volhoubaarheid
Daar is ’n doelgerigte poging aangewend om ’n omgewing te skep waarin navorsing en innovering kan gedy. Dit sluit in aansienlike beleggings in menslike kapitaal en die gevorderdste laboratoriumtoerusting. Ons internasionale navorsingsvennote het oor die afgelope jaar toegeneem, met
prysenswaardige mobiliteit van personeel en studente. Die bewyse hiervan kan duidelik aan die volgende syfers gesien word.
Aantal publikasies vir 2018 Vaktydskrifartikels (ge-oudit)163.36
’n groot katalisator vir groei en uitnemendheid, en die viering van Wêreld Intellektuele Eiendomsdag op 25 April het ook bewusmaking help verhoog wat betref die bestuur van intellektuele eiendom en die kommersialisering van ons navorsing.
CPuT word gereken as ’n toonaangewende universiteit vir tegnologie en ons moet hierop voortbou om toekomstige groei te verseker. Ons is deskundiges wat betref onderrig in ’n praktiese ruimte, en ons verstaan die wêreld van tegnologie aangesien ons voortdurend tegnologies innoveer en nuwe tegnologie aanwend. hierdie sterkpunte maak ons gegradueerdes veral aanpasbaar in die snel veranderende wêreld van die Vierde Industriële Revolusie.
Ons is veral trots op die talle prestasies van ons Tegnologieoordragkantoor. hierdie eenheid is onderweg om een van die effektiefste in sy soort in Suid-Afrika te word.
Die aantal nagraadse studente het in 2018 toegeneem en ons poog om hierdie getalle te laat groei ten spyte van die uitdagings wat betref deurvloeikoers en studieleidingkapasiteit. Die klassifikasie van intervensiestrategieë onder ons navorsers in vroeë-loopbaan, middel-loopbaan, gevestigde en toonaangewende navorsers het die universiteit in staat gestel om ons navorsingsgemeenskap doeltreffend te kan ondersteun, wat ook ’n positiewe impak gehad het.
Die instelling van die eerste Visiekanselier Prestige Toekenning op 18 Oktober was
Die bekendstelling van Amaya Space deur die Tegnologie-oordrag Kantoor was ’n besonderse hoogtepunt die afgelope jaar. Amaya Space is geoormerk om die Suid-Afrikaanse regering se voorkeurverskaffer van funksionele kubussatelliete (cubesats) te wees, wat daartoe sal bydra om aan ons land se ruimte-ambisies te voldoen. Verder is ZACube-2, Suid-Afrika se mees gevorderde nanosatelliet wat al gelanseer is, gebou deur die satellietprogram van F’SATI (CPuT se French–South African Institute of Technology). Dit is beslis ’n teken dat CPuT aan die voorpunt is van Afrika se ruimte-ambisies.
Geen van hierdie prestasies sou moontlik wees sonder toegewyde personeel, studente en belanghebbers wat pligsgetrou werk om die universiteit se doelwitte te bereik nie. Eksterne belanghebbers en befondsers is van besondere belang om navorsingsuksus te behaal. Die universiteit kan altyd staatmaak op die ondersteuning van die Departement van Wetenskap en Tegnologie en die Departement van hoër Onderwys en Opleiding. Ek is ook dankbaar vir die Raad van die universiteit wat altyd die leierskap bemoedig en leiding gee.
Ten slotte nooi ek alle personeel en studente, saam met ons baie vriende en belanghebbers, om by ons aan te sluit om CPuT te ontwikkel tot ’n uitmuntende universiteit – ‘One Smart university’. Ons krag lê in ons diversiteit, en ons het almal se insette nodig om tot ons volle potensiaal te ontwikkel.
Prof Chris Nhlapo Visekanselier
RESEARCH REPORT 2018 2
(ingedien) 23.91 Konferensiestukke (ingedien) 51.43
Boeke (ingedien) 9.00 hoofstukke in boeke
Long walk to peace on campus
When Prof Chris Nhlapo tells students that everything is possible, he can back it up with experience.
he was a late starter, going to school for the first time at the age of nine. It was a farm school 15km from where he lived in the small Free State town of Paul Roux. his parents were reluctant to send him to school because it was so far away, but eventually he went, walking there and back each day. he dared not take a short cut across farms. “It was very difficult; it was during 1974 and 1975,” he said.
Now Prof Nhlapo is the VC of the Cape Peninsula university of Technology. The 52-year-old doctor of science took up the post in July 2018. he joined the institution as DVC: RTIP in February 2008. Before that, he’d spent four years as Manager: Institutional Research Development at the NRF.
“I tell my students that everything is possible,” Prof Nhlapo said. The university has already boldly embraced this philosophy. In 2013 it launched Africa’s first nanosatellite, ZACube-1. In December it launched another of these 10kg satellites, ZACube-2, which carries a camera to detect forest and veld fires.
The VC speaks proudly of the calm at CPuT now following the violent #feesmustfall protests that led to buildings and vehicles being torched and damaged in the past. he believes one of the reasons for this peace is the exclusion of students with poor academic performances as members of the Student Representative Council.
“You can’t spend 10 years here without having passed first year and yet participate in the SRC. It doesn’t make sense,” he said. he said the policy of exclusion based on
poor academic performance has been applied rigorously since last year. “Some of these students were doing a four-year master’s programme but did not even have a research topic. The motive was not really studying but something else,” he elaborated. “One of the solutions is instilling an appreciation for our buildings. It should not be easy for a student to throw a petrol bomb at a building.”
Although he discussed plans for smart teaching and learning, smart research technology innovation, and incorporating technology in teaching activities, Prof Nhlapo emphasised “building oneness and togetherness” within the institution. he said that #feesmustfall had “created a lot of division between staff and students and the first prize is to build relations with labour, with staff and with students… We were in the news for all the wrong reasons and we want to reclaim the glory days.” One of the initiatives was a reunion of the class of ’75 that was attended by CPuT’s first VC, Dr Franklin Sonn.
There are 34 000 students and 842 academics at CPuT. Almost 28% of academics have a doctorate and the university wants to increase this to 42%. “We have made huge strides in transforming our academics to ensure they have the appropriate qualifications,” said Prof Nhlapo. CPuT academics who are publishing research in journals are in their early 40s, which bodes well for the creation of a new generation of academics. “The old cohort will be retiring and we are using this opportunity to bring through the young ones because they are really active in terms of research,” he said, adding that the institution’s teaching was strong, but research output was still a challenge.

RESEARCH REPORT 2018 3
CPUT elders share their knowledge
It is only by reflecting on the past that CPuT can fulfil its true potential. This was the basis for a meeting between VC, Prof Chris Nhlapo, and a few of his predecessors. Prof Nhlapo met with Dr Franklin Sonn, Prof Brian Figaji and Dr Johan Tromp in October this year, and plans to meet with other previous VCs and leaders of CPuT, Peninsula Technikon (Pen Tech) and Cape Technikon (Cape Tech) in the near future. Prof Nhlapo said seeking the counsel of those who had come before him strengthened the institution, since many former leaders had similar aspirations and their mutual ambition continues being to realise CPuT’s full potential.

The first major issue discussed was refreshing the notion of CPuT being the MIT of Africa. The idea was first touted by Dr Figaji during his term as Rector of Pen Tech, and saw many useful linkages such as funding initiatives and staff exchanges launched with the Americanbased university renowned for its engineering and science programmes. “We were talking about this back in 2000 and 2001 – CPuT being the MIT of Africa is an ambition and we need to relook at what it is they are doing and what we can do to ensure we too become a superb university of applied science,” said Prof Nhlapo.
The second project the group would like to resume is the completion of a comprehensive history of CPuT, extending beyond its official establishment in 2005. The project was started by former Pen Tech DVC Dr Tromp and comprised valuable memorabilia he had collected over the years. The final project will be re-imagining the Dome of Remembrance, situated at the Bellville Campus, within the context of the new CPuT. “I am passionate that we resuscitate the idea of the Dome of Remembrance. It is about acknowledging the staff and students who have helped build this institution. It may be in a different format, like being digitised, but I believe it’s an important thing to do,” said Prof Nhlapo.
“The slogan ‘One Smart CPuT’ is not about technical terms, but rather about the people who make up this place. These are some of the things that made us who we are, and some of these things have fallen through the cracks but it is time to revisit them.”
Amagqabantshintshi Ngusekela-Ngqonyela Njing Chris Nhlapo
Unyaka wama 2018 ubulixesha leminyadala kwiYunivesithi yezobuChwepheshe yosingasiqithi weKapa. Iyunivesithi isenyhwebeni yokuba nabasebenzi bokuphucula imfundo ephakamileyo abaphume izandla nabazinikeleyo kunye nabasebenzi abangabaxhasi abanomdla kakhulu ekuphuculeni inkcubeko yethu yezophando. UPhando nokuVelisa izinto ezintsha asinto yakhetho, koko sisigunyaziso kwaye ngundoqo kumsebenzi wakhe nabani na osebenza isigxina kuphuculo lwemfundo ephakamileyo e-CPUT. Ndiyabulela kakhulu ngale meko kunye nendlela ethe yadalwa sisicwangciso seminyaka elishumi sezoPhando, ezobuChwepheshe kunye nezokuVelisa izinto ezintsha, imveliso yethu yophando ithe yakhula kanobom.
Ngokucacileyo ukukhula kakhulu koPhando nokuVelisa izinto ezintsha e-CPuT, iza kuba ngumngeni ke ngoko into yokubandakanya onke amabali akhoyo asuka kuphando lwethu. Ngoko ke lawo achongiweyo ngalawo asuka kwiinkalo zophando ezipasisiweyo nezayamene neenjongo zophuhliso ezizinzileyo, njengoko zibekwe zacaca kwi-Agenda 2030 yeZizwe eziManyeneyo, Isicwangciso sezoPhuhliso seSizwe eMzantsi Afrika kunye noMbono wama 2030 waseCPuT.
Inkqubo yeYunivesithi yezoPhando, ezobuChwepheshe, ezokuVelisa izinto ezintsha kunye nombono we-Afrika wama 2030 ijolise koku kulandelayo:
• Ezobom noQoqosho kunye nobuChwepheshe kwezobom
• Ezenzululwazi ngomoya ojikeleze umhlaba kunye nezoboChwepheshe
• Ezamandla
• Ezokuguquka kwemozulu nokusingqongileyo
• Ezokutshintsha koluntu nezentlalo (ibandakanya unikezelo lweenkonzo)
• Ezokukhula kwezoqoqosho kunye nozokukhuphisana kumazwe ngamazwe
• Ezoyilo lokuzinzisa
Kubekho iinzame ezimandla zokwakha isimo esifanelekileyo apho uPhando nokuVelisa izinto ezintsha zinako ukugqama. Oku kubandakanya inkxaso etyhulu kubasebenzi njengeentsika nakwizixhobo zaselebhu ezikumgangatho ophezulu. Oogxa bethu kwezophando bamazwe ngamazwe bakhule kakhulu kunyaka ophelileyo ababandakanya abasebenzi abancomekayo kunye nophuhliso lwabafundi. ubungqina bale meko buduliswa zezi nkcukacha manani zingezantsi.
RESEARCH REPORT 2018 4
Prof Chris Nhlapo with former Pen Tech leaders, Dr Brian Figaji and Dr Johan Tromp
Ubalo loshicilelo lowama 2018
Tshazimpunzi nayo yonyusa ukuqonda malunga nolawulo lomsebenzi wobungqondi kunye nokunaniselana ngophando lwethu.
isikhokelo kunye nokuqhubeka linika umkhomba-ndlela.
I-CPuT ithathelwa ingqalelo njengeYunivesithi yezobuChwepheshe ekhokelayo kwaye kufuneka siqhubeke sisakha phezu kwesi siseko ukunabisa ukukhula kwexesha elizayo. Siziingcaphephe ekufundiseni ngokwenza, kwaye siyaliqonda ihlabathi lezobuchwepheshe ngokuvelisa izinto ezintsha zobuchwepheshe kunye nokwamkela ezobuchwepheshe.
Ezi ntsika zenza ukuba abafundi bethu abathweswe izidanga balungelane nemeko yokutshintsha kwehlabathi kwezemisebenzi njengoko iduliswa yiNtshukumo yeZamashishini yesiNe.
Sineqhayiya ngakumbi yoloyiso lweOfisi eDlulisa ezobuChwepheshe.
Le ofisi isendleleni yokuba ibe yenye yezo zisebenza ngokufanelekileyo eMzantsi Afrika.
Amanani abafundi abethweswe
izidanga akhulile ngonyaka
wama 2018 kwaye sizimisele ukuwakhulisa naphantsi
kwemingeni efana nezinga labaphumelelayo kunye nezoso zamakhankatha. ukuchakwa kweendlela zokungenelela kubaphandi bethu ukuya kwabaqala-ikhondo, abaphakathikwikhondo, abazinzileyo kunye
nabaphandi abakhokelayo iyincedile le yunivesithi ekuxhaseni ngokupheleleyo ummandla wethu wophando, ube nemiphumela emihle.
ukuphehlelela kwethu ngokusesikweni iMbasa yokuqala
eXabisekileyo kaSekela-Ngqonyela
ngomhla we18 kweyeDwarha yaba
lutshintsho olumandla lokukhula
kunye nogqweso kwaye imibhiyozo
yoSuku lwehlabathi lwemiSebenzi
yobuNgqondi ngomhla wama25
ukuphehlelelwa ngokusesikweni kwe-Amaya Space yi-Ofisi eDlulisa ezobuChwepheshe yaba luphawu olulodwa kwesi sihlandlo. I-Amaya Space ijoliswe ekubeni ibe yiyo uRhulumente waseMzantsi Afrika ayikhethayo ekunikezeleni umsebenzi weCubeSats ukufezekisa iimfuno zesizwe zomoya ojikeleze umhlaba. Okulandelayo, iZACube-2 eyisathelayithi ye-nano yaseMzantsi Afrika ekwizinga eliphezulu eza kuphehlelelwa
Kwelokuqukumbela, ndimema bonke abasebenzi, abafundi, kunye nabahlobo bethu abaninzi kunye nabathabathinxaxheba ukuze bazibandakanye kunye nathi kwinkqubo eqhubekayo yokuphuhlisa i-CPuT njenge ‘Yunivesithi eNye eseMgangathweni’. Iyantlukwano yethu bubungangamsha bethu, kwaye sifuna igalelo lenu ukugqibelelisa oko sinako ukukwenza.
Njing Chris Nhlapho Usekela Ngqonyela
I-CPUT ithathelwa ingqalelo
njengeYunivesithi yezobuChwepheshe ekhokelayo kwaye kufuneka siqhubeke sisakha phezu kwesi siseko ukunabisa ukukhula kwexesha elizayo
ngokusesikweni kwezomoya ojikeleze umhlaba, yathi yakhiwa yiNkqubo yeSathelayithi yaseCPuT iFrench South African Institute of Technology (F’SATI) kwaye ngokuqinisekileyo luphawu lokuba i-CPuT ihleli zinzi kwiminqweno yase-Afrika ngokuphathelele kumoya ojikeleze umhlaba.
Akukho nanye yezi mpumelelo ibiya kwenzeka ngaphandle kwabasebenzi abazinikeleyo, abafundi kunye nabathabathi nxaxheba abasebenza ngenkuthalo ukuphumeza uloyiso olubalaseleyo lweyunivesithi. Abathabathinxaxheba bangaphandle kunye nabaxhasi-mali babaluleke ngokukodwa kwimpumelelo yophando. Isebe lezeNzululwazi nezobuChwepheshe kunye nesebe lezeMfundo ePhakamileyo kunye noQeqesho aya kusoloko engamathemba ethu ngenxa yenkxaso engagungqiyo. Kwakhona ndinombulelo kwiBhunga loLawulo lweYunvesithi ngokuthi gqolo ukukhuthaza
RESEARCH REPORT 2018 5
Amaphepha eejenali (aphicothiweyo) 163.36 Iincwadi (ezingenisiweyo) 9.00 Izahluko kwiincwadi (ezingenisiweyo) 23.91 Iinkqubo zeenkomfa (ezingenisiweyo) 51.43


















RESEARCH REPORT 2018 6
by
Deputy
Research, Technology Innovation & Partnerships
(DVC: RTIP) (Acting)
Prof Marshall Sheldon
CPUT’s Research, Technology and Innovation (RTI) 10-year Blueprint provides the strategic directives and operational framework for all institutional research, technology, innovation and related activities. The RTI Blueprint aims to develop research uptake in two ways: (1) development of third-stream income by enhancing entrepreneurship opportunities, and (2) increasing research output by providing support mechanisms in terms of capacity building and funding.
This research report provides an overview of CPuT’s research activities and performance during 2018. It is a great pleasure to share some of the research, technology, innovation and engagement highlights of our very dedicated staff and students in our various academic faculties and research entities. The research report aligns these research highlights and activities to CPuT’s seven Institutional Strategic Research Focus Areas: (i) Bio-Economy & Biotechnology; (ii) Space Science & Technology; (iii) Energy; (iv) Climate Change & Environment; (v) human & Social Dynamics; (vi) Economic Growth & International Competitiveness; (vii) Design for Sustainability.
Reflecting on the 2018 academic year, CPuT can be proud of many achievements which will be detailed throughout this report:
• Celebration of World IP day on 25 April, with the theme
‘Empowering change: Women in Innovation and Creativity’

• The launch of the first Vice Chancellor Prestigious Award on 18 October for deserving postgraduate students
• Participation at numerous highlevel national and inter national prestigious conferences,
resulting in a number of staff and student awards
• Successful participation in national and international student competitions
• The start and continuation of new strategic partnership initiatives and collaborations locally, nationally and inter nationally
• Funding from a range of exter nal stakeholders for various purposes including postgraduate and postdoctoral fellow bursaries, improvement of our resources and facilities, and training and development of staff and students
• New postgraduate qualifications approved and implemented in line with the new higher Education Qualification SubFramework (HEQSF)
• An increase in third-stream income continues to be a focus, with CPuT continuing to receive external research grants and funding from various sources

One of the biggest highlights for 2018 was the successful launch of the continent’s most advanced nanosatellite, ZACube-2, into space by a Soyuz rocket on 27 December.
(The official celebration was presided over by the Deputy Minister of the Department of Science and
RESEARCH REPORT 2018 7
Foreword
the
Vice-Chancellor
As a university of technology, the value chain approach leading to the development of technology and innovation in the form of research uptake is a significant focus leading to the use of research in society, the environment, industry and government
Technology (DST) on 26 February 2019, where further support to the value of R27 million was confirmed to expand the nanosatellite programme.)
The South African Renewable Energy Technology Centre (SARETEC) secured a R6.5 million MerSETA grant to develop an Internet of Things platform (Fourth Industrial Revolution), to deliver on artisanal skills qualifications for a Solar Photovoltaic qualification. SARETEC is the first national renewable energy technology centre in South Africa. It is hosted by CPuT at its Bellville Campus. This centre focuses on specialised industryrelated and accredited training for the entire renewable energy (RE) industry including short courses and workshops.
Research output
mid-career research development of CPuT researchers, where the appetite for and uptake of research thinking is in process. CPuT continues to fund and support its research initiatives through various research funding mechanisms such as the university Research Fund (uRF); Conference attendance (ConfCom); and the Research Exchange Programme (REP).
An exciting innovation by the Department of higher Education and Training (DhET) which is sure to directly impact CPuT is the introduction of a new policy on the Evaluation of Creative Outputs and Innovations. The purpose of this policy is to recognise and reward quality creative outputs and innovations produced by public higher education institutions.
Research Chairs Initiative (SARChI) Research Chair in Cardiometabolic health (Tier 2), with effect from 1 July 2018.
National Research Foundation (NRF) and Sector Education And Training Authority (SETA) Chair extensions, renewals and replacements included:
- The Wholesale and Retail SETA extended funding for the W&RSETA Chair for a further two years
- The NRF SARChI Chair in Innovative Small Satellite Technology and Applications for Africa (ISSTAA) was approved for a new five-year cycle at Tier 2
- The NRF SARChI Chair in Teacher Education was renewed for a further five-year cycle at Tier 1
- The CPuT Chair in Literacy and Poverty, Prof Rajendra Chetty, resigned and has been replaced by Prof Janet Condy for two years (the remainder of the fiveyear cycle, beginning in 2019)
- The CPuT Chair in Biotechnology, Prof Wentzel Gelderblom, retired and has been replaced by an acting Research Chair, Prof Jeanine Marnewick
NRF ratings
At the end of 2018, CPuT had 43 NRF rated researchers with nine ratings in 2018.
Figure 1 provides the research output over the past six years.

During 2018, Senate approved the categorisation of researchers into early-career, mid-career, established and leading researchers, which will allow for a more targeted capacity development approach along with a range of new specialised support programmes. These mechanisms support the process of early- and
Research Chairs
The main goal of the Research Chairs initiative is to strengthen and improve the research and innovation capacity to produce high-quality postgraduate students and deliver R&I outputs, and more importantly contribute to research uptake which has an impact on society.
During 2018, Prof Tandi Matsha was awarded the South African
The nine 2018 NRF ratings consist of one upgrade, one retained rating and seven new ratings. The 2018 rating levels included C2 – four; C3 – three; and Y2 – two. The ratings per faculty consist of two for Applied Sciences; one for Business & Management Sciences; one for Engineering & the Built Environment; one for Informatics & Design; two for health & Wellness Sciences; one for Fundani; and one for the IBMB research institute.
These overall 43 rated researchers at the end of 2018 comprise: B1 – two; C1 – one; C2 – thirteen; C3 – twenty; Y1 – one; and Y2 – six.
RESEARCH REPORT 2018 8
Figure 1: CPUT research output from 2013 to 2018
Postgraduate students
The postgraduate student complement continues to be a very important portion of our student population. In 2018, CPuT enrolled 2 095 postgraduate students (6.2% of the total enrolment), of which 1 539 were master’s and 290 doctoral students. The total number of graduations for 2018 was 144 master’s and 23 doctoral students. The most recent Summer Graduation in December 2018 saw 104 master’s and 13 doctorate degrees conferred, underscoring the institution’s ongoing emphasis on research and postgraduate studies.
With the launch of the first VC prestigious award for postgraduate students on 18 October 2018, the first recipient of the bursary was Ms Zamavangeli Mdletshe, a doctoral student in Mechanical Engineering in the Faculty of Engineering & the Built Environment.
On 7 November 2018, we reintroduced the CPuT Postgraduate Research Day and also reintroduced the CPuT postgraduate bursaries with the first call for 2019 launched in November 2018. This was supplemented with a range of external postgraduate bursaries to the value of R9.505 million.
Technology transfer
As a university of technology, the value chain approach leading to the development of technology and innovation in the form of research uptake is a significant focus leading to the use of research in society, the environment, industry and government through our Technology Transfer Office.
At the celebration of World IP day on 25 April 2018, aligned to the theme ‘Empowering change – Women in Innovation and Creativity’, the first DVC:RTIP Innovation Award recipients were Prof Maretha Opperman and the late Prof Benade, who co-developed food supplements directed at promoting health and
reducing the risk for degenerative diseases in consumers.
The new spinout company, Amaya Space, was registered by CPuT under its fully-owned holding company, Aonyx holdings, and is set to launch the institution to even greater heights. This is a company which aims to be SA’s first truly transformed space company, run by Africans for Africans.
CPuT students participated in the 2018 edition of the South African Solar Car Challenge. An amount of R747 700 was made available for project expenses by the Technology Innovation Agency (TIA).
Awards
A staff member in the Research Directorate, Ms Shafeeqa Dramathendricks, received an NRF award for Best Financial Officer.
The Research Grants Management team, under the leadership of Prof Dina Burger, received an NRF award in the Regional Forum category in recognition of exceptional service in 2018.
Prof Yusuf Sayed (NRF SARChI Chair in Teacher Education) and Director of the Centre for International Teacher Education (CITE), received a SAERA award (South African Education Research Association). he was presented with an honours Award during the association’s 2018 conference.
Mr Keagan Canterbury (a BTech Consumer Science: Food & Nutrition) delivered the best pitch at the SATN Student PreConference his innovation focused on the development of a functional dairy-based product containing omega-3 fatty acids and carotenes.
CPuT Brewing won the Best Lager award in the SAB Intervarsity Beer Brewing Competition.
Prof Tandi Matsha was selected as a finalist in the NSTF-South32 Awards, in the category TW
Kambule-NSTF Awards: Researcher (contribution to research and its outputs over a period of up to 15 years as a researcher, predominantly in South Africa).
Prof Jeanine Marnewick was also elected as a finalist in the NSTFSouth32Awards ceremony, in the category Communication for Outreach and Creating Awareness of SET and Innovation, and was commended for her considerable work in communicating her research.
Conferences
CPuT successfully hosted several conferences including
• U6+ Conference
3-5 September: This conference was attended by vice chancellors and representatives from across Africa including CPuT; South Africa university of Cape Coast, Ghana; university of the Gambia, Gambia; university of Ilorin, Nigeria; Jaramogi Oginga Odinga university of Science and Technology, Kenya; Kwara State university, Nigeria.
• Unesco Engineering Week
17-20 September:
Representatives from government, industry and academia were among the delegates welcomed to the CPuT’s Bellville Campus. The theme of the three-day conference was ‘Enabling the Fourth Industrial Revolution for sustainability and economic growth’.
• 45th South African Society for Education Annual International Conference
3-5 October:
CPuT hosted this conference with the theme ‘Creating sustainable teaching and learning spaces, shaping futures, envisioning unity in diversity and transformation’.
• Impala Final Conference
8-10 November:
The Erasmus+ Key Action 2 is titled ‘Capacity Building in higher Education focusing on
RESEARCH REPORT 2018 9
Global Engagement in higher Education: South African and European perspectives’. The Inter nationalisation and Modernisation Programme for International Academics, Leaders and Administrators (Impala) project held its final conference to bring together all Impala communities of practice and stakeholders to look back, disseminate the project results, and look ahead.
Public lectures
CPuT hosted four public lecture events during 2018
• ‘Innovation in Society’, hosted by Prof Thomas Thur ner, with guest speakers, Prof Konstantin Fursov and Prof Vitaliy Roud, both from the higher School of Economics in Moscow
• ‘The relevance and scope of the decolonisation of education in Africa’, hosted by Impala and Fundani, with guest speaker Prof Kwesi Kwaa Prah, director of the Africa-wide Centre for Advances Studies of African Society based in Cape Town
• ‘Struggle for epistemic freedom in Africa deprovincialisation and
decolonisation’, hosted by Impala and Fundani, with guest speaker Prof Sabelo Ndlovu of unisa
• ‘Plastic components as significant source for environmental obesogens: A societal concern for human and wildlife health’, hosted by Prof Opeolu, with guest speaker Prof Augustine Arukwe from Norway
Strategic initiatives and engagements
These initiatives are in support of the RTI Blueprint. During 2018, CPuT continued existing engagements with a number of partners including the DEA project, Conversation Africa, IZIKO, CHEC, SATN, Research Ngoko, Impala, COIL, AESOP, and YEBO!
RTIP participated in presentations and discussions throughout the year to ensure a joint understanding of the One Smart CPUT to Create Futures strategy, under the Director: Strategic Initiatives & Partnerships, Prof René Pellissier. As part of the inputs into the new strategy, a review was conducted on the outcomes of Vision 2020, and the results will be used as input into the new Vision 2030.
Two esteemed researchers selected for Science Oscars
Two outstanding CPuT researchers were selected as finalists in the NSTF-South32 Awards, known as the ‘Science Oscars’ of South Africa. The awards celebrate our country’s top minds in science, engineering and technology. Winners were announced at a gala dinner at the Emperors Palace in Kempton Park on 28 June. The two finalists were Prof Tandi Matsha, who was recently awarded the NRF’s SARChI Research Chair in Cardiometabolic health, and Prof Jeanine Marnewick, who is the newly appointed Research Chair of the Institute of Biomedical & Microbial Biotechnology.
Prof Matsha is the founder and lead researcher of CPuT’s Cardiometabolic health Research unit in the Faculty of health & Wellness Sciences and was


Policy development and review
The following policies were reviewed during 2018 and the revisions were approved at Senate on 5 November:
• Research policy
• Policy on CPUT postgraduate bursaries
• Policy on postgraduate education and research
In conclusion
In conclusion, it is important to mention that the CPuT community also bid farewell to researchers who either retired, resigned or, sadly, passed on. While we were sad to part ways with individuals who retired and resigned we appreciate all their contributions and wish them well with the next phase in their careers and lives. One of them was a stalwart of CPuT, Prof Anthony Staak, our DVC: Teaching & Learning who retired in December. The extensive list of highlights achieved would not have been possible without the hard work, dedication and commitment of all our staff and students, and I thank all of you who contributed to these successes.
nominated in the category: TW Kambule-NSTF Awards: Researcher (contribution to research and its outputs over a period of up to 15 years as a researcher, predominantly in South Africa). her current research focuses on diabetes and cardiovascular risk in the coloured community of Bellville South.
Prof Marnewick has made a concerted effort to get the word out about her research into how rooibos is useful as a way to reduce and protect against the impact of noncommunicable diseases because of the tea’s antioxidant activity. She heads up the Oxidative Stress Research Centre and was nominated in the category Communication for Outreach and Creating Awareness of SET and Innovation.
RESEARCH REPORT 2018 10
Prof Jeanine Marnewick
Prof Tandi Matsha

From the Director: Research Prof Dina Burger

It is a great honour to present to you the Research Report of 2018. This has indeed been a highly productive year for the Research Directorate and the CPUT research community. There was a steady focus on driving the strategic pillar of ‘Unlocking the research potential of CPUT staff and postgraduate students’, as per the RTI Blueprint’s directive. As a result, research activity and the securing of research grants, amongst many other activities, has advanced significantly since our last report, thereby contributing meaningfully to realising our vision of rendering world-class service and support to the research community at CPUT.
This report is once again structured by presenting current research activities according to our seven focus areas: (i) Bio-Economy & Biotechnology; (ii) Space Science & Technology; (iii) Energy; (iv) Climate Change & Environment; (v) human & Social Dynamics (including service delivery); (vi) Economic Growth & International Competitiveness; and (vii) Design for Sustainability.
Some of the Research Directorate’s key highlights for 2018 include:
• The introduction of DHET’s university Capacity Development Plan (uCDP) and the university Capacity Development Grant (uCDG), which started in January 2018. The Research Directorate’s Project 3 was allocated R9 951 000 and at the end of the year the expenditure was finalised and quantified at 86% of the overall grant. Although we experienced some challenges, eight out of the ten research support activities under this grant were implemented with great success.
• The implementation of a new research support system, namely, Converis, which will replace RIMS/InfoED, has received much attention and the rollout of the research output module was concluded.
• As a strategic initiative to support early career and emerging researchers, great effort was made to ensure good
uptake of the NRF’s Thuthuka funding. Consequently, CPuT researchers secured over R3 million, with 20 of the 26 applicants having been awarded the Thuthuka Grant, which is unprecedented for CPuT.
• Another significant stride made in 2018 is that CPuT obtained R36 460 786 in grant funding from the NRF, and at the end of the year claimed R29 964 682.
• It is particularly worth noting that in the NRF rating submissions, CPuT had a 100% success rate on our submissions. To this end, all nine of our applicants obtained NRF rating. We plan to build on this achievement.
• Numerous policies and guidelines were revised, including the Research Policy, the Terms of Reference for the university Research Fund and the Terms of Reference for the Improvement of Qualifications Programme.
• A comprehensive suite of research training and capacity development interventions were implemented in 2018 to support researchers across the various career trajectories.
• The Directorate continued to provide sustained professional advisory services and support.
• The Directorate’s dedicated staff provided research finance advisory services, financial processing, administrative support, budget control services and processing of annual audits.

RESEARCH REPORT 2018 12
FROM THE DIRECTORS
We are fortunate to have partnered with our academic community and various internal and external stakeholders. In so doing, we continue to contribute to the bold ambitions of the transformation agenda of our country through research that is inspired by society and research that finds its way back to society.
• The Directorate provided research integrity and ethics management and administration.
• The annual institutional research outputs review and DhET submission process concluded in May 2018.
• Various annual and monthly research reports were prepared and submitted to the relevant committees.
• Participation in national and international research forums, associations, professional bodies and foundations was prioritised as well as strategic partnerships through the Cape higher Education Consortium (ChEC), which all comprised part of the work activities in the last reporting year, amongst various other interventions.
We are fortunate to have partnered with our academic community and various internal and external stakeholders. In so doing, we continue to contribute to the bold ambitions of the transformation agenda of our country through research that is inspired by society and research that finds its way back to society. Our researchers are driven by their desire to contribute to the scholarship of discovery, innovation and application of knowledge, especially as we move towards a knowledge-based economy.
We wish to thank our leadership at all levels for their unwavering support for the work that we do. In particular, we wish to thank and congratulate our researchers for ensuring that we can celebrate our research achievements once again this year. Much more work lies ahead for all of us, but we are resolved to continue to do more, to do it better, and to be smarter.
My sincere thanks go to my staff in the Research Directorate for their dedicated hard work, giving excellent service to our research community with pride and professionalism. I invite all our readers to join us in celebrating CPuT’s research achievements of 2018.
Two academics awarded international scholarships
Following a rigorous selection process, two CPuT academics have been awarded full doctoral scholarships under the auspices of the university Capacity Development Programme. Mr Rendani Mulaudzi, a lecturer in the Environmental Management Department, and Ms Tabisa Ncubukezi, a junior lecturer in the Information Technology Department, were welcomed into the new united States–South Africa Doctoral Programme. They will be supported in the completion of their PhD degrees and will also benefit from attending professional development courses such as writing for publication, grant writing skills, postgraduate supervision and research skills. The supervision of their work will take a group and collaborative approach, including co-supervision. They will also spend one to three months at a partner institution in the uSA
The new programme has been approved by the DhET and includes a network of 12 American universities and 18 South African universities that will work together to implement 12 doctoral programmes in order to enable 100 existing academic staff to complete their doctoral qualifications. The programme has been allocated R57.2 million in funding.
Prof Monwabisi Ralarala, Director at Fundani, and Prof Dina Burger, Research Director, who are jointly responsible for the programme at CPuT, said they believed the two academics have received a once in a lifetime opportunity to advance their doctoral degrees and they would be excellent ambassadors for their respective faculties and the university. “These two colleagues would be the first recipients of this award and the institution is committed to give them all the support they need to facilitate their successful participation in this programme. We wish them all the best with their doctoral studies,” said Prof Burger.
Ms Ncubukezi said she felt fortunate to have been selected for the new programme and the opportunity would allow her to pursue her dreams.
“I plan to continue my IT education and eventually build a career in the research and development area. With this scholarship, your generosity and support will help me focus on my research,” she said.
Prof Burger, Prof Ralarala and the two academics joined their counterparts from other universities in the programme at its launch in Johannesburg in July.

RESEARCH REPORT 2018 13
Prof Monwabisi Ralarala and Prof Dina Burger congratulate Mr Rendani Mulaudzi and Ms Tabisa Ncubukezi
The year 2018 was a productive period for the Centre for Postgraduate Studies (CPGS). CPGS prides itself on supporting, developing and enhancing postgraduate studies at CPUT, in alignment with the institution’s commitment to promoting postgraduate education and continuing to grow its own postgraduate student cohort.
During 2018, 1 539 master’s students and 290 doctoral students were registered, and 11 postdoctoral fellows were hosted by CPUT. In addition, 23 students graduated with doctoral degrees, while 144 graduated with master’s degrees.
CPGS is responsible for these postgraduate areas:
• Directs, develops and administers all postgraduate education and research at CPUT
• Through established processes, offers a seamless service to registered postgraduate students
• Manages the administration of postgraduate students and administers the DST–NRF inter nship programme
• Manages NRF BTech student bursaries
From the Director: Centre for Postgraduate Studies (Acting) Prof Dina Burger


• Co-ordinates all the activities of the Higher Degrees Committee (HDC), inclusive of interaction with the faculty research co-ordinators in respect of HDC documents, preparation of HDC meeting agendas, and submission of HDC-approved documents to Senate
• Appoints post-doctoral fellows
• Oversees the academic involvement of post-doctoral fellows
The HDC is a committee of Senate and makes recommendations to Senate on matters relating to postgraduate studies and student progression. The administration of higher degrees is facilitated by our own customised HDC digital system, now in its sixth year of operation with over 2 000 users. The system is continuously monitored to ensure that we improve its functionality and it is currently being upgraded to include new functionality.
The centre organised several research development workshops and seminars during 2018, including proposal writing, research design and research methodology, statistical data analysis, article writing, and the use of plagiarism detection software (Turnitin). We are seeing an increasing number of postgraduate students and academic staff/supervisors participating in these opportunities. The centre also developed a comprehensive training and capacity development programme for CPUT’s postgraduate students to be implemented in 2019.
CPGS is strenuously committed to improving its services, and to supporting and assisting supervisors, postgraduate students and post-doctoral fellows. I look forward to being in a position to report on progress made in our next report. Last, but not least, I wish to thank the CPGS staff for their hard work during 2018.
2018 External Grants
RESEARCH REPORT 2018 14
NRF Freestanding BTech/Honours 600 000 NRF Innovation BTech/Honours 1 520 000 NRF NSFAS Block Grant 1 520 000 NRF Freestanding BTech/Honours (additional allocation) 300 000 NRF Innovation BTech/Honours (additional allocation) 900 000 NRF NSFAS Block Grants (additional allocation) 1 900 000 NRF Master’s Freestanding 1 100 000 DST NRF Master’s Scholarships 720 000 NRF Doctoral Freestanding 140 000 DST NRF Doctoral Innovation Scholarship 120 000 Mauerberger Foundation Master’s 650 000 Webb Trust 35 000
FROM THE DIRECTORS
Postgraduate research in the spotlight
held for the first time since 2014, the CPuT’s Postgraduate Conference took place at Saratec in November 2018. Master’s and doctoral candidates delivered presentations and presented posters on a host of subjects ranging from the use of electro-spun copper oxide nanofibres for non-enzymatic glucose detection to preliminary findings in a survey of old materials used in heritage buildings in the Mother City. The Food Science & Technology students made quite an impact with five master’s students presenting a mixture of research into the potential uses of the Bambara groundnut.

Acting director of the Centre for Postgraduate Studies, Prof Dina Burger, said when organising the event they did not have to cajole anyone into presenting their work, but were met with great enthusiasm. “The importance of a conference such as this is multifold. It gives students an opportunity to communicate their science to a broader constituency and in so doing, exposes them to feedback and critical engagement. They need these skills in the workplace and in life,” said Prof Burger.
Acting DVC: RTIP, Prof Marshall Sheldon, pointed out that 6.2% of the university’s current student enrolment comprised postgraduates, an increase from 5.5% in
2014. “We want to increase postgraduate enrolment by the year 2025 and we anticipate the numbers could double. That should increase our research output in terms of articles, conferences attended and papers delivered,” said Prof Sheldon. She acknowledged that challenges facing current postgraduate students were different from what she experienced as a student, but expressed her belief that the university’s support units were up to the task of helping students and their supervisors achieve their goals.
Ms Merlisa Kemp won best poster for her work on ‘ u lt rasound investigation of risk factors for extracranial vascular pathology in patients with multiple sclerosis’. Best presentation went to Mr Mohamed Rahman for ‘A performance and energy evaluation of a dye drawn forward osmoses (F) system for the textile industry’.
Mr Bwandakassy Cedrick Elenga Baningobera’s presentation, ‘Implementation of an IEC 61850 standard-based harmonic blocking scheme for a power transformer’, won him second best presentation, and Ms Sarah Kasangana Kapinga’s ‘Co 3O 4/TiO 2 heterojunction for heterogeneous activation of peroxymonosulfate for treatment of textile wastewater’ won third place.
RESEARCH REPORT 2018 15
Students from various faculties presented research at the Postgraduate Conference
FROM THE DIRECTORS
From the Director: Technology Transfer Office Dr Revel Iyer

In south Africa, as in other places in the world, universities are the originators of vast quantities of research. Ostensibly, this research has potential to make a difference in people’s lives. This change could happen via a number of ways. For example, consider new businesses being created leading to new jobs and growth of the gross domestic product (GDP). The availability of the technology to society could also bring about a positive increase in the quality of life. Thus the research that is being done in these institutions has potential value. Technology transfer is a process directed at unlocking this value by aiming to transform this research into a tangible output that impacts positively on society.
Technology transfer consequently seeks to bring about a cultural shift – a change in mind-set of the academic. Instead of doing research solely for the sake of publication, technology transfer shifts the goal posts and requires
that the development go further. To this end, Technology Transfer Offices (TTO) typically oversee the maturation of technologies from a concept, to a prototype, then a pilot demonstration, and finally a commercial product or service. In many instances the technology concept may fail along the development process. however, a few technologies do make it through.
This brings us to an important realisation – academic peer review has a lower threshold than the market. Often the inadequacies of the current academic research process are highlighted during the technology transfer process. A consequence is that the researchers who remain on this journey are those who want to improve the quality of their research and who are committed to doing research that is relevant to society.
Mandated by law in terms of the Intellectual Property Rights from Publicly Financed Research and
We are living in a time in which change is the predominant activity. Institutions like universities with a legacy of a few thousand years have to change and evolve in line with societal demands. This is not a challenge but an opportunity. Universities need to re-identify their role, purpose and responsibility in this new post-industrial society. In doing this, universities can be catalysts for the knowledge economy that we yearn for in the developing world. This change will lend us the ability to provide solutions for ourselves rather than being dependent on the developed world. Technology transfer is a mechanism for this. however, for technology transfer to succeed, there needs to be a willingness for people to change their way of thinking – a change of culture is needed.

RESEARCH REPORT 2018 16
iyerr@cput.ac.za
Development Act 51 of 2008 (IPR Act), the technology transfer process involves a researcher formally disclosing a technology typically at the concept stage. The personnel at the TTO are then required to undertake a critical assessment, which generally involves a technical and commercial assessment of the technology. If the technology has commercial potential, the next step is to assess whether the technology can be protected as a form of Intellectual Property (IP). In most cases the IP is in the form of patents, but other IP forms like designs, plant breeder’s rights and confidential information are also included.
unfortunately, IP does not develop or commercialise itself, so IP protection is merely a step in the process. In most cases it has to be developed further, often costing millions of rands in development work. The TTO oversees this process. Simultaneously, the TTO also actively markets the IP. The end point is an IP transaction either to an existing company or to a company that is created purely for the purpose of commercialising the technology.
The value for the researcher does not end there. Once proceeds are received from the IP transaction, the TTO is mandated to give a portion of that to the researcher in their personal capacity. In addition, another portion is distributed to the researcher’s research account, thus allowing them to do more research.
Technology transfer is alive and doing well at CP u T
During 2018, we created our first true spin-off company, Amaya Space, which is positioned to commercialise all of the space-related technologies emanating from CPuT. Our area of expertise is nanosatellites, especially in communication systems. We noted two things prior to creating the company. Firstly, there was global uptake of nanosatellite subsystems in real sales. Secondly, we observed that the South African space sector was not transformed and further it was not absorbing
Prioritising patents and intellectual property
Director of the Technology Transfer Office, Dr Revel Iyer, was one of the speakers at the World of Academy Sciences (TWAS) Research Grants conference, held in Tanzania. The theme of the conference, which took place in Dar es Salaam at the end of August, was ‘Building skills for science in Africa’.

Dr Iyer spoke on the topic of ‘Patents and intellectual property’ (IP). he said his main takeaway from the conference was that African research is aligned with South African research. “Researchers are open to partnerships and collaboration with us,” he said. “They are also looking to us to transfer skills. We should become more relevant in this space.”
Dr Iyer said it appeared to be a global problem that academic scientists were not very familiar with IP. “IP is mainly considered an aspect of the commercial world and has traditionally been treated as something that cannot coexist with academic research,” he said. “The success of the American system has challenged this mind-set. The knowledge economy in the uSA blossomed after implementation of the Bayh–Dole Act. A number of countries are now implementing Bayh–Dole Actlike legislation. An example is South Africa.”
RESEARCH REPORT 2018 17
Dr Revel Iyer spoke at a conference in Tanzania
Technology transfer is a process directed at unlocking this value by aiming to transform this research into a tangible output that impacts positively on society
CPUT reaches new heights with space company launch
Already established as a regional leader in the field of nanosatellites, a new company, Amaya Space, has been set up by CPuT, and will help launch the institution to even greater heights.

In 2013, CPuT made history with the launch of ZACube-1, South Africa’s and Africa’s first nanosatellite. ZACube-2, the most advanced South African CubeSat to date, was launched in December 2018. Radio systems and other technologies developed at CPuT are also used in many satellites from around the world.

Now the university has taken the next step by setting up a company aiming to be the first truly transformed space company, by Africans for Africans. CPuT’s TTO is a key enabler of this initiative. Director, Dr Revel Iyer, said it was critical for South Africa and the continent that a strong, Africanborn nanosatellite company emerged. South Africa has a couple of nanosatellite industry players. “however, these companies are generally not truly transformed and representative of our nation’s demographics as none of them are being run by black South Africans; none of them focus on
employing young black South African engineering graduates; and none of them are well positioned to be the preferred supplier for South African government. This company will furthermore aim to catalyse a transformational supplier development programme.”
“We have a collective body of knowledge – intellectual property – that we have created within CPuT which we are mandated to commercialise,” said Prof Robert van Zyl, director of F’SATI at CPuT. “We want to respond to national directives like government’s Operation Phakisa. Nanosatellite solutions can provide services to support Operation Phakisa, for example in the maritime domain.”
The company will deliver fully functional CubeSat constellations primarily to the South African government as well as governments elsewhere on the African continent, while striving to serve a role in the building and transformation of the emerging space industry.
“CPuT has been successful, at academic and research levels, to give opportunities to previously disadvantaged students. We also employ them in our Africa Space Innovation Centre as engineers-
in-training. The expectation is that they will feed into and drive the company, and indeed the whole industry,” Prof Van Zyl said. “CPuT continues to play a pivotal role in the research, innovation and commercial development of the South African and African space industries,” he added. “This puts us in quite a unique situation for already having established this complete value chain in a new, technologically disruptive industry. By having a vibrant industry that can take up research, it will catalyse further research within the university and conversely, that will translate into more competitive products and services for the industry.”
The CPuT Satellite Programme is hosted by F’SATI, and is strategically supported by the South African government through the Department of Science and Technology, the SA National Space Agency, the National Research Foundation and development finance institutions. Key industry partners include Stone Three and Etse Electronics in South Africa, and Clyde Space in Scotland.
RESEARCH REPORT 2018 18
CPuT has launched Amaya Space
any of our highly qualified space engineers. The solution was simple. We had the technology, the expertise and the will to enter the space sector, hence Amaya Space was born. Our IP portfolio in space communication systems has now burgeoned into eight separate IPRs. In addition, we have recently launched the most advanced nanosatellite developed in Africa. Beyond transforming the industry, Amaya Space is designed to be a catalyst for the sector in South Africa. Our other components are sourced from other South African companies. The hope is that this collaborative spirit will help grow the entire sector.
Another success at CPuT is our Bambara technology portfolio. This was widely showcased during 2018 with significant interest from investors. The Bambara groundnut, or round bean, is widespread in Africa, where it is known by various names. It has potential as
a cash crop, owing to its nutritional composition, functional properties and antioxidant potential.
Consequently, we at CPuT have used the Bambara groundnut as a raw material to create several value-added products.


These include dairy substitutes, baked goods, meat substitutes and beverages. These products are gluten-, lactose- and cholesterolfree.
Among the benefits of this range are that it:
• Lowers cholesterol
• Stabilises blood glucose levels
• Acts as an effective detox aid
This groundnut is able to grow under drought conditions. This offers a great opportunity to South African farmers as the Bambara groundnut is less risky to grow with a lead time of merely four to five months.
There is a growing consciousness of and demand for healthier diets. Furthermore, the cases of lactose intolerance are growing. This has created an opportunity that we believe the Bambara groundnut can fulfil. This is a high-margin market that can lead to better returns.
CPuT wants to create a manufacturing business, vertically integrating with other sectors in the country. Phase 1 of this business would be to create a manufacturing facility in South Africa. This will allow us to supply the local market, as well as to export products to the UK and USA in the medium-term. Phase 2 would be to set-up a manufacturing plant in India, which would allow access to the Asian market.
Amongst other media, a flyer was developed to promote the range of Bambara products and their benefits. These products include Bambarasourced substitutes for everything from milk to tofu to cake and more.
RESEARCH REPORT 2018 19
BamFlour-mix BamMilk
BamPie BamCrackers
BamBrownie BamChilli-bite
BamPro BamChips BamCake BamBiscuit
BamTofu
A non-dairy on-the-go beverage A gluten free baking flour A crispy tortilla style chip made from Bambara groundnut flour fortified with pea & hemp protein
A cheese-like product made from Bambara groundnut flour
A pastry-like product made from Bambara groundnut flour, can be served as a starter or a snack A gluten and lactose free dessert
A thin, crisp biscuit made from Bambara groundnut flour Available in various flavours
A pastry product made from Bambara groundnut flour
An on-the-go beverage made from cultured BamMilk
A shortbread biscuit made from Bambara groundnut flour
A cake-like product made from BamFlour suitable for the vegan market
Gluten free Cholesterol free Lactose free Low in fatRich in proteinRich in fibre
Rich
in antioxidants
Added
probiotics for maintaining colon wellness
Source of Omega 3 and 6 fatty acids
Reduced sugar
From the Director of Rti Strategic initiatives & Partnerships (Rti-SiP) Prof René Pellissier
Strategic Initiatives & Partnerships is hosted in the office of the DVC: Research, Technology, Innovation & Partnerships and provides the overarching vehicle through which the CPUT vision is translated into research outcomes. The office supports and implements the Research Technology & Innovation (RTI) Blueprint that informs all research activities at CPUT, and develops national and international initiatives through which CPUT engagement and uptake are undertaken. The portfolio deals with all strategic initiatives at CPUT nationally and internationally, and therefore includes design and implementation of the CPUT Vision 2030, the ensuing redesign of the components of the RTI Blueprint, and CPUT’s internationalisation efforts.
The CPUT unique research uptake model

CPUT research involves responding to the needs of society and follows a cradle-to-cradle approach. As a university of technology, CPUT follows a value chain approach leading from research to technology to innovation in the form of research uptake. This is derived from our research outputs, i.e. research uptake focuses on the use of and usefulness of research to the environment, including support and development of technological innovations through our Technology Transfer Office. Indeed, the CPUT research uptake initiative is a distinct feature of the university’s research base as an outcome of the RTI Blueprint where research at CPUT is applicationsbased. Examples of CPUT innovations are legion.
One of the ways in which uptake can be achieved, is the hosting of public lectures, an activity that draws upon the richness of our national and international partner expertise. During 2018, CPUT, through our strategic Impala partnership, hosted three workshops/public lectures focusing on decolonisation with internationally celebrated experts addressing various problem areas.
The RTI Blueprint
The CPUT RTI Blueprint was designed to support the CPUT Vision 2020 through unlocking the potential of staff, students and partners in order to excel in research, technology and innovation that offer solutions to the needs of society. The key principles to achieve this were identified as: (1) Excellence, i.e. the development of cutting-edge facilities, RTI capabilities and outputs that gain recognition nationally and internationally; (2) Following a multidisciplinary approach in order to cultivate versatility of thinking and place an emphasis on integrated problem-solving; (3) Unlocking potential by creating an environment that catalyses our potential; (4) Strategic collaboration in order to build meaningful, well-functioning and focused partnerships with communities, industry, government, research institutions and other universities (locally and internationally), to ensure the relevance of research and uptake of solutions in practice; (5) Efforts to produce tangible

RESEARCH REPORT 2018 20
FROM t HE D i REC t ORS
As a university of technology, CPUT follows a value chain approach leading from research to technology to innovation in the form of research uptake
benefits to key social and economic challenges through service and research uptake and the fostering of a culture of RTI practice.
The research focus areas as main driver for RTI
In its RTI Blueprint, CPuT identified the main drivers for research. Firstly, and most importantly, through the blueprint, research areas and research niche areas allow for specialisation and support in a managed environment while not excluding new areas of research. The focus areas provide the bridge between what is teachable and what is on the periphery of our science as a university of technology. The current focus area are: Bio-Economy & Biotechnology, Space Science & Technology, Energy, Climate Change & Environment, human & Social Dynamics, Economic Growth & International Competitiveness, and Design for Sustainability. The niche areas are in support of these primary focus areas and each focus area and niche area has a leader guiding its work. however, during 2018, these areas were re-evaluated in line with the CPuT new vision of human-centricity and technologyenabledness. W ith a growing need to address the Fourth Industrial Revolution and the Smart Society, a new set of focus areas and subsequent research niche areas are in process for 2019 – refer to Table 1.
The Research Chair initiative as driver for RTI
Secondly, the RTI Blueprint supports the expansion of the Research Chair initiative in the office of the DVC: Research, Technology, Innovation & Partnerships. Research Chairs are financed through the DST/ NRF, CPuT itself as funder, or outside funding, for example the SETAs. The Research Chairs are supported by, and in turn support the research work undertaken by CPuT’s seven research focus areas.
All Research Chairs, no matter the funding source, operate under the framework provided by the NRF. Furthermore, efforts are under way to ensure that each Research Chair is linked to a focus area – refer to Table 2.
CP u T’s RTI and the q uadruple helix system of strategic partnerships
Following the quadruple helix innovation ecosystem, strategic partnerships provide a mechanism to achieve relevance and excellence through RTI for CPuT. On top of the strong emphasis on research uptake, CPuT’s research follows the quadruple helix principles of linking government, businesses, universities and people into one expanded ecosystem of open innovation-related activities and outcomes. This follows from the value CPuT places on its national and international partners, including individuals, industry, government and higher education entities. Our national partnerships include those with government and the work we do with these government entities, our liaison with the South African Technology Network (SATN), the Cape higher Education Consortium (ChEC), the National Research Foundation (NRF), and others.
CP u T’s strategic i nternationalisation
CPuT has always prided itself on the extent and contribution of its internationalisation as strategic initiative in support of the RTB Blueprint and the Vision 2020. Our strategic internationalisation involves the value of internationalisation in respect of: (1) Mobilities of staff and students outbound and the welcoming of international students and staff inbound, (2) Research collaboration, and (3) Policy development.
Current trends seem to indicate that most CPuT international
students originate from African countries, mainly the Democratic Republic of Congo, while we host exchange students and faculty from our European, North American and Asian partners, the primary associates being Germany, France, Sweden and Norway.
Through the Erasmus+ mobility programmes, faculty and students have an opportunity to complete qualifications internationally, while we continue to expand our research partnerships to include BRICS members, as well as Japan and South Korea. Indeed, over the last five years, CP u T has participated in several Erasmus+ funded mobility projects. The participation was influenced by the need for staff and students to complete their master’s and PhDs and to build strong partnerships that will increase our own understanding and build on that of our partners. CP u T mo bility projects are co-ordinated by various institutions in Europe and in countries like Belgium, Germany, Spain, Sweden, France, etc., covering a large span of subject fields and entities. The projects further introduce a reciprocal component, which allows European staff and students to visit to South Africa. It provides a platform for our students to interact with exchange students and for staff to engage and share best practices.
When Erasmus+ was introduced, CPuT collaborated with the universities of Antwerp, Limpopo, Venda and Fort hare for a training programme, the Internationalisation and Modernisation Programme for International academics, leaders and administrators (Impala) that focuses on four streams (Mobility Toolkit, Summer Schools, Project Writing and Internationalisation of the Curriculum), designed to build administrative, academic and research capacity in the partner institutions. The programme ended in 2018 and plans are underway to roll out similar programmes, and knowledge gained, at CPuT.
RESEARCH REPORT 2018 21
CPuT participates in several other Erasmus-funded capacity programmes. These include the YEBO! Programme focusing on Internationalisation of the PhD and its capacity requirements, the SASuF (Swedish) collaboration deploying the fundamentals
of the 17 Sustainable Development Goals, and SANORD, the Nordic country alliance. In October, CPuT launched its first Collaborative Online Interactive (COIL) venue, thus providing CPuT with cutting edge technology in support of
1 Bio-Economy & Biotechnology Prof J Mar newick Prof J Marnewick (CPuT) Prof W Gelderblom (CPuT)
interactive academic and research work. Refer to Figure 1 for CPuT’s comprehensive internationalisation framework.
Work is underway to develop the Smart Internationalisation Strategy for CPuT in line with Vision 2030.
Agrifood Technology Station (ATS)
Bioresource Engineering Research Group
Environmental Chemistry, Toxicology & Remediation
Functional Foods Research unit (FFRu)
Institute of Biomedical & Microbial Biotechnology (IBMB)
2 Space Science & Technology Prof R van Zyl In progress
3 Energy Prof R Tzoneva In progress
French–South African Technology Institute (F’SATI)
Africa Space Innovation Centre (ASIC)
Centre for Instrumentation Research (CIR)
Energy Institute
Centre for Computational & Applied Technology Mechanics (CCATM)
Centre for Distributed Power & Electronic Systems (CDPES)
Centre for Mechanics & Technology (CMT)
Centre for Real-Time Distributed Systems (CRTDS)
Centre for Substation Automation & Energy Management Systems (CSAEMS)
4 Climate Change & Environment Prof B Opeolu Prof K Findlay (CPUT) Centre for Sustainable Oceans & Coasts
Centre for Water Supply & Sanitation Research (CWSR)
Crystal Engineering unit
Radiochemistry and Ion Exchange Chromatography
5 human & Social Dynamics Prof J Condy Prof R Chetty (CPuT) Prof T Matsha (SARChI) Prof N Nduna (ETDP SETA)
Prof Y Sayed (SARChI) Prof C Winberg (SARChI)
Centre for International Teacher Education (CITE)
human Performance Laboratory
Literacy Development and Poverty
Work-Integrated Learning (WIL)
Work-Integrated Learning in TVET Colleges
Professional Education Research Institute (PERI)
6 Economic Growth & International Competitiveness
Dr h Ballard Prof R Mason (WRSETA)Adaptronics AMTL
Clothing and Textiles Technology Station (TSCT)
Flow Process and Rheology Centre (FPRC)
Nanomaterials Group
Website Attributes Research Centre (WARC)
Wholesale & Retail Leadership
7 Design for Sustainability Prof E Ruhode Prof T Thurner (CPuT) Innovation in Society
Product Lifecycle Management Competency Centre (PLMCC)
RESEARCH REPORT 2018 22
FOCUs AReAs FOCUs AReA LeADeR ReseARCh ChAIR ReseARCh eNTITIes
Table 1: Research Focus Areas, Research Chairs and corresponding Research entities mapping
South African Research Chair Initiative (SARChI)
Work-Integrated Learning Prof C Winberg (Tier 1)
Teacher Education Prof Y Sayed (Tier 1)
Cardiometabolic health
Innovative Small Satellite Technology and Applications for Africa (ISSTA)
CPUT-funded Research Chairs
Prof T Matsha (Tier 2)
In progress
Biotechnology Prof J Marnewick
Oceans Economy Prof K Findlay
Innovation in Society (Service Design)
Energy
Literacy Development
Events, Tourism, Legacies & Sustainability
Other-funded Research Chairs
Wholesale & Retail Leadership (SETA)
Work-Integrated Learning (SETA)
Strategic collaboration for capacity development COIL, YEBO!, IMPALA,SASUF, SANORD, PAU, other internationalisation of the curriculum
Prof T Thurner
In progress
In progress
In progress
Prof R Mason
Prof J Nduna
Internationalisation at home Internationalisation, Africanisation and transformation of the curriculum, integration of international and local students, presence of international students and staff
Academic mobility for staff and students
Completion of Masters and Doctoral degrees
Global understanding
CPuT is at the peak of its strength as a university of technology. Not only do we have the knowledge of teaching in a practical space, but we also understand the world of technology through technological innovation and technology
Institutional collaboration
Bilateral institutional linkages, partnerships and strategic alliances. Multilateral institutional networks, capacity building consortia, research collaboration.
Internationalisation abroad
Students and staff exchanges, degree mobility, joint/co-badged degrees, international conference attendances, cross-border delivery (e.g. branch campuses).
adoption, which is so vital in a rapidly changing world of work as encapsulated by the Fourth Industrial Revolution.
Research policy development value Agreements and collaborations
Must facilitate initiatives to attract SA and African scholars
RESEARCH REPORT 2018 23
ChAIR TITLe ReseARCh ChAIR
Table 2: Research Chairs (2018)
Figure 2: Using comprehensive internationalisation for research and academic relevance and excellence
CPUT RESEARCH AwARDS
Celebrating research excellence
From publishing research papers to embarking on innovative studies, CPUT researchers have once again made the institution proud during 2018. The university planned to celebrate their admirable efforts at an annual Research Day this year. The event has been postponed to April 2019, but we acknowledge and congratulate the following top researchers in the meantime:
RESEARCH DAy 2018 AwARDS (for research activities during 2017)
Research Publication
AWARDRECIPIENT FACULTY
Platinum Prof B Sun Engineering & the Built Environment
Gold Dr O Koopman Education
Gold Assoc Prof LJ Theo Informatics & Design

Silver Prof CG Iwu Business & Management Sciences
Bronze Dr RK Tengeh Business & Management Sciences
Postgraduate Supervision
AWARDRECIPIENT FACULTy
Platinum Prof RP Chetty Education
Gold Prof SKO Ntwampe Applied Sciences
Silver Dr RK Tengeh Business & Management Sciences
Industry Funding
AWARDRECIPIENT FACULTy
Platinum Prof T Matsha Health & Wellness Sciences
Gold Prof VG Fester Engineering & the Built Environment
Silver Prof R Tzoneva Engineering & the Built Environment
Bronze Prof I Masalova Engineering & the Built Environment
RESEARCH REPORT 2018 24
DEPARTMENT OF HIGHER EDUCATION AND TRAINING (DHET) PUBLICATIONS AUDIT
C P u T journal research units for 2018

RESEARCH REPORT 2018 25
PUBLICATIONs COUNT FOR 2018 (sUBmITTeD TO The DheT IN 2019) uNITS Journal articles (audited) 163.36 Books (submitted) 9.00 Chapters in books (submitted) 23.91 Conference proceedings (submitted) 51.43 Total 247.70 FACULTy/SUPPORT UNIT/RESEARCH INSTITUTE BOOKS ChAPTERS CONFERENCES JOuRNALS TOTAL Applied Sciences 4.67 6.73 17.1728.57 Business & Management Sciences 3.15 7.8641.1552.16 Education 7.003.74 6.9220.3237.98 Engineering & the Built Environment 4.81 22.3423.2350.38 health & Wellness Sciences 0.56 0.0812.5913.23 Informatics & Design 3.96 5.4122.7032.07 Centre for Water & Sanitation Research 0.59 2.503.09 Community Engagement & Work-Integrated Learning 1.34 1.34 CPuT Libraries 4.00 4.00 Disability unit 1.00 1.00 Centre for Innovative Educational Technology 2.001.42 0.622.496.53 Executive Management 0.090.09 Fundani ChED 1.00 0.17 7.518.68 Institute of Biomedical & Microbial Biotechnology 0.207.818.01 Student Counselling 0.330.33 AS 11% BMS 25% EDU 12% ENG 14% H&WS 8% I&D 14% Non-Faculty 16% Chart Title AS BMS EDU ENG H&WS I&D Non-Faculty
NATIONAL RESEARCH FOUNDATION (NRF) RATING
The National Research Foundation is a national agency for research support and promotion. In addition to funding, human resource development and the provision of research facilities, the NRF annually invites researchers in all academic fields to apply for individual ratings.
NRF-rated researchers in 2018
RESEARCH FUNDING
RESEARCH REPORT 2018 26
RESEARCHER FACULTY/sUPPORT UNIT/ReseARCh INsTITUTe RATING Dr NB Báthori Applied Sciences Y2 Prof OS Fatoki Applied Sciences C2 Prof KP Findlay Applied Sciences C3 Prof A Jacobs Applied Sciences C3 Prof VA JideaniApplied Sciences C3 Prof L Kambizi Applied Sciences C3 Prof CP LaubscherApplied Sciences C3 Prof FB Lewu Applied Sciences C3 Prof AA MohammedApplied Sciences C3 Dr VS SomersetApplied Sciences C3 Prof SEh Davies Business & Management Sciences C3 Prof V Naicker Business & Management Sciences C3 Prof RB MasonBusiness & Management Sciences C3 Dr MS Taliep Business & Management Sciences Y2 Prof M McPhersonCentre for Postgraduate Studies C3 Dr I van Zyl Centre for Innovative Educational TechnologyY2 Prof R Chetty Education C1 Dr A Chigona Education C2 Prof J Condy Education C2 Prof C WinbergEducation C2 Dr A Patnaik Engineering & the Built Environment C2 Prof K Barris Engineering & the Built Environment C3 Prof VG Fester Engineering & the Built Environment C3 Prof TV Ojumu Engineering & the Built Environment C3 Prof MS SheldonEngineering & the Built Environment C2 Prof J GarrawayFundani ChED C3 Prof JL Marnewick health & Wellness Sciences C1 Prof T Matsha health & Wellness Sciences C1 Prof OO Oguntibeju health & Wellness Sciences C3 Prof K Jooste health & Wellness Sciences C2 Prof J Cronjé Informatics & Design C1 Prof M WeidemanInformatics & Design C3 Dr S Abel Institute of Biomedical & Microbial BiotechnologyC2 Prof WCA GelderblomInstitute of Biomedical & Microbial BiotechnologyB1 Dr GS ShephardInstitute of Biomedical & Microbial BiotechnologyB1 Dr L van der WesthuizenInstitute of Biomedical & Microbial BiotechnologyC2 Cape higher Education Consortium (ChEC) 153 924 DhET university Capacity Development Grant (uCDG)* 23 241 000 Department Of Science & Technology (DST) 27 680 000 Industry Funding 10 426 880 GhENT university Grant 358 432 National Research Foundation (NRF) 19 087 901 New Generation Of Academics Programme (nGap) 10 000 000 Postgraduate Students External Bursaries 9 505 000 Research Technology and Innovation (RTI) - CPuT Chairs 4 500 000 Research Technology and Innovation (RTI) - CPuT Prestigious Project 3 000 000 Technology Innovation Agency (TIA) 6 281 419 * Conference Funding (ConfCom), Research Exchange Programme (REP) and University Research Funding (URF) are three of the UCDG’S sub-projects A Leading international researcher
Internationally acclaimed researcher
Established researcher
Prestigious awards
Promising young researcher The NRF rating categories
B
C
P
y
Deans’ Reports
Faculty of Applied s ci ences
Faculty of Business & m an agement s ci ence
Faculty of e du cation
Faculty of e ng ineering & The Built e nv ironment
Faculty of h ea lth & Wellness s ci ences
Faculty of Informatics & Design

RESEARCH REPORT 2018 27
Dean’s Report Prof Olalekan Fatoki

The Faculty of Applied sciences continues to live its vision of being the faculty of choice in science and technology both nationally and in Africa as a whole. This is in line with the university’s vision ‘to be at the heart of technology education in Africa’.
In 2018, the faculty continued to show commitment to goals set over the previous two years, i.e. creating and continuing to improve an enabling environment for research, innovation and postgraduate education. More specifically, the faculty aims to:
1. Promote research and innovation culture and increase the research output of academic staff
2. Increase the number of graduate students, particularly doctoral students, and to substantially increase their graduation rate
3. Improve the profile of faculty staff and their capacity to engage in meaningful research
4. Increase number of research linkages and partnerships locally, regionally and internationally, especially in Africa
Faculty academics also attracted substantial external research funding during the year, e.g. from various agencies such as the Cape higher Education Consortium (ChEC), the Water Research Commission (WRC) and the National Research Foundation (NRF).
A good number of postgraduate students graduated out of the faculty this year. There were 26 master’s, which is an increase from the 19 who graduated in 2017, and three doctoral, which is the same number as last year.
The faculty has 56% of permanent staff with doctoral degrees and more are working towards their PhDs as part of our staff development programme. One of the faculty’s proudest moments was when four of our staff members were promoted to associate professorship and two
were promoted to full professorship, adding to the expertise needed in various fields of research.
The faculty has 12 NRF-rated researchers, which is the highest number of rated researchers currently hosted by any faculty in the university.
The faculty supports its research niche areas and they continue to grow:

(i) Bio-resource Engineering
(ii) Crystal Engineering
(iii) Radiochemistry and Separation Science
(iv) Food Security (including nutrient security)
(v) Environmental Chemistry and Toxicology
The CPuT Research Chair: Oceans Economy and the associated proposed Centre for Sustainable Development have developed significant traction for the university in both the ocean governance and ocean economies arenas in the Southern African marine research space.
The faculty contributed to the university’s World Environment Day event with series of activities including a symposium on Plastic Pollution with Prof Jonathan Okonkwo of Tshwane university of Technology (TuT) and Prof Augustine Arukwe, from Norway participating. There was also a Clean-up Campaign around the District Six area to promote environmental awareness.
The Functional Food Research unit continued to shine. The Omega 3 Caro-E product is available in many pharmacies and supermarkets in
FAC u LTY OF APPLIED SCIENCES R ESEARCH REPORT 2018 28 FAC u LTY OF APPLIED SCIENCES
One of the faculty’s proudest moments was when four of our staff members were promoted to associate professorship and two were promoted to full professorship, adding to the expertise needed in various fields of research
Faculty of Applied Sciences
South Africa. The product has also been approved for sale in Canada.
Several new local, regional and internationally linkages were established 2018 and the faculty continued to be active in the u6 Consortium. CPuT hosted the u6 International Conference in September, and our faculty played a significant role in the organisation and the success of the conference. The main conference took place at the District Six Campus, where Ghana, Kenya, Nigeria, Gambia and South Africa were represented by approximately 125 delegates. These delegates were joined by invited plenary and keynote speakers from the Netherlands and India. This conference also offered an opportunity for postgraduate students to interact with international experts. In addition, most of our staff members also attended many local and international conferences where they participated as keynote speakers and/or presenters of their research in the form of talks and posters.
I would like to take this opportunity to thank all the staff and students for their commitment, energy and dedication in making the year 2018 a success.
Funding
Research output
Please note that more information about this faculty’s research activities for 2018 can be found in the Focus Areas section of the Research Report:
RESEARCH REPORT 2018 29
Cape higher Education Consortium (ChEC)65 156 Conference funding (ConfCom) 334 354 Department Of Science & Technology (DST)680 000 Industry funding 1 812 000 National Research Foundation (NRF) 3 649 696 Research Exchange Programme (REP) 56 738 Technology Innovation Agency (TIA) 978 906 university Research Fund (uRF) 267 426 Total 7 844 276
2018 PuBLICATIONS (SuBMITTED TO ThE DhET IN MAY 2019) uNITS Chapters in books (submitted) 4.67 Conference proceedings (submitted) 6.73 Journal articles (audited) 17.17 Total 28.57 FOCUS AREA 1 Bio Economy & Biotechnology Technology Station: Agrifood Technology Station 80 Research Group: Bioresource Engineering Research Group 82 Research Unit: Functional Foods Research unit 87 Research Niche Area: Environmental Chemistry, Toxicology & Remediation 86 FOCUS AREA 4 Climate Change & Environment Research Chair: Oceans Economy 113 Research Entities: Crystal Engineering unit 117 Radiochemistry and Ion Exchange Chromatography 118
New professors
Thirst Buster
CPuT Brewing has done it again, winning the Best Lager award in the 2018 SAB Intervarsity Beer Brewing Competition. The competition was organised by Central university of Technology and the university of the Free State together with South African Breweries. The 14 teams competed in four categories – Lager, Belgian Ale, Fruit Beer and Winter Warmer. A panel from the greater brewing industry, SAB and Warthogs Brewers Association judged the entries.
The CPuT brewing team of three Food Science and Technology BTech students created a lager, which they called Thirst Buster, and beat the rest despite brewing not having been extensively covered in their curriculum. “They are true ambassadors for the Department,” said their very proud supervisor, Dr Zanephyn Keyser. “We went with a Munich dunkel and formulated the recipe approximately a month and a half before the competition, which allowed us to condition the beer in the bottle for three weeks… We created a refreshing beer with a deep copper colour, a red tint and a creamy tan head. Our clean fermentation created a well-balanced aroma, rich, elegant, deep malt sweetness, with a floral, hop flavour thanks to our unique Saccharomyces yeast strain.”
The CPuT brewing team made their debut at the Intervarsity Beer Brewing Competition in 2013, and the following year they used rooibos extract as a key ingredient, winning the Ben Lamaletie IBD Intervarsity Beer Brewing Challenge Floating Trophy, the top honour Castle Lager Best Bru Award and the Carling Black Label Champion Lager. In 2015, they won Best Speciality Brew (Tipsy Inyanga), in 2016 they won Best Label, and in 2017, their Apple Adventure won Best Cider.
Dr Keyser said he hoped their winning streak would attract attention from the local craft brewing industry who might require laboratory analysis or recipe development to further improve their own products.







FAC u LTY OF APPLIED SCIENCES RESEARCH REPORT 2018 30
Faculty of Applied Sciences
Dr Zanephyn Keyser and his successful team of beer brewing students
Prof Francis Lewu Agriculture
Prof Beatrice Opeolu Climate Change and Environment
Assoc Prof Merrill Wicht Crystal Engineering
Assoc Prof Muhammad Nakhooda Biotechnology and Consumer Science
Assoc Prof Lalini Reddy Chemistry
Assoc Prof Sjirk Geerts Conservation and Marine Science
Academic visits Brisbane and Nsukka

Dr Vincent Okudoh, senior lecturer and WIL Co-ordinator: Biotechnology, attended the Bioenergy Australia Conference in Queensland, in October as both a panellist and speaker. The conference was titled ‘Bioenergy Strong 2018 – Driving Commercial Outcomes’ and was held at the State Library of Brisbane.

Dr Okudoh also visited the university of Nigeria in Nsukka in NovemberDecember. This visit was the result of a grant for African interaction and collaboration, funded by Knowledge, Interchange and Collaboration (KIC).


The purpose of the KIC funding instrument is to contribute to these objectives:
- Internationalising South Africa’s research platform
- Enhancing networking within the global science system


- Fostering collaboration in order to improve the quality of research outputs by researchers
Pitch Perfect
A BTech Consumer Science student was rewarded with a trip to London at the end of 2018, after he delivered an impressive pitch at the SA Technology Network student pre-conference workshop. Mr Keagan Canterbury said the innovation he pitched focused on the development of a functional dairy-based product containing omega-3 fatty acids and carotenes. It was announced as the Best Student Pitch at the workshop, which was hosted by the Technology Innovation Agency.


“My specific product is a yoghurt-based honey mustard salad dressing that I developed for my Food Science 4 product development assignment. My supervisors are Prof Maretha Opperman and Mrs Enid hinrichsen,” said Mr Canterbury, who is also a teaching assistant in the Consumer Science Department.
During his visit to London, Mr Canterbury worked with and learnt from Mr Sherwyn Pillay of hypergrowth-Buzz. The company specialises in consulting with small businesses to help them develop into larger corporations in a short space of time.
RESEARCH REPORT 2018 31
In Brisbane, Queensland, Australia As a panelist, answering questions on Biogas
At the Bioenergy Australia Conference
Dr Chukwudi Onwosi, Dr Nneka Okafor, Dr Vincent Okudoh and Prof Sabinus Eze (Dean of the uNN’s Faculty of Biological Sciences)
With collaborator Dr Onwosi in Nigeria
Speaking at Bioenergy Australia
In Nsukka with uNN postgrad students
Mr Keagan Canterbury delivered the best pitch at the SATN student pre-conference
Dean’s Report Prof Paul Green

Introduction
The year started with the injection of new blood in faculty management. Prof Paul Green arrived from Durban university of Technology to take the mantle of leadership, following the absence of a Dean for almost three years. Prof Chux Gervase Iwu assumed the position of Acting Assistant Dean: Research, after the resignation and departure of Prof Godfrey Netswera in October 2017.

For the first time in the history of the faculty, two postdoctoral fellows were appointed. Further, the popular Bachelor of Technology Conference was held after several years of dormancy. The postgraduate student support programme was intensified to increase throughput, while staff development picked up pace to increase the pool of researchers in the faculty.
Research centres
Human Performance Laboratory (HPL)
The human Performance Laboratory continues to provide a space for the Department of Sport Management to pursue research and enhance student education and technical training in relation to performance in sport and related activities. Its function can be divided into the following inter-related components:
• Teaching and lear ning
• Research, including interdisciplinary collaborative research
• Facilitation of postgraduate supervision
• Exercise testing and rehabilitation
• Community engagement
Please see p130 for more information about this laboratory’s research related activities during 2018.
Centre for Tourism Research in Africa (CETRA)
CETRA is the research hub for tourism-related research based in
the Tourism Department. CETRA works in collaboration with three departments within the School of Events, Tourism & hospitality: Sport Management, Tourism & Events Management and hospitality Management. Its mandate is to highlight CPuT’s contribution to tourism and hospitality teaching and research in Cape Town, the Western Cape, South Africa and internationally. In addition, it facilitates research activities in the tourism, hospitality, sport and events fields. It aims to bring together university researchers and practitioners domestically and internationally in order to find feasible answers to applied research questions. CETRA is also mandated to encourage focused research clusters incorporating researchers and students from different CPuT departments and from outside the university. Some of CETRA’s research endeavours for the year are outlined on p129 of this report.
Faculty ethics committee report
The Faculty Research Ethics Committee (FREC), chaired by Dr Michael Twum-Darko, sits six times a year in order to facilitate the work of the faculty’s and institution’s higher Degrees Committees. In all, 125 applications (9.65% higher than 2017) were submitted to and reviewed by the committee for ethics clearance (110 for postgraduate students, 14 for special projects and one for external projects). Of the 110 postgraduate students’ applications, 96 (about 87%) were approved. The figure is 28% higher than 2017 and 42% higher than 2016, which illustrates much improvement in the quality of postgraduate research proposals and supervision in the faculty. The 2018 figure also demonstrates the committee’s contribution in approving research proposals and supervision in the faculty through its review comments to students and supervisors.
FAC u LTY OF B u SI NESS & MANAGEMENT SCIENCES RESEARCH REPORT 2018 32 Faculty of Business & Management Sciences
Internationalisation within the Faculty of Business & management sciences continues to thrive, with tangible benefits for all stakeholders
Faculty conference report
International Conference on Business and Management Dynamics (ICBMD)
ICBMD was established as a means to revive the Journal of Business and Management Dynamics, run by the faculty, which stopped publication after 2009 because of lack of articles and faculty support. In 2015, the conference was jointly organised by CPuT and the university of Namibia as the Inter national Conference on Business and Finance (ICBF). Since then, it has been renamed ICBMD and has been successful in its mandate, with conference proceedings published from 2015, 2016 and 2018. Since 2015, an average total profit of R1 571 972 has been generated from delegates’ conference fees as follows: 2015 – R250 563; 2016 – R709 243; 2017 – R490 166; and 2018 –R122 000.
CPuT co-hosted the ICBMD 2018 with the university of Namibia, the university of Fort hare and NorthWest university. The theme was ‘Managing business competitiveness in times of glocalisation’. After a rigorous process of double-blind peer-review by its scientific committee, the conference brought together a good number of attendees from Africa, Asia and Europe. Of 78 abstracts received, 55 (72%) were accepted. A total of 34 full technical papers were received and reviewed, of which 17 (50%) were accepted.
The guest speaker was Prof Edith Vries, DirectorGeneral of the Department of Small Business Development, South Africa. Dr Sharron McPherson, Co-founder of the Centre for Destructive Technologies and Singularity at unisa, was the first keynote speaker, while Mr Tim harris, CEO of WESGRO, the Official Tourism, Trade & Investment Promotion Agency for Cape Town and the Western Cape, was the second keynote speaker.
All good quality papers presented at the conference were published as conference proceedings in line with DhET subsidy directives, which require at most 30% of the papers to come from the host university. The ICBMD 2018 proceedings have 78% of the papers emanating from universities other than CPuT.
The success of ICBMD-2018 can be attributed to a combination of the hard work of its three committee members and reliable reviewers across the globe. A faculty-wide conference committee has been established with the Assistant Dean: Research & Innovation (Acting) as its chairperson. The new committee will own ICBMD, make strategic and operational decisions, and provide annual financial support from the faculty’s research funds.
Postgraduate qualifications
A total of 47 postgraduate students were awarded degrees, consisting of one doctorate and ten master’s
RESEARCH REPORT 2018 33 FOCUS AREA 5 Human & Social Dynamics Research Centres: Centre for Tourism Research in Africa 129 human Performance Laboratory 130 FOCUS AREA 6 Economic Growth & International Competitiveness Research Chair: Wholesale & Retail Leadership 135
Please note that more information about this faculty’s research activities for 2018 can be found in the Focus Areas section of the Research Report:
during the April graduation, and one doctorate and 35 master’s during the December graduation.
Strategic initiatives and projects
Internationalisation within the Faculty of Business & Management Sciences continues to thrive, with tangible benefits for all stakeholders. In September 2018, a full-time Manager: Strategic Initiatives & Projects was appointed to lead all international endeavours. This illustrates clearly the strategic importance of internationalisation within the faculty. Regarding research-related aspects of internationalisation, three academic staff members were involved in international mobility in the latter part of year at the following partner universities:
• DH BW Ravensburg (Germany)
– Retail Business Management Department
• Os nabruck University of Applied Sciences (Germany) –Internal Auditing Department
• Ko blenz University of Applied Sciences (Germany) – Retail Business Management Department
Academics from the faculty also participated in Mobility Teaching and Training exchanges funded by Erasmus+ with the university of Economics, Bratislava in Slovakia, the university of Abertay in Dundee, Scotland and PORTO in Portugal, for between 7 and 14 days.
Research funding
Conference Committee
Of our 41 applicants who responded to the four calls during this year, by submitting applications for funding to attend local and international conferences, 19 (46%) were successful and R324 152 was awarded to them.
Research Exchange Programme
Three members of staff were supported with funding for research collaboration. They visited Igbinedion university in Okada in Nigeria, Koblenz University of Technology in Germany and Eden university in Lusaka Zambia. The latter received a top-up from W&RSETA.
University Research Fund
Five members of staff successfully applied for funds to support
research undertaken by six postgraduate students (one doctoral and five master’s candidates). They were awarded R280 048.
Qualifications Improvement Programme
Two members of staff were awarded funding to use to pursue their doctoral studies.
Postgraduate support
Continuing with our determination to provide much needed support to postgraduate students with a view to increasing the throughput rate, the following workshops were facilitated:
23-24 February – Key aspects of academic writing (Prof MO Dassah)

23 March – The research process (Prof R Pellissier)
21 July – Getting started with your research (Prof L Obokoh)
4 August – Literature review (Prof V Naicker)
19 August – Research methodology (Prof L Obokoh)
22 September – Academic writing: Structuring and writing the dissertation (Dr S Marawu)
Modelling Africa out of poverty requires understanding of its historical, social, political and economic contexts as it is multidimensional and difficult to measure. This is the view of Prof Jonathan Makuwira, DVC of the Malawi university of Science and Technology. Prof Makuwira delivered the keynote speech at the 5th International LAMIPISA Conference hosted by CPuT’s Department of Management & Project Management in September.
he argued that the criminality of poverty could not only be seen in a lack of materials, food and shelter but also in social and public institutions. “It is so subtle that one can hardly notice its violence; poverty is not only violent but also a crime against humanity,” he said. he added that while African states gained independence as a result of the efforts of ordinary people rather than political elites, who were fighting for their rights, this objective was later replaced by the concept of development. “Their poverty became the main problem of development. Therefore the Africans were problematised. The solution? Development!”
held under the theme ‘Modelling Africa out of chronic poverty’, the three-day conference was a melting pot of multidisciplinary research and industry practices,
encouraging global networking. Prof Paul Green, Dean of the Faculty of Business & Management Sciences, said joblessness was the biggest challenge facing the country’s democratic government. “The failure of the economy to match the growing labour force to job opportunities is a structural and fundamental problem,” Prof Green said. “The problem is further exacerbated by an economy characterised by volatility, uncertainty, complexity and ambiguity.” he added that when using the Gini-coefficient measure, inequality increased from 0.64 in 1995 to 0.69 in 2005, although it did improve to 0.65 in 2010/11. he was, however, excited about the future: “In Industry 4.0 we are entering an era of tremendous opportunities, and innovation is the key to sustainability, empowerment and growth in small business, digitisation and technology.”
FAC u LTY OF B u SI NESS & MANAGEMENT SCIENCES RESEARCH REPORT 2018 34
of Business & Management Sciences
Faculty
Spotlight falls on African poverty during international conference
Dr Larry Jowah was a speaker at the LAMIPISA Conference
Publications
Researchers in the faculty produced numerous excellent publications which were awarded funding from the DhET. A total of 52.16 units were conferred, comprising 3.15 for chapters in books, 7.86 for conference proceedings and 41.15 for journal articles.
Postgraduate degrees obtained by staff
PhD in English Education
Rhodes university
Marawu S
Code-switching as pedagogical strategy in classroom settings: The case of a township in a South African metropolitan municipality
PhD in Finance
university of Cape Town
Mutize M
The impact of soverign credit rating changes on financial market returns in Africa
New professor appointed
Assoc Prof Brendon Knott Sport Management *

* this ad hominem promotion took effect in 2017 but was unfortunately not captured in the Research Report 2017
Research output
Academic contributes chapter to multilingual education book
Academic and Language Co-ordinator in the Faculty of Business & Management Sciences, Dr Sithembele Marawu, has contributed a chapter in an international book about the value of multilingualism in education. The book, The Multilingual Edge of Education, was published early in 2018 by Palgrave Macmillan. Dr Marawu said the book emanated from the International Conference on urban Multilingualism and Education held at Ghent university, Belgium in 2013.

Subsequent to the conference, Dr Marawu was asked to develop his paper into a book chapter. “My chapter is about the value of code-switching as a pedagogical resource,” he said. “It’s based on classroom discourse and it analyses the communicative repertoire of teachers as they interact with learners in both English and isiXhosa.” The chapter, titled ‘Teaching in two languages: The pedagogical value of codeswitching’, emphasises that the learners’ mother tongue is a pedagogical resource, which contrasts with the dominant view that indigenous languages don’t have a role to play in pedagogy. “All languages can be used in education,” he argues. “We’re still perpetuating the colonial hegemony which imposed English as the only language of teaching and learning.”
he added that it felt good to have his paper selected for inclusion in the book, which includes contributions from some of the leading scholars in the field of bilingual or multilingual education such as Prof Jim Cummins, Prof Piet van Avermaet and Prof Kathleen Heugh. “The book is relevant as it says multilingualism is a resource that can be used in classrooms for educational purposes,” he added.
Dr Marawu completed his PhD degree at Rhodes university and graduated in April. Later during the year, he published articles based on his doctoral thesis.
RESEARCH REPORT 2018 35
Funding Conference funding (ConfCom) 324 152 National Research Foundation (NRF) 75 000 Research Exchange Programme (REP) 40 000 Research & Innovation Fund for Teaching & Learning (RIFTAL) 18 000 university Research Fund (uRF) 280 048 Total 737 200
2018 PuBLICATIONS (SuBMITTED TO ThE DhET IN MAY 2019) uNITS Chapters in books (submitted) 3.15 Conference proceedings (submitted) 7.86 Journal articles (audited) 41.15 Total 52.16
Dr Sithembele Marawu has a chapter in an international book
Dean’s Report Prof Thobeka Mda
The faculty’s research impact and output increased during 2018. These contribute towards the improvement of the education system for learners and adults in all educational contexts in south Africa. We are pleased with the progress in terms of subsidised publications and national and international research collaboration.
The Chairs
The year started out with four research units in the faculty. There were several positive developments in each of these units.
Centre for International Teacher Education (CITE) (NRF SARChI Chair): Prof yusuf Sayed
The centre has reached its five-year milestone as a SARChi unit, and is proud of its output: 34 articles in peer-reviewed journals; 29 book chapters; four books, focusing on initial teacher education and also continuing professional development; nine technical/policy reports: i) Research country report for ESRC; ii) Research country report on the PBEA project for uNICEF; 96 papers presented at conferences (local and international); 22 keynote/plenary addresses delivered by the Chair; six master’s degrees; 13 doctoral degrees; and eight postdoctoral fellowships. Due to this remarkable performance, the NRF has extended the term of this Chair for another five years.
Literacy Development and Poverty (CPUT Research Chair): Prof Rajendra Chetty
Prof Chetty left CPuT during the course of the year and another Chair will soon be appointed to complete its five-year cycle. During Prof Chetty’s first three years as Chair, the output was: nine articles in peer-reviewed journals; two book chapters; four papers presented at conferences (local and international); two keynote/plenary addresses; five master’s degrees; four doctoral degrees; and one visiting scholar. The incoming Chair will continue with
the unit’s research until the end of its term in 2020, with the possibility of a further extension.
Work-Integrated Learning (WIL) (NRF SARChI Chair): Prof Chris Winberg
The output and impact of this research unit has increased to such an extent that the unit was upgraded to an institute at CPuT early in 2018. This institute will service the whole of CPuT and no longer only the Faculty of Education.
Work-Integrated Learning in TVET Colleges (ETDP SETA Research Chair): Prof Nothemba Nduna

This research unit reached its end of the three-year cycle and was closed because its aims have been achieved. The Chair, Prof Joyce Nduna, will however continue to be involved in the development of a new qualification, an Advanced Diploma in Community and Adult Education, and in a WIL research project, both funded by the Department of higher Education.
Faculty output
The faculty hosted two adjunct professors this year, Prof Martin Braund from the UK and Prof Johan Anker who is a CPuT retiree, to assist staff and postgraduate students with their research endeavours and output. Their combined contributions:
• four journal articles
• seven workshops
• two conferences
• two international research collaborations
• several other manuscripts are on their way to publication

FAC u LTY OF ED u CATION RESEARCH REPORT 2018 36 Faculty of Education
The faculty’s research impact and output increased during 2018. These contribute towards the improvement of the education system for learners and adults in all educational contexts in south Africa.
Faculty staff members also produced research output from their own research projects. Numerous staff members were invited as keynote speakers at leading conferences, and hosted national and international researchers through the Research Exchange Programme and other research partnerships. Many others delivered papers at national and international conferences.
Research collaboration
Staff also participated in research collaboration and exchange with several international universities, which also generated third-stream income – in Belgium, the Netherlands, the uSA and Ethiopia. The Belgium project is about training the teachers of the future in terms of language policies and literacy. This project is driven from the Wellington campus by Dr hanlie Dippenaar, Dr Candice Livingston and adjunct professor Prof Johan Anker as well as Dr Nomakhaya from the Mowbray Campus.
The Netherlands project focuses on decolonising the teacher education curriculum and is led by Prof Liesel hibbert from the Mowbray Campus.
One project in the uSA, initiated by the Dean, Prof Thobeka Mda, is with the Ohio State university on classroom environments in underprivileged schools, with special focus on the intermediate phase.
The other uSA project is led by Prof Chukunoye Ochonogor from the Mowbray Campus with collaboration from the Miami Dade College in Florida. Their intercontinental collaborative research focuses on approaches of teaching complex Chemistry and Science topics.
The Ethiopian project, also led by Prof Ochonogor, is with the haramaya university, and has the aim of strengthening Mathematics, Science and Technology education through joint research and postgraduate supervision.
From the Mowbray Campus, Dr Naseema Shaik secured funding for developing a transformative pedagogy research project and programme development to improve the qualifications of South African practitioners working with birth to four year old children. Dr Shaik is the lead co-ordinator of the research project with six other higher education institutions participating. Two overseas collaborators, Prof Chris Pascal and Dr Tony Bertram, have also collaborated with CPuT on the project. 2018 was the second last year of the project, and thus project work was being consolidated.
Also from the Mowbray Campus, Dr Andre van der Bijl has secured funding of more than R4 million from
Please note that more information about this faculty’s research activities for 2018 can be found in the Focus Areas section of the Research Report:
RESEARCH REPORT 2018 37 FOCUS AREA 5 Human & Social Dynamics Research Chairs: Centre of International Teacher Education (CITE) (NRF SARChI Chair) 123 Literacy Development and Poverty (CPuT Research Chair) 125 Work-Integrated Learning (WIL) (NRF SARChI Chair) 126 Work-Integrated Learning in TVET Colleges (ETDP SETA Research Chair) 127
the DhET/Eu funded research and development project for the ‘Effective delivery of the work-integrated learning (WIL) component of TVET and ACET lecturer qualification programmes’. The project is being executed as a partnership between CPuT and the Swiss-South African Co-operation Initiative (SSACI). SSACI is a nonprofit, public-private partnership aimed at strengthening the national skills training system in South Africa, and is at the cutting edge of innovation within SA’s Technical and Vocational Education and Training (TVET) system. It opens pathways to skilled employment for young South Africans. The project involves not only the programme development but also the development of a research discourse on WorkIntegrated Learning (WIL) for lecturers, which was kick-started by Dr Van der Bijl.
In developing the research discourse on WIL for lecturers, five graduate
students have been funded and several publications flow from the project. At the end of February, the first of three writing workshops was held, aimed at developing research capacity. The 2018 writing retreat produced a number of peer review articles and conference papers, including five papers at the WIL Africa conference held in Durban in July, and four papers at the World Association for Co-operative and Work-Integrated Education 3rd International Research Symposium, held in Stuttgart in Germany in June. More retreats are scheduled for 2019 in preparation for a research book that will be published.
Graduations and professorships
Five doctoral degrees were obtained by staff in 2018: Dr Zakhile Somlata, Dr Xolani Mavela, Dr Kwanele Booi, Dr George Joubert and Dr Connie Babane.
Conference highlights transformation of higher education
CPuT hosted the three-day International Conference of the Southern African Society for Education (SASE) in October. This provided a forum for debating multidisciplinary educational issues impacting on higher education. Keynote speaker on the first day, uWC’s Deputy Dean of Research, Prof Beverley Thaver, said education did not only happen in the classroom but in multidimensional spaces and the marginalisation of communities outside the western world justifies calls for decolonised education.
Dean of CPuT’s Faculty of Education, Prof Thobeka Mda, complemented SASE on its longevity and said the society’s strength has ensured it did not collapse or become swallowed up by other professional bodies. Prof Mda added that the conference’s theme, ‘Creating sustainable

Three postgraduate students graduated with master’s degrees and three others with doctorates.
Assoc Prof Janet Condy was promoted to full professor. Dr Naseema Shaik, Dr Zayd Waghid and Dr Oscar Koopman were promoted to senior lecturer positions.
A vote of thanks
The faculty wishes to acknowledge and express its appreciation towards the following CP u T un its for supporting its continued growth:
• DVC: Research, Technology, Innovation & Partnerships
• Research Directorate
• Strategic Initiatives & Partnerships
• Technology Transfer Office
teaching and learning spaces, shaping futures, envisioning unity in diversity and transformation’, talks to her research work, especially around the physical learning space.
SASE President, Dr Elphinah Cishe, paid tribute to the universities of Fort hare, Zululand and Limpopo, whose education faculties established the society in 1971 to discuss issues affecting their academic work and environment. She explained the conference was a capacity building forum where emerging researchers presented their work without being ridiculed by experienced researchers. Dr Cishe pointed out that all South African universities were battling with transformation resource constraints owing to the increased enrolment figures witnessed after the advent of #feesmustfall.
CPuT’s VC, Prof Chris Nhlapo, said education and technology should be used to unite and to solve the problems of the continent. After discussing the status of research at universities, Prof Nhlapo outlined CPuT’s collaborations with other regional institutions such as ChEC (with Stellenbosch, uWC and uCT) and the u6+ (with various African universities).
The conference included sub-themes related to the ideals of a new inclusive identity and vision for the future of South African higher education system that reflected a more representative profile of cultures, heritages and epistemologies in a postcolonial society.
FAC u LTY OF ED u CATION RESEARCH REPORT 2018 38 Faculty of Education
Prof Chris Nhlapo (blue tie), Prof Thobeka Mda (blue coat), with SASE leaders and members of the organising committee
Postgraduate degrees obtained by staff
PhD in African Languages
Rhodes university
Somlata Z
A critique of language policy and implementation strategies used in selected institutions of higher lear ning in South Africa
PhD in Languages and Literature
Rhodes university
Mavela X
uphando-nzulu lweeMpendulo eziBhaliweyo zaBafundi
bamaBanga aPhezulu eMfundo kuNcwadi lwesiXhosa (An investigation of further education and training (FET) students’ written responses to isiXhosa literature)
DEd in Curriculum Studies
CPuT
Booi K
Life Sciences teacher educators’ perspectives of the principle of knowledge integration in the Life Sciences teacher eduationeducation curriculum
DEd in Education
CPuT
Joubert GF
The influence of gross motor development programme on the lives of learners from rural disadvantaged multi-grade schools
DEd in Psychology of Education
unisa
Babane VC
Exploration of educational challenges of immigrant children at selected Foundation Phase schools in South Africa
Funding
Passion leads academic to write doctoral thesis in isiXhosa
Dr Xolani Mavela, a lecturer in the Faculty of Education, is so passionate about isiXhosa that he wants to see a national literary museum built for the language. Born in Stutterheim, Eastern Cape, and a proud product of the local Jongile Nompondo high School, Dr Mavela’s passion for the isiXhosa language is deeply ingrained by his cultural identity and political convictions.
Dr Mavela recently graduated from Rhodes university with a doctoral degree. What made his PhD thesis more exciting was that it was entirely written in isiXhosa. Dr Mavela’s thesis, ‘uphandonzulu lweeMpendulo eziBhaliweyo zaBafundi bamaBanga aPhezulu eMfundo kuNcwadi lwesiXhosa’, investigated the causes of poor performance in written responses on isiXhosa literature assessments by FET home Language and First Additional Language students. The researcher used a mixed-method approach to gather his data and also provided measures to improve learner performance in isiXhosa literature assessments at both isiXhosa home Language and First Additional Language levels.
Dr Mavela was at high school when he decided to pursue a career in isiXhosa, and that became a reality when he enrolled for a BA degree with isiXhosa as one of the majors at uWC in 1993. he would later obtain the higher Diploma in Education there. he then completed both his honours and master’s degrees at Stellenbosch university he said that while he used English for his master’s dissertation, in which he analysed human rights texts such as minutes of parliamentary meetings, he also used isiXhosa examples to illustrate his points. he added that his PhD dissertation brought a tool to teach isiXhosa literature; it suggested that literature be digitised to make it appeal to the current tech-savvy generation. To this end, he is collaborating with teachers at Westerford high School on a project that has seen the audio-visual recording of the school’s prescribed set book, Sakohlulwa zindudumo (drama by Isaac Tau). “half the book has been recorded and the teacher has noticed a remarkable improvement in the learners’ academic performance since they started viewing the recordings,” said the columnist for Isolezwe lesiXhosa newspaper.

RESEARCH REPORT 2018 39
Conference funding (ConfCom) 177 913 Ghent university grant 358 432 National Research Foundation (NRF) 5 467 184 Research Exchange Programme (REP) 40 000 Research & Innovation Fund for Teaching & Learning (RIFTAL) 166 500 university Research Fund (uRF) 88 700 Total 6 298 729
2018 PuBLICATIONS (SuBMITTED TO ThE DhET IN MAY 2019) uNITS Books (submitted) 7.00 Book chapters (submitted) 3.74 Conference proceedings (submitted) 6.92 Journal articles (audited) 20.32 Total 37.98
Research output
Dr Xolani Mavela, who would like a national literary museum for isiXhosa
Dean’s Report Prof Mellet Moll


Research, technology, innovation and partnerships in the Faculty of engineering & the Built environment are aligned with key institutional and national focus areas, including satellite engineering, energy, Water, Infrastructure, Advanced manufacturing, environment, and engineering education. Two Research Chairs have been established – one in satellite engineering and the other in energy.
The Faculty of Engineering & the Built Environment covers a broad range of research disciplines across various entities, institutes, technology stations, research centres and units, all equipped with state-of-the-art facilities and technology such that the faculty can be well positioned to actively contribute to the current Fourth Industrial Revolution.
The research centres include: (i) the Centre for Substation Automation & Energy Management Systems, SA’s only fully up-to-date substation automation laboratory that offers specialised training, research and development in new technologies that will improve power systems in the country; (ii) the Flow Process & Rheology Centre, which solves problems relating to the flow of industrial fluids ranging from mining slurries, paste and thickened tailings, to explosive emulsions, foodstuffs, pharmaceuticals, fluid concrete and cosmetics; (iii) the Centre for Community Water Supply & Sanitation, that promotes sustainable water supply and sanitation services, contributing to the sustainable delivery of water and sanitation services to communities; (iv) the Centre for Distributed Power & Electronic Systems; (v) the Product Life Cycle Management Competency Centre, which provides cutting-edge product design, simulation and lifecycle management; (vi) the Centre for Instrumentation Research; and (vii) the South African Renewable Energy Technology Centre, which is the first national centre in the faculty to specialise in industry-related and accredited training for the entire renewable energy industry, including short courses and workshops.
The two research institutes are: (i) the French–South African Institute of Technology (F’SATI), the region’s premier nanosatellite programme, which developed Africa’s first nanosatellite, ZACube-1, and has recently launched the second and most advanced South African CubeSat equipped with technology to monitor South Africa’s coast and ocean. F’SATI has just received a mandate from the DST to produce more CubeSats; and (ii) the Energy Institute, which champions all energy research, technology and innovation in the faculty, so that it may respond to national imperatives in a coordinated way.
The two technology stations are:
(i) the TIA Adaptronics & Advanced Manufacturing Technology Laboratory, a specialised national manufacturing, research and educational resource centre for adaptronic technologies in South Africa; and (ii) the Clothing & Textiles Technology Station, which provides innovation support, services and short courses to help South Africa’s clothing and textile industry to become more competitive.
The Faculty of Engineering & the Built Environment prides itself on the quality of contributions made to research, technology and innovation as staff continue to showcase output in the form of journal publications, conference proceedings, books, book chapters and creative output. Some of these are achieved through multidisciplinary collaborative research and local and international partnerships.
FAC u LTY OF ENGINEERING & T h E B u ILT ENVIRONMENT RESEARCH REPORT 2018 40 Faculty of Engineering & the Built Environment
The Faculty of engineering & the Built environment prides itself on the quality of contributions made to research, technology and innovation
Please note that more information about this faculty’s research activities for 2018 can be found in the Focus Areas section of the Research Report:
Funding
Research output
RESEARCH REPORT 2018 41
Cape higher Education Consortium (ChEC)88 768 Conference funding (ConfCom) 616 677 CPuT Prestigious Project 1 000 000 Industry funding 6 289 552 National Research Foundation (NRF) 6 242 579 Research & Innovation Fund for Teaching & Learning (RIFTAL) 80 000 Technology Innovation Agency (TIA) 5 302 513 university Research Fund (uRF) 421 788 Total 20 041 877
2018 PuBLICATIONS (SuBMITTED TO ThE DhET IN MAY 2019) uNITS Book chapters (submitted) 4.81 Conference proceedings (submitted) 22.34 Journal articles (audited) 23.23 Total 50.38 Postgraduate degrees obtained by staff DTech in Electrical Engineering CPuT Dube NM Development of methods for modelling, parameter, and state estimation for nonlinear processes MEng in Electrical Engineering summa cum laude CPuT Ratshitanga M Investigation and design of an integrated monitoring, protection and control system of a power reticulation network FOCUS AREA 2 Space Science & Technology Research Institute: French–South African Institute of Technology 91 Research Centres: Africa Space Innovation Centre 93 Centre for Instrumentation Research, including Quantum Physics Research Group 94 FOCUS AREA 3 Energy Research Institute: Energy Institute 99 Research Centres: Centre for Distributed Power & Electronic Systems 100 Centre for Mechanics & Technology 103 Centre for Real-Time Distributed Systems 104 Centre for Substation Automation & Energy Management Systems 106 FOCUS AREA 6 Economic Growth & International Competitiveness Research Centre: Flow Process and Rheology Centre 142 Research Group: Nanomaterials Group 144 Technology Stations: Adaptronics Advanced Manufacturing Technology Laboratory 138 Clothing and Textiles Technology Station 141 FOCUS AREA 7 Design for Sustainability Research Centre: Product Lifecycle Management Competency Centre 148
Vice-Chancellor’s Prestigious Achiever Award launched

The recently launched VC’s annual Prestigious Achiever Award will be bestowed on deserving students who have shown academic excellence and embody the CPuT graduate attributes. VC, Prof Chris Nhlapo, said the purpose of the award was to financially aid CPuT students who have achieved excellent results throughout their academic studies and can make a contribution to society by completing their master’s and/or doctoral studies. “This award is not a replication of existing interventions. Rather, it is a way of ensuring that Dean and VC medallists remain connected to CPuT and come back to complete their master’s and doctorates with us, later becoming professors,” said Prof Nhlapo.

The first recipient of the award was Mechanical Engineering doctoral candidate, Ms Zamavangeli Mdletshe, whose research topic involves developing and testing a renewable energy based thermal desalination system. Ms Mdletshe was identified by her supervisor, Dr Velaphi Msomi, who encouraged the talented student to continue on to master’s and later, her doctoral studies. “She wanted to go to work and was so shocked when I asked her to consider doing her master’s. She received funding from the NRF and started in 2016; within 14 months she was finished and graduated cum laude,” he said. “At her graduation, I asked her mother to give her another three years to complete her doctoral degree and she agreed.”
unfortunately, the previous funding opportunity was no longer on offer and Ms Mdletshe was in danger of dropping out, until Dr Msomi responded to a staff email about the VC’s Prestigious Achievers Award. “I wrote to the VC and I was amazed when he wrote back to me almost immediately. We discussed Zamavangeli and her situation,” said Mr Msomi.
The event was also attended by former VC and Dean Medallists and their guests. Former VC Medallist, Mr Anthony Ezeonwuka, thanked Prof Nhlapo and CPuT for investing in talented students. “More financial support can make things easier; it would motivate more students to be like Zamavangeli and be the best they can be,” he said.
CPuT hosted the DST-uNESCO Engineering Week on Bellville Campus in September. It was sponsored by the Department of Science and Technology (DST), the united Nations Educational Scientific and Cultural Organisation (uNESCO) and the Engineering Council of South Africa (ECSA). “It was a great honour for CPuT to host the event,” said Prof Mellet Moll, Acting Dean: Faculty of Engineering. The week focused on addressing the challenges of the engineering profession in South Africa and the rest of the continent and was also aimed at attracting learners to subjects such as Science, Technology, Engineering and Mathematics. The event rotates among the nine provinces of South Africa.
The event started with a day-long student conference on 17 September. “Postgraduate students from engineering faculties of South African hEIs submitted abstracts and the best submissions are presented, with prizes for the best paper and best poster presentation plus a student function which provides a chance for the students from various institutions to network,” said Prof Moll. “The formal proceedings of the student conference are run by academic from CPuT, uCT and Stellenbosch, in collaboration with engineering students who are members of CPuT’s SRC.”
The main conference took place from 18 to 20 September, and was free and open to all people involved in the engineering profession, including industry and academia as well as people in related disciplines who have interest in the topics discussed. “We had a line-up of speakers from across the spectrum including DST, SANSA, NRF, ECSA,
CPuT, our neighbours uCT and Stellenbosch, as well as industry specialists,” said Prof Moll. “Engineering finds itself in a changing landscape, especially with the advent of the Industry 4.0 era. A lot of things have to be reframed so we selected the theme ‘Enabling the Fourth Industrial Revolution for Sustainability and Economic Growth’,” he added. The conference was divided into sub-themes which required dialogue, especially within the southern African context. These included Industry 4.0 itself, Energy, Water, Environmental Engineering, Infrastructure, Beneficiation, Space Science, Women in Engineering and Engineering Education.
FAC u LTY OF ENGINEERING & T h E B u ILT ENVIRONMENT RESEARCH REPORT 2018 42
Faculty of Engineering & the Built Environment
Women in engineering was a key topic of discussion at the DST-uNESCO Conference
Prof Chris Nhlapo with the first Prestigious Achievers Award recipient, Ms Zamavangeli Mdletshe, and supervisor, Dr Velaphi Msomi
Annual UNESCO Engineering Week held at CPUT

Dean’s Report (Acting) Prof Penelope Engel-hills

Academic staff in the Faculty of health & Wellness sciences (FhWs) are committed to providing high quality professional education and are increasingly including research and innovation into the teaching and learning environment. The research conducted in the faculty by academic staff and postgraduate students demonstrates the importance of research in the disciplines and in health education, with a growing emphasis on interdisciplinary and social science research relevant to south Africa.
From 2017 to 2018, the FhWS graduation rate increased from 5.2% to 10.5% of postgraduate students graduating, which numerically is an increase from six to twelve students. The fact that postgraduate numbers remained stable indicates a clear response to the focus on postgraduate completion and throughput. Amongst the graduates were four staff members: h hendrickse, MSc Biomedical Technology; B Arries, M Nursing; S Ismail, MSc Radiography; and M Zalgaonker, M EMS. This contributes to building of capacity and quality in research, supervision and research-led teaching. In total, 11 master’s degrees (three MSc Radiography, five MSc Biomedical Technology, one M Nursing and two M EMS) and one PhD Biomedical Sciences were awarded.

There has been a steady increase of around 0.3% in postgraduate students enrolled per year as a percentage of total students, which translates to 4.1% (114) of students in 2018 in comparison to 2.9% (84) in 2014. The percentage of doctoral students enrolled has also increased over the same period, from 13% to 21%. Of note is that students presented at the CPuT postgraduate conference where there were three oral and three poster presentations from FhWS, and Ms M Kemp received the best poster award. During 2018, there were 25 master’s students and several young researchers attending a postgraduate research module. The improved throughput was in part due to the implementation of this workshop in 2017, and there is evidence that the workshop increased
the successful publications of our students and supervisors. Positive feedback was received from attendees as well as input for improvements to the workshop and the faculty research process.
A highlight for 2018 is that three young researchers from our faculty were awarded NRF grants. Ms M Kemp and Ms L Hudson secured Thuthuka grants to assist in completion of D Radiography studies, while Dr S hector was offered both the Thuthuka and the Competitive support for unrated researchers grants. There was also an improvement in income generation from the university Research Fund, with 12 candidates funded in 2018 compared to one in 2017.
Researchers in the faculty maintained or improved their NRF rating status. The faculty congratulates Prof G Davison and Prof P Engel-hills on new ratings (C3 and C2 respectively), as well as Prof T Matsha who improved her rating to C1. The FhWS now has seven rated researchers and it is anticipated that this will impact positively on the publication rate. Records show submission of 12 publication units for 2018 which is a 20% improvement on the previous three years.
The Postgraduate Research Office is central to all activities related to staff and student research and is efficiently run by the faculty research co-ordinator and an administrator. A key function of this office is the administration of the Faculty Research Committee (FRC) and human Research Ethics Committee (hREC). These
FAC u LTY OF h EA LT h & WELLNESS SCIENCES RESEARCH REPORT 2018 44 Faculty of Health & Wellness Sciences
It is a network of operational support and vision that enables this faculty to steadily build a research footprint that will grow from year to year
committees succeed through the hard work and dedication of the respective chairpersons and committee members who do this over and above their other responsibilities. We are proud that our hREC is a registered committee with the National health Research Ethics Council (NhREC) and thank all involved in the council five-year audit that took place during 2018. Findings included the need for amendments to the terms of reference and standard operating procedures, which have been attended to. We are confident that registration with the NhREC will be retained, which is essential for continuation of research in the health sector. The faculty acknowledges the productivity and quality of reviews of the hREC and FRC, where 44 new applications were reviewed in 2018. Furthermore, the contribution of the hREC to the institution for the conduct of 12 external researcher reviews is noted, as is the progress made with the establishment of a functional Institutional Animal Research Ethics Committee.
The Department of Emergency Medical Sciences is commended for a very successful National Safety Symposium hosted in December that brought together directors from emergency medical departments across the country, EMC practitioners, politicians, criminologists, psychologists and other professionals who have an interest in addressing the wave of criminality facing emergency care practitioners in South Africa. This symposium has sparked research interests in the faculty.
Departments and research centres – including EMS, Biomedical Sciences and the Oxidative Stress Research Centre – have established partnerships that contribute to teaching and learning as well as research. Additional international partnerships such as between a Belgium university and Medical Imaging and Therapeutic Sciences are showing benefit. Another key research partnership between CPUT and Karlstad University in Sweden, has been facilitated through an NRF/STINT project that integrates community-based research and enhancement of research capacity. It is anticipated that this collaboration will lead to additional shared engagements in the future.
In closing, the Faculty of health & Wellness Sciences acknowledges the contribution from many at CPuT who work tirelessly to ensure that research at our institution is on an upward trajectory. In this time when interdisciplinary research is essential and teamwork vital, we extend our appreciation to the research institutes, centres, units and groups at CPuT who collaborate with researchers in this faculty. We furthermore acknowledge the DVC: RTIP for the impact she has made to progress research at our institution and all in the Research Directorate and CPGS for their support and commitment to the faculty and also to research in general. It is this network of operational support and vision that enables this faculty to steadily build a research footprint that will grow from year to year.
RESEARCH REPORT 2018 45
FOCUS AREA 7 Design for Sustainability Research Chair: Innovation in Society 147
Please note that more information about this faculty’s research activities for 2018 can be found in the Focus Areas section of the Research Report:
FOCUS AREA 1 Bio Economy & Biotechnology Technology Institute: Institute of Biomedical & Microbial Biotechnology 69 Research Centre: Oxidative Stress Research Centre 72 Research Entity: Cardiometabolic health Research unit 84
Two academics in the Emergency Medical Sciences Department went to Indonesia in September to assist with humanitarian aid and care following a devastating earthquake and tsunami. The disaster’s death toll was more than 1 400, while hundreds of thousands of people were left homeless. Mr Mustafa Zalgaonker and Mr Xavier Millar joined the team from the Gift of the Givers Organisation. The organisation, which has a longstanding relationship with the EMS Department, mobilised a team of search and rescue specialists to join search, rescue and recovery operations as well as the deliver muchneeded humanitarian aid and healthcare.
Mr Zalgaonker, a CPuT alumnus, has been a lecturer with the department since 2015. he is a seasoned Emergency Care Practitioner (Advanced Life Support) and a highly skilled Advanced Rescue Technician, with both national and international disaster response experience, having previously responded to the earthquake disaster in Nepal in 2015 and the Kynsna Fires in 2017.

It’s not surprising Mr Zalgaonker was ready to lend an experienced hand in the rescue efforts. Growing up,
he would often hear his mother say, “The giving hand is better than the receiving hand.” As he said, “It has been an eye-opener to see how people survive around the world and how we take things for granted. We have challenges in our health care system but it was humbling to see how elsewhere in the world people get by with a lot less, no running water and poor infrastructure.”
Mr Zalgaonker said that as academics, he and Mr Millar taught rescue, disaster management and rescue incident management. “So having the opportunity to go to a real-life disaster setting is an invaluable learning experience. We can convey the risk and the experience to our students,” he said.

Mr Millar has been the department’s rescue lecturer since the end of 2017. he is a highly experienced Advanced Life Support paramedic and a skilled Advanced Rescue Technician with expertise in urban Search and Rescue.The department has previously assisted in a number of Gift of the Giver disaster response operations, including the Nepal earthquake in 2015 and the Knysna Fires in 2017.
Mr Zalgaonker was among the hundreds of graduates at the graduation ceremony for the Faculty of health & Wellness Sciences. he earned his master’s degree with a thesis titled ‘Intravenous fluid resuscitation: Surveillance of penetrating injury in the pre-hospital environment’. he said, “You learn so much about yourself while completing such a degree, about your own resilience, how to manage your time and how to juggle what life throws in your path”. he added, “There is a sense of happiness you get from helping people. If you help people without them knowing you gain a sense of enlightenment.”
RESEARCH REPORT 2018 46 Faculty of Health & Wellness Sciences
EMS lecturers involved with Indonesia rescue efforts
Mr Mustafa Zalgaonker and Mr Xavier Millar went to Indonesia to provide humanitarian assistance
Lecturer and graduate Mr Mustafa Zalgaonker
Funding
Research output
Postgraduate degrees obtained by staff
Master of Emergency Medical Sciences
CPuT
Zalgaonker M
Intravenous fluid resuscitation: Surveillance of penetrating injury in the pre-hospital environment
Master of Nursing
CPuT
Arries B
Knowledge, perceptions and practices of members of the healthcare team involve in stem cell transplantations in the Western Cape
MSc in Biomedical Technology
CPuT
Hendrickse H
The relationship between immunogenic red blood cell antigens and human Immunodeficiency Virus infection
MSc in Radiography
CPuT
Ismail S
Anthropometric measurements versus computed tomography for the assessment of metabolic syndrome in the Bellville South mixed ancestry community, South Africa
Senior academic has designed a course for Mauritius
Prof Penelope Engel-hills, Acting Dean of the Faculty of health & Wellness Sciences, has designed a three-year course in Radiation Therapy Technology (RTT), which was launched in Mauritius in March. This National Diploma is the first formal qualification of its kind for the Indian Ocean island nation.
Prof Engel-hills said that in 2005 she was part of a panel, appointed by the International Atomic Energy Agency (IAEA), who went to Mauritius to design a core curriculum for radiation therapists for developing countries. “We designed a core curriculum and many countries, including Mauritius, used it to develop training programmes,” she explained. In 2013 and 2014, she returned to Mauritius on an IAEA mission to strength RTT training. “It was at that time that I was asked to design a three-year diploma under the auspices of the Mauritius Institute of health. We got all the approvals and permissions and the first 15 students started the programme in August,” she said. A further four students, who had received in-house training but no formal lectures, completed a Recognition of Prior Learning process, and have also joined the programme.
Prof Engel-hills said there were many wellqualified practitioners in Mauritius who would be lecturing students, and she would lecture some core subjects herself, as well as do the clinical assessments.

RESEARCH REPORT 2018 47
Prof Penelope Engel-hills has designed a three-year course in Radiation Therapy Technology
Conference funding (ConfCom) 23 897 Industry funding 2 250 516 National Research Foundation (NRF) 2 281 000 Research Exchange Programme (REP) 34 252 Research & Innovation Fund for Teaching & Learning (RIFTAL) 55 000 university Research Fund (uRF) 481 155 Total 5 125 820
2018 PuBLICATIONS (SuBMITTED TO ThE DhET IN MAY 2019) uNITS Book chapters (submitted) 0.56 Conference proceedings (submitted) 0.08 Journal articles (audited) 12.59 Total 13.23
Gender-based violence focus of new research project
and the Swedish Foundation for International Co-operation in Research and higher Education (STINT).
“Our project has two legs. One is community-based research with a focus on GBV, and the other is capacity building for improved research skills for postgraduate students, supervisors and researchers using the community-based research approach,” said Prof Engel-hills. The research is being carried out in a community in the South Peninsula.
“An NGO has come on board, and we are working with women to look at what the community responses are to gender-based violence.”
implementing a new idea. It’s all about what is right for that community and what they want.”
In terms of capacity building, the project aims to develop skills in innovative research methods and promote ethical awareness that will enable research in communities. “We will be running workshops. We have already run a pilot at CPuT for our postgraduate students, and we’re looking at two things. The first is the ethical dimensions of research in such communities, and the second is methodology. So we’ll put experts together and do the training in innovative ways,” she added.
CPUT and the University of Karlstad in Sweden are collaborating on a new community-based research project with a focus on gender-based violence (GBV). Prof Penelope Engel-hills, Acting Dean of the Faculty of health & Wellness Sciences, is the South African principal investigator for the study titled ‘Internationalisation for knowledge partnership and social transformation’. Funding for the project was received from the NRF

Prof Engel-hills said there were NGOs and ordinary residents in the community who were offering counselling, employment and other options for women who had been affected by GBV. “There is a lot of work being done, but what we understood from the community was that they would like to know what works and what more they can do,” she said. “We want to try to drive change through research, and model ways that communities can positively respond to violence. Once we’ve looked at all the options, we’ll consider
Training augments nurses’ knowledge
A group of nurses have benefited from visual acuity training provided by CPuT’s Ophthalmic Sciences department. Lecturer, Mr Prasidh Ramson, said the department was approached by TASK Applied Science to bolster nurses’ training in three basic screening tests important for patients with tuberculosis (TB). As a rare side effect, which is mostly reversible, TB medication can affect certain components of vision. While these occur infrequently, the overall adherence to medication is vital in the continued health of patients with TB, and others in their community. “There are some forms of TB medication that, with time, can affect the part of your eye that you use for colour vision. We screen to see if any such changes have occurred. If a patient appears to have colour vision challenges, the dose or type of medication then has to be reviewed by their doctor,” said Mr Ramson.

Mr Ramson led the training and was assisted by his colleague, Mr Michael
Jowell. Ms Michelle Eriksson, site coordinator at TASK Applied Science, said the training had been a valuable learning experience for nurses.
“We would like to thank CPuT’s Ophthalmic Sciences department for being so willing and supportive in
Prof Engel-hills said the researchers hoped that through gathering “living knowledge”, they would be able to make a positive contribution to social transformation. “For me, it’s about what do we do responsibly with the knowledge we build to change lives,” she explained. “That’s the competence we need to develop in postgraduate students in order to build a generation of young researchers who can really contribute to finding meaningful solutions to the problems in South Africa.”
providing this training,” she said. “Our nurses really enjoyed the interactive and engaging training session, and feel they have consolidated their knowledge and improved their understanding and skills in visual acuity training.”
RESEARCH REPORT 2018 48 Faculty of Health & Wellness Sciences
Researcher Prof Engel-hills
CPuT’s Ophthalmic Sciences department provided training to nurses
Making a difference at school level
and a selected group of second-year BEMC 2 Physiology students.

In 2018, only one high school was approached in order to determine the feasibility of the project. “In 2019 I will select an additional school in order to determine the sustainability of the project with the vision of maintaining it as an integral part of the department’s community service programmes,” Dr Gamieldien said.
The teaching excellence of a lecturer who strives to get more matric learners from disadvantaged backgrounds into university was acknowledged during the health & Wellness Sciences Faculty’s annual Teaching Excellence Awards in November. The Emergency Medical Sciences (EMS) Department’s Dr Kareemah Gamieldien won the Faculty Award during the ceremony.

Dr Gamieldien, with the help of her department, initiated a community project at her alma mater, Wynberg high School, in a bid to boost matric life sciences results through a revision programme. The vision underpinning the project is to help more learners achieve the requirements needed to qualify for programmes in the medical field.
“CPuT is always trying to ensure that our students are demographically represented. however, the social inequalities in our country are still quite evident and this places many of our matriculants at a significant disadvantage to qualify for the medical programmes offered at higher education institutions,” said Dr Gamieldien. “Being part of a department that invests in engaging and supporting the community, I identified an area to which the Anatomy and Physiology (A&P) programme could also provide a community service via community of practice.”
Dr Gamieldien said she asked herself the question: “What can EMS Basic Sciences do to help these matriculants qualify to even apply for medical or science programmes?” The answer lay in the revision programme. She approached Wynberg high School and offered the support of EMS Basic Sciences
to their life sciences matric students in preparation for their final exams. Ten second-year physiology students came along as tutors. The acting principal, Mr Gavin Nieuwoudt, and life sciences teacher, Ms Nabeelah Israel, collaborated on the project.
Dr Gamieldien said a significant number of learners at the school were from underprivileged homes and the school was under-staffed in terms of life sciences teachers. “After three sessions the results were unexpectedly exceptional,” she said. She acknowledged the Marketing and Communication Department and the Centre for Community Engagement and Work-Integrated Learning for their support. A total of 85 learners benefitted from the project and lessons were presented once a month on a Saturday morning until the start of the final exams. The lessons were presented by A&P staff
In other departmental news, two more awards were also announced. Both winners were from the Department of Medical Imaging & Therapeutic Sciences. They were Diagnostic ultrasound lecturer, Ms Merlisa Kemp, and clinical instructor, Ms heidi Thomas. “What I tell students is that sometimes your circumstances mould you, but you shouldn’t let your circumstances define who you are,” said Ms Kemp. Ms Thomas said the focus of her teaching was on active participation where everyone was involved in the learning process, peer engagement and literature.
Prof Penelope Engel-hills, Acting Dean of the Faculty of health & Wellness Sciences, said it was a great year for the faculty. She added, “I thank each and every one of you because our students come out of here ready to go into healthcare practice because they have such competent teachers and practitioners.”
RESEARCH REPORT 2018 49
The EMS Department helps matric learners qualify for tertiary medical programmes
Ms Merlisa Kemp, Dr Kareemah Gamieldien and Ms Heidi Thomas were honoured at the Health & Wellness Sciences’ Teaching Excellence Awards
Becoming agents of change
A recent seminar provided training for the rigorous but inclusive process of evidence-informed decisionmaking, while allowing each participant to consider a perspective of gender-based violence relevant to their own curriculum, teaching or research context.

Statistics on gender-based violence (GBV) in South Africa are staggeringly high, and universities are not immune to the scourge. As part of its response, the DhET and hEAIDS are developing a standardised framework for GBV, which will eventually be implemented at all universities across South Africa.
CPuT is among the institutions who decided to take a stand against GBV and an Institutional Position Statement on it has been drafted. The university’s new GBV policy was launched in August.
The Faculty of health & Wellness Sciences has been proactive in aligning staff members with the policy through a series of seminars designed to unpack the interventions that have been or could be used to reduce GBV in a particular health profession. The seminars considered interventions that promoted gender equality and challenged accepted cultural norms that endorsed violence against women and girls. It included descriptions of how interventions have been implemented and evaluated in a variety of social contexts, including schools and community structures, and how these might be replicated and/or modified for use in a health profession.
NGO partnerships provide the civil society responses of crisis intervention, advocacy and community of practice. The methodological rigour was supported by Canada’s McMaster university’s National Collaborating Centre for Methods and Tools. “If we acknowledge that one in three women will be victims of abuse in their lifetime, then the implication is that one in three female students or staff members may possibly be victims, and that one in three males may be perpetrators,” said Dr Navindhra Naidoo, Acting head of the EMS department and one of several collaborators on the draft policy. “We are putting the issue on our professional agendas. We are looking
at what is our science, what is our agenda, what are the tools of our trade, and how can we use the ‘tools’ of our proverbial ‘trade’ to be inclusive of gender-based violence,” he said.
Prof Penelope Engel-hills, Acting Dean, said the faculty was taking a critical look at how and whether the issue of GBV was being dealt with in the classroom and in the curriculum. “We know that at least 10% of reported rapes occur in higher education institutions. We really feel that if we get our lecturers and researchers talking about this, together with our support staff, we can influence what happens at CPuT,” she said.
Dr Naidoo said the issue of GBV affected all three of the university’s pillars of teaching and learning, research and community engagement. “In terms of teaching and learning, if students are intimidated or in constant fear they cannot meaningfully study,” he said. “Being free of violence is a social determinant of one’s education. We need to ensure that we provide a safe environment to promote and protect one’s health and education rights.” h e said much of CP u T’s research did not deal with the socio-political context of violence: “We need to get our respective professions more connected to our students’ lived realities.” h e co ntinued that our campuses were not protected from and our processes not protective of the escalating frequency and brutality of GBV, “which is why we need to do community engagement activities. We need to take the issue back to the community and say we as researchers have looked at this issue and we have the following policy recommendations so we can start influencing change. That’s how CP u T becomes an agent of change rather than a place where victims (and perpetrators) are ‘born’.”
Prof Engel-hills concurred: “Our research and our identity as being educators should work together and it must bring a positive influence in our communities”.
To read more about the policy, please visit: https://www. cput.ac.za/newsroom/news/article/3535/cput-takesstand-against-gender-based-violence
RESEARCH REPORT 2018 50
Faculty of Health & Wellness Sciences
Participants at the seminar for evidence-informed decision making

Dean’s Report Prof Johannes Cronjé

The Faculty of Informatics and Design (FID) has had a particularly busy and successful year in terms of research. Some of the highlights include:
• The ongoing Learning Network of Networks on Sustainability (LeNSin) Project (an Eu-supported Erasmus+ which aims to improve the internationalisation, intercultural cross-fertilisation and accessibility of higher education on Design for Sustainability) successfully achieved:
- Establishment of a transdisciplinary LeNS lab to support postgraduate research projects across the faculty
- Delivery of a transdisciplinary course to students and lecturers from across the university as well as industry practitioners; the course was on methods and tools for community-based research projects
• Researchers from FID participated in the Impala Project which was driven by CPuT’s Strategic Initiatives & Partnerships directorate. A major deliverable of the project is the implementation of a video-conferencing facility which is located in FID. The facility, which is called the COIL lab is for use by the university community.
• ‘Digitising the Precious Little Book’, funded by The Motsepe Foundation, is a project which was undertaken by researchers in the Information Technology Department together with undergraduate female students. This was after our four female students had won a Women in Computer Science hackathon competition.
• ‘Multilingual student-generated open education resource’ is a project funded by Fundani and undertaken in the Applied Design Department to facilitate open education and collaboration.
• Researchers in the Applied Design Department collaborated in the ‘Flowers of Cape Town’ project, which will feed into an exhibition in helsinki in Finland in 2019.

• The then Research, Innovation & Partnership Department conducted a workshop with the Theewaterskloof Community titled ‘PhOTO-reveal the beauty in YOuR space’.
• NRF rating was awarded to Assoc Prof Justine Daramola. NRF funding was secured by Prof Ephias Ruhode, Prof Justine Daramola, and others.
The postgraduate section of the faculty is working well with regular meetings of the DRAW and Terps groups that meet on Fridays and Mondays respectively.
Finally, the faculty has said a sad goodbye to Prof Retha de la harpe, who has retired as our Research Co-ordinator. We wish her well in her new endeavours.
FAC u LTY OF INFORMATICS & DESIGN R ESEARCH REPORT 2018 52 Faculty of Informatics & Design FAC u LTY OF h EA LT h & WELLNESS SCIENCES
Please note that more information about this faculty’s research activities for 2018 can be found in the Focus Areas section of the Research Report:
Research output
Student research is relevant in media contexts

Dr Elizabeth Ferreira from FID’s Media Department has supervised 70 BTech students who have completed research projects in either Journalism or Public Relations Management. These projects formed part of a course that teaches students the steps followed in the planning, execution and writing up of an academic research project from the conceptual stage to the problem statement, research proposal, data collection, and the interpretation and presentation of research results.
In the process, students were introduced to quantitative and qualitative social science research methods commonly used in public relations, journalism and media contexts to identify and solve problems. New topics are prescribed every year in an effort to provide students with subject matter relevant and current in media contexts.
Journalism students could choose between four research topics: ‘The spectrum, framing and priority of radio news coverage of the Cape water crisis: A comparative study’; ‘An application of theories of communication for development to determine a selected community radio’s pattern of coverage of a specified social justice’; ‘A media political economy study to identify core elements that may contribute to the media bias of a news organisation’; and ‘understanding misinformation: A focus group study of audience perceptions of news authenticity and credibility’.
Public Relations Management students were required to complete a content analysis on a sample of educational videos on the social media platform YouTube to identify message characteristics that elicit more favourable viewer responses. Students could choose between
the following video topics: ‘Social media monitoring in public relations’; ‘Crisis communication case studies’; ‘Augmented reality and its potential benefits in corporate communication’; and ‘Research methodology in public relations research’.
RESEARCH REPORT 2018 53
FOCUS AREA 7 Design for Sustainability Research Chair: Innovation in Society 147 FOCUS AREA 6 Economic Growth & International Competitiveness Research Centre: Website Attributes Research Centre 137
Research Exchange Programme (REP) 40 000 Conference funding (ConfCom) 108 223 National Research Foundation (NRF) 413 535 Research & Innovation Fund for Teaching & Learning (RIFTAL) 138 000 university Research Fund (uRF) 889 600 Total 1 589 358
Funding
2018 PuBLICATIONS (SuBMITTED TO ThE DhET IN MAY 2019) uNITS Chapters in books (submitted) 3.96 Conference proceedings (submitted) 5.41 Journal articles (audited) 22.70 Total 32.07
Dr Ferreira sets pertinent research tasks
Facilitating change through design
BTech Architectural Technology students are gaining valuable work experience and life skills designing a public gathering space for a Philippi community. Senior lecturer and BTech co-ordinator, Ms Jolanda Morkel, said students were working with NGO ubuhle Bakha ubuhle on a design proposal for an existing site in Sweet home Farm. Their brief was to explore design possibilities for consideration and possible future implementation, while considering the community in the design process and increasing opportunities for social impact. The students were required to align the needs of the community with the water crisis to create innovative spaces where people can congregate, access natural and digital resources as well as trade. The project is co-ordinated by lecturer, Mr Lloyd Pretorius.
BTech lecturer and water activist, Ms Caron von Zeil, who recently returned from attending the Global Water
Conference in Brazil, helped students understand the impact of important water issues on design decisions. “The project gives BTech students the opportunity to work with the community, listen to their needs and come up with valuable solutions,” said Ms Morkel. She said the project has not only shown students that architecture could be practiced in different ways, but also is also teaching them that through design, quality urban spaces could be created that are dignified and uplifting.
Mr Olwethu Jack, a former student and the founder and general manager of ubuntu Growing Minds, also shared with students a presentation of his work in informal settlements, after which he gave interim feedback on their work. Ms Morkel said students were inspired by his approach to change and transformation in communities,and that he empowered them through his facilitation.

FAC u LTY OF INFORMATICS & DESIGN RESEARCH REPORT 2018 54
of Informatics
Faculty
& Design
Students presenting their work to community representatives
Centre for Innovative e du cational Technology
CPUT Libraries

Fundani Centre for h ig her e du cation Development
h IV /Aids Unit
s tu dent Counselling
Academic s up port
smiti@cput.ac.za
Centre for Innovative Educational Technology (CIET) Mr Izak Smit

The Centre for Innovative educational Technology (CIeT) is a strategic academic support unit and believes in practice-based research. CIeT runs a number of collaborative action research projects with academics within and beyond our institution. Although the mandate of the unit and its focus is on the effective and extensive utilisation of educational technology in learning and teaching, the academic staff also fulfil a social responsibility role in applying their research skills in other areas of expertise and interest. With respect to the research initiative highlights for the 2018 academic year, the focus is on topics such as open and blended learning, digital storytelling, socially just pedagogies, massive open online courses (mOOCs) and design thinking for academic staff development, including assisting academics in drawing up the curriculum for blended learning through to the learning design of online teaching courses. There is also a strong research focus on the ethical use of student performance data, measured through learning analytics, to find ways to improve student throughput and success.
CIET plays a major role in academic staff development in various projects funded from the DhET uCDP grant, with a strong focus on the effective utilisation of educational technology in teaching practice. These research projects involve the research, development and publication of open educational resources (OER), improving student throughput and success through the use of learning and learner analytics, assisting academics to present action research findings on the use of educational technologies at the annual Teaching and Learning with Technology Day, and the development of blended learning practitioners under our teaching academics.
Collaboration on research projects
CIET staff participated with other researchers at CPuT and at other higher education institutions in the region in two RIFTAL-funded research projects and two NRF projects:
• Development of ethical guidelines for digital storytelling
• Development and co-design of a model for decolonising the curriculum through a short
course on critical compassionate citizenship
• Reconceptualisation of socially just pedagogies across diverse geopolitical settings in higher education
• A multidimensional and integrated exploration of inequalities in South African higher education: Effects on students
The centre also led a research project:
• Toward decolonisation within the university: On the innovative application of educational technology
Editorial support and review of research publications
CIET staff take up roles of editors and reviewers for DhET accredited journals, such as the South African Journal of higher Education (SAJhE). Prof Eunice Ivala participated in the NRF review panel for the South Africa–Tunisia Joint Call for Research Development Projects, which involved evaluating proposals for project approval and funding.

RESEARCH REPORT 2018 56
ACADEMIC SUPPORT
Technology transfer is a process directed at unlocking this value by aiming to transform this research into a tangible output that impacts positively on society
National and international conference participation
CIET staff members attended, published and presented papers at national and international conferences, such as the Community Engagement and Social Innovation (CESI) Conference in Grahamstown, the ECP Regional Colloquium in CT, the higher Education Close up (hECu) in CT, the International Conference on eLearning (ICEL) in CT, the World Congress on Education in Mumbai, India, and the American Educational Research Association Conference, New York, which is the world’s largest education conference.
Online multilingual glossaries set to expand

Ms Linda Manashe, a courseware developer at CIET’s Educational Technology unit, is cautiously optimistic about the potential path of online multilingual glossaries at CPuT. She presented preliminary findings from a study she is working on at the International Conference on e-Learning (ICEL), hosted at the Granger Bay Campus in July. These findings form the basis of her master’s thesis, ‘Online multilingual glossaries in teaching and learning: A feasibility study’. Ms Manashe looked at the accessibility of content and the use of the platform.
Invited presentations and workshops
Prof Daniela Gachago and other colleagues from CPuT were invited to open the Decolonial Transformation Conference at the University of Sussex in Brighton, UK in October.


While her thesis examines three different glossaries, her talk at ICEL concentrated on the experience of 56 first-year students studying Law of Contracts at the Faculty of Business & Management Sciences’ unit for Applied Law. Most of the students felt the language used was understandable and they recommended using more African languages in higher education. Students considered the freedom to interact with the platform anytime from anywhere to be beneficial and asked for a live chat section as well as a Facebook group to be added. While most thought the glossary was useful and accessible, opinion was split about whether they thought the platform looked appealing. “There is a high level of promise to using an online glossary for academic success,” was Ms Manashe’s conclusion.
The glossary lists were initially compiled by the subject lecturers, starting with the 100 words/ concepts they considered most problematic. These go through a rigorous verification process involving lecturers, students, industry specialists and external language experts. “We sit in a verification workshop, we debate, create, coin and borrow words, and make sure the verified definitions speak to the context of the academic concepts,” explained Ms Manashe. This ongoing project was launched in 2016 and already there are 12 glossaries online, with 23 more glossaries in the pipeline waiting to be verified.
RESEARCH REPORT 2018 57
Presenters from CPuT at CESI in Grahamstown in May
Ms Linda Manashe is researching online multilingual glossaries in teaching and learning
hosting of conferences

CIET, under the Chairship of Prof Eunice Ivala, hosted the 13th International Conference on e-Learning, attended by people representing over 40 nationalities on 5-6 July, at CPuT’s Granger Bay Campus. Prof Ivala also edited the conference proceedings.

Promotions and awards
Prof Daniela Gachago was promoted to associate professor in August 2018. her research interests lie in the potential of innovative technologies to transform teaching and learning in higher education. Current research projects focus on the ethics of blended and open learning in contexts of inequality and multimodal pedagogies such as digital storytelling as a decolonial classroom practice.

Prof Eunice Ivala was awarded an Excellence Award in e-Learning by Global Learn TECh for the impact of her research in changing people’s teaching and learning practices.

New book publication
Dr Faiq Waghid (a lecturer in Educational Technology), Prof Yusef Waghid (a distinguished professor from Su), and Dr Zayd Waghid (a senior lecturer in CPuT’s Faculty of Education), co-authored their second international book titled Rupturing African Philosophy on Teaching and Learning this year. The book was published in New York by Palgrave-MacMillan. It examines African philosophy of education and the enactment of ubuntu justice through an MOOC on Teaching for Change. The authors argue that such pedagogic encounters have the potential to stimulate just and democratic human relations; encounters that are critical, deliberate, reflective and compassionate could enable just and democratic human relations to flourish, thus inducing decolonisation and decoloniality. This work will be of value for researchers and students of philosophy of education, higher education and democratic citizenship education.

Funding
Research output
RESEARCH REPORT 2018 58
Prof Eunice Ivala
World Education Congress: Global Awards
Dr Faiq Waghid
Conference funding (ConfCom) 15 816 National Research Foundation (NRF) 30 000 Total 45 816
2018 PuBLICATIONS (SuBMITTED TO ThE DhET IN MAY 2018) uNITS Books (submitted) 2.00 Book chapters (submitted) 1.42 Conference proceedings (submitted) 0.62 Journal articles (audited) 2.49 Total 6.53 C EN TRE F OR I NN OVATIVE E D u CATIONAL T EC h NO LOGY ( CIET)
CPUT Libraries Dr Elisha Chiware

CPUT Libraries’ support for research activities in the institution continues to grow, as do its engagements with postgraduate students and researchers. The information resource base available to the university community is also expanding with access to a rising collection of open access databases. In addition, more research-based books are being purchased in electronic format to enable wider access.
The Libraries make available a number of research support platforms and services to the CP u T community in order to enhance research visibility and impact. These include Research Data Management services, Data Management Plan (DMP) tools, and data repositories (Figshare and MediaT u M) , where data can be managed, stored and shared. The university also continues to play a key role in supporting research impact assessments with the provision of bibliometrics and altmetrics reports.
In 2018, the Public Knowledge Project’s (PKP) Open Journal System platform was launched, and this currently hosts three CP u T publications:

HIV: Status Update
Journal of Business and Management Dynamics (JBMD)
Journal of Leadership and Management Studies (JOLMS)
The other PKP platforms also available to the CP u T community through the Libraries are PKP Open Monographs for publishing open textbooks and PKP Open Conference System for managing conferences.
Libraries’ staff members continue to contribute to the research output of the university by publishing articles in D h ET accredited journals and presenting papers at international conferences and workshops.
D h ET publications f or 2018
‘Research trends and collaborations by applied science researchers in South African universities of technology: 2007-2017’ (Journal of Academic Librarianship) (ERT Chiware and DA Becker)
‘Research data management services in Southern Africa: A readiness survey of academic and research libraries’ (African Journal of Library, Archives and Information Science) (ERT Chiware and DA Becker)
‘Citation patterns of conference proceedings in master’s and doctoral studies: A case study of Information technology and systems’ (Information Development) (ERT Chiware and DA Becker)
‘Implementing a Certificate of Information Literacy programme and engaging with faculty: A case study of the Cape Peninsula university of Technology’ (South African Journal of Libraries and Information Science) (Z Davids and Y Omar)
‘Collaboration on LibGuides in public universities in South Africa’ (Global Knowledge, Memory and Communication) (S Bangani and V Tshetsha)
‘The deployment and impact of libguides at public universities in South Africa’ (International Information & Library Review) (S Bangani and V Tshetsha)
Funding
Dr Lynn Kleinveldt received a ConfCom funding award during 2018.
RESEARCH REPORT 2018 59
The Libraries make available a number of research support platforms and services to the CPUT community in order to enhance research visibility and impact
chiwaree@cput.ac.za
Postgraduate degree obtained by a staff member
PhD in Philosophy, Science, Cognition and Semiotics (PSCS) university of Bologna Kleinveldt L
The role of libraries in support of academic research: A study of Chemistry and Chemical Engineering at the Cape Peninsula university of Technology and the university of Bologna
Funding
Research output
Librarian discusses technology in education at conference in Malaysia

A CPuT librarian shared her knowledge about integrating technology into library science education with the world at a conference in Malaysia in September. Dr Lynn Kleinveldt, Faculty Librarian: Applied Sciences and health & Wellness Sciences on the District Six Campus, presented a paper during the 84th International Federation of Library Associations and Institutions (IFLA) World Library and Information Congress in Kuala Lumpur. Dr Kleinveldt also
moderated a panel discussion held at the Reference & Information Services Section and IT Section joint satellite on ‘Reinventing reference with technology transformations’ at the university of Malaya on the eve of the seven-day conference.
Dr Kleinveldt was invited to speak at the conference during the ‘Celebrating IT innovations in libraries’ session as IFLA’s IT Section celebrated its 55th anniversary this year. In line with
the conference’s theme ‘Transform libraries, transform societies’, an open session was held to celebrate technologies and innovations over the last 55 years that still transform libraries today, and explore emerging and innovative technologies shaping the future of libraries. The purpose of her paper ‘IT integration into LIS education: An academic librarian’s perspective’ was to showcase how IT has transformed academic librarianship and the 21st century academic library, particularly in the South African context. She argued that some outcomes of IT integration in Library and Information Science education include increased confidence in embracing and implementing new technologies in the workplace, continuous network building for collaborative projects, and the ability to disseminate best practices both nationally and internationally through conferences and publications. “The paper gives insight into new possibilities for academic librarians,” she said.
Dr Kleinveldt is a Standing Committee Member of the IFLA IT Section for the term 2015-2019, and her nomination resulted from previous international collaboration.
“My active participation in the IFLA IT Section develops both my librarian profession and places CPuT on the map with regard to making a contribution to IT and innovation on a global scale, adding value to the institution,” she said.
RESEARCH REPORT 2018 60 CP u T LIBRARIES
Conference funding (ConfCom) 27 218
2018 PuBLICATIONS (SuBMITTED TO ThE DhET IN MAY 2019) uNITS Journal articles (audited) 4.00
Dr Lynn Kleinveldt (far right) moderated a panel discussion at the University of Malaya
Fundani Centre for Higher Education Development Prof Monwabisi Ralarala

In 2018, the Fundani Centre for higher education Development (CheD) staff were actively involved in research and published articles in international and local journals. They produced 12 journal articles, one book chapter and one edited book, with a total credit value of 8.68 units. Fundani staff supervised one doctorate and two master’s students, all of whom graduated. Fundani academics continue to supervise a number of CPUT staff members who are engaged in postgraduate study focusing on higher education, and they are often chosen as external examiners for master’s and doctoral theses and as keynote speakers at conferences and universities.
Four papers were presented at international conferences during 2018. Two were presented at the 25th International Conference on Learning in Athens, Greece: ‘Participatory parity’ and ‘Finding the personal in the development of school-based substance abuse prevention programmes’. Papers on the first-year experience were presented at International First Year Experience Conferences: ‘The influence of prior schooling on university transition’ and ‘understanding first year students’ situated circumstances’. Several Fundani staff attended the local higher Education Lear ning and Teaching Association of Southern Africa (hELTASA) Conference.
Prof Monwabisi Ralarala, the centre’s director, participated in a Research Exchange Programme (REP) which resulted in the production of a book titled New Frontiers in Forensic Linguistics, Themes and Perspectives in Language and the Law. The book will be published in June 2019. Dr Xena Cupido was also involved in an REP, and attended an international research workshop titled ‘Decolonial Transformations: Imagining, Practicing and Collaborating’ at the university of Sussex in Brighton in the UK.
Research development activities within Fundani range from regular writing retreats to ‘shut up and write’ sessions. Two innovative ‘shut up and write’ sessions were held in March and May, at CPuT’s hotel School in Granger Bay. These are unstructured group writing sessions in which participants bring an academic writing task (e.g. a journal
article or thesis chapter) and spend two to three hours in silence around a table doing their writing.
Fundani ChED provides a supportive space for research into teaching and learning across the faculties. The centre’s staff support research into higher education through collaboratively teaching with the three other Western Cape universities offering research courses for staff as well as through an internal Scholarship of Teaching Programme.
In October, Fundani’s Extended Curriculum unit hosted a writing breakaway on reconfiguring theories of teaching on the ECP. Staff who were developing first drafts of articles for a Fundani-edited special edition of the journal Alternation on theorising foundation were invited to attend. CPuT staff who participated in the workshop submitted six articles for review.
Fundani plays a significant role in the CPuT Research Focus Area of human & Social Dynamics, drawing on research in Science, Technology and Society and in Organisational Dynamics. In May, Fundani, together with the WIL SARChI Chair, hosted Prof Arie Rip from the university of Twente on using the STS research technique of ‘Fictive Scripting’, a form of scenario research. In September, Fundani hosted Prof Jaakko Virkkunen from the university of helsinki for a one week research training session on conducting and researching change laboratories. This was attended by Fundani staff as well as 11 academics from the faculties of health & Wellness Sciences, Business & Management

RESEARCH REPORT 2018 61
Fundani CheD provides a supportive space for research into teaching and learning across the faculties
ralaralam@cput.ac.za
Sciences, Education and Informatics & Design. Both these projects lie within the NRF-funded hSD project ‘Reimagining universities of Technology’.
Each year, approximately R700 000 is disbursed to CPuT faculty members by Fundani in order to conduct classroombased research, under the DVC: Teaching & Learning’s RIFTAL project. In 2018, projects submitted and approved for funding addressed issues of decolonisation and educational transformation in curriculum and/or classroom activities. Academic staff presented their research findings at the annual Research in Teaching and Learning Conference (RITAL), held on 6 December. The conference’s theme was ‘The Scholarship of Teaching and Learning’, and it attracted 20 presentations, five poster presentations and four workshops. It brought together academics from across CPuT’s disciplines who were interested in the systematic inquiry of teaching and learning. The keynote speaker was Prof Kwesi Prah, who is the founder and was the Director of the Africa-wide Centre for Advanced Studies of African Society (CASAS) based in Cape Town. Prof Prah is at present mainly involved with work in anthropological linguistics, specifically the harmonisation of African orthographic conventions.
The second seminar, titled ‘Decolonising the university: Epistemic freedom provincialisation and deprovincialisation’, was delivered by Prof Sabelo Ndlovu Gatsheni, the acting Executive Director of the Change Management unit (CMu) in unisa’s VC’s office. he stated that decolonisation entails “reorganisation of knowledge, rethinking of disciplines, reformulation of curriculum, and transforming of pedagogies – with a view to re-humanise the dehumanised, so as to attain relevance and social justice.” The respondent was Mr Siya Sabata, who is the CPuT decolonial project leader. The third seminar titled ‘Decolonisation a complex drama of words’ was delivered by Dr Joel Modiri, a lecturer in the Department of Jurisprudence at the university of Pretoria. This focused on epistemic justice and the centering of African culture at the heart of academy and development. The respondent was Ms Asanda Ngoasheng, a lecturer from CPuT’s Media Department’s Journalism Programme.

Teaching innovations showcased at conference
CPuT lecturers and students discussed the latest trends in teaching at the 6th RITAL Conference, held on the Bellville Campus by Fundani’s Academic Staff Development programme.
Prof Anthony Staak, DVC: Teaching & Learning, said RITAL conferences provided a wonderful opportunity for staff to showcase their innovations in teaching and learning, share best practices and subject their research to review by their peers. “The conferences also have a capacity development component and will hopefully serve as a stepping stone for staff to submit their papers to national and even international conferences in the future,” added Prof Staak. he said the RITAL Conference has made a huge contribution to promoting a scholarship of teaching and learning (SoTL) at CPuT. “Not too long ago there was a sense that teaching and research were ‘pulling in opposite directions’. Research was viewed as taking place in a disciplinary research culture, carrying out the job of generating knowledge in the discipline,” he said. “There was the sense that teaching and research were working in competition with each other for resources, space, time and recognition.”
Prof Lorraine hassan, head of Academic Staff Development, added that complexities experienced in the teaching profession included use of ICT, the issue of decolonisation, and trying to enhance the learning experience. “SoTL can help reduce inequalities and solve societal problems,” she said. She added that SoTL would improve the university’s research or knowledge output.
Trustee of the Cape Town-based Centre for Advanced Studies of African Society, Prof Kwesi Prah, delivered the keynote address, ‘Language and societal relevance in teaching and learning’. Prof Prah said all societies which developed in a sustained fashion used their mother tongue for teaching purposes. he argued that despite the benefits of mother tongue education, previously colonised people are “neocolonialist beings or creatures” who wanted to look and speak like their colonial masters. “They are not serious enough to protest against assimilation into Western culture.”
Research output
RESEARCH REPORT 2018 62 F u NDANI CENTRE FOR h IG h ER ED u CATION DEVELOPMENT
Funding Conference funding (ConfCom) 50 701 National Research Foundation (NRF) 65 000 Total 115 701
2018 PuBLICATIONS (SuBMITTED TO ThE DhET IN MAY 2019) uNITS Books (submitted) 1.00 Conference proceedings (submitted) 0.17 Journal articles (audited) 7.51 Total 8.68
Trustee of the Centre for Advanced Studies of African Society, Prof Kwesi Prah
Freeing the mind by changing the way you view language
Prof Kwesi Prah, founder and Director of the Africa-wide Centre for Advanced Studies of African Society, was the speaker at the inaugural Seminar on Decolonisation held at CPuT in June. his talk was followed by a series of workshops around issues of decolonising the curriculum in higher education. Prof Prah deftly sketched an outline of the concept of decolonised education in Africa.
Fundani ChED, supported by the Impala project, which forms part of the Eu-funded Erasmus+ Key Action 2: Capacity Building in higher Education programme, spearheads this institutional project. One of the major focus areas of the decolonisation project is seeking cognitive justice and decentring Western knowledge through curriculum renewal activities.
Prof Prah defined colonisation as a total system that affects all areas of social life of the colonised. he explained how it is in language that the colonial process, past and present, was most manifest, decisive and conspicuous. Drawing the link between education and language as the key instrument in the delivery of education, he expounded on how the use of a foreign language as the medium of instruction constrained students’ ability to fully participate.
“If the decolonisation of education in our time is to have meaning and a chance of success, the movement away from the colonial languages to home languages and the mother tongue would be essential,” he said.
Prof Prah pointed out that Africa remained the only place in the postWWII Afro-Asian world where the
language of the erstwhile master featured as an official language and language of instruction in a generalised and ubiquitous way. “If the decolonisation process is to be realised, then a start has to be made at this point of departure,” he said. The decolonisation of education actively requires ancillary activities and infrastructure. For example, the use of African languages requires that facilities for the development of scientific terminology and the creation of meta-language be created.
The process of decolonising education has different implications for the natural sciences as distinct from social sciences. The natural sciences study the invariably insensible physical matter and it is possible to study the anatomy and physiology of the human body separate from the consciousness which the physical configuration the body expresses. The arts, humanities and social sciences in contrast,
deal with what is fundamentally and essentially human, in other words, culture and culture-related manifestations, all of which are intricately bound up in language as a means of expression. The implications of this difference are important to CPuT, which is an essentially natural sciences oriented institute.
Study areas know no borders, and analytical procedures are not country-specific. “Decolonisation should mean greater voice and means to autonomously produce and reproduce knowledge. It implies that we are better able to produce answers to our own problems and satisfy the needs of our society,” said Prof Prah. “The confidence to do this cannot come until we are culturally able to stand on our own feet, particularly through the enabling of our languages to become languages of the sciences and technology.”
Fundani, in collaboration with Impala, held three decolonial seminars during 2018 in order to encourage debate, discussion and research on decolonisation. The seminars featured South Africa’s leading decolonial scholars. The first seminar titled ‘Relevance and scope of the decolonisation of education’ delivered by veteran decolonial
scholar, Prof Kwesi Prah, the founder and the Director of the Centre for Advanced Studies of African Society, highlighted the centrality of the African ontological being (endogeneity) in the post-colonial university. The respondent was Dr Bongani Nyoka, a young decolonial scholar based at unisa, in the Archie Mafeje Research Institute (AMRI).


RESEARCH REPORT 2018 63
The decolonial seminar series
Prof Kwesi Prah talks to Dr Bongani Nyoka at the start of the inaugural Seminar on Decolonisation
Prof Kwesi Prah
HIV/Aids Unit Ms Melanie Marais

Amajita’s Men’s health Campaign
The campaign took place at three of the major CPuT campuses – District Six, Bellville and Mowbray – during June 2018. The Amajita’s Campaign served as a platform to bring young men at CPuT together to work on solutions and to take ownership of pertinent psycho-social issues on campus by addressing men’s involvement in health-seeking activity, encouraging men to reduce risky behaviour, and challenging gender inequalities that are driving the rapid spread of hIV and Aids. Over 116 young men have joined the forum so far



Position Statement: Institutional Response to GBV and Men’s Forum pledge


The launch of this position statement took place on 16 August, and various departments were involved in making it a success. This important statement aimed at the institution’s position and response to gender-based violence (GBV) on its campuses and at its campus residences. Its focus is on supporting survivors of GBV and holding perpetrators to account. Over 2 000 delegates attended the launch, including representatives from DhET, Department of Women, Department of health, Department of Arts & Culture, neighbouring institutions, NGOs and partners. The Men’s Forum was launched at the same event, where a pledge against GBV was presented. Following this launch, the GBV Policy was developed; this is expected to be approved before the end of 2019.

RESEARCH REPORT 2018 64
maraisme@cput.ac.za
Prof Chris Nhlapo with DhET Deputy Minister Mr Buti Manamela and representatives from CPuT and other tertiary institutions and government departments
Peer educators with Prof Chris Nhlapo and Mr Buti Manamela
ACADEMIC SUPPORT
Reading of the Men’s Forum Pledge
LGBTQI Dialogue
A dialogue with the LGBTQI (Lesbian, Gay, Bisexual, Transgender, Queer or Questioning, and Intersex) community took place on 18 August. Students and staff from CPuT and other universities in the Western Cape, community members from around the province, representatives of various structures working with the LGBTQI community took part, including the National Youth Development Agency, Access Chapter 2, Affirming & Inclusive Ministries, Gender Dynamix, and Free Gender NGO. Then-Minister Bathabile Dlamini from the Ministry of Women and various other speakers attended and contributed invaluable input to the discussions. In total, 143 participants attended the dialogue. Its purpose was to create a space and platform for engagement with different structures to establish the experiences, views and perspectives of different stakeholders on issues affecting the LGBTIQ+ Community, with the intention to influence interventions, policies, planning, budgeting and auditing.

Young Women Empowerment Conference
The 2018 conference was held in August, and over 250 young women from various local hEIs and TVET colleges attended. The main objective was to capacitate them through leadership development, entrepreneurship, reproductive health, self-acceptance and networking opportunities. Guests at the conference included representatives from the DhET, the Department of Women, the Department of health, the Department Arts & Culture, neighboring institutions, NGOs and partners.



Launch of the heForShe Campaign
During the month of October, the heForShe Campaign was launched at the Bellville Campus, where male students and staff pledged their support against GBV and their support for women empowerment. heForShe was established by uN Women and invites people across the world to work together as equal partners. On this day, male students and staff once again read the Men’s Forum Pledge against GBV.

Students stand up for gender equality
Male students were encouraged to speak out in support of gender equality at the launch of CPuT’s heForShe branch on the Bellville Campus in October. heForShe invites people around the world to stand together as equal partners to craft a shared vision of a gender equal world and implement specific, locally relevant solutions for the good of all of humanity. It was created by uN Women in 2014.
The HIV/Aids Unit’s Mr Naythan Kayser said CPUT was only the second South African university to launch a heForShe branch. “I’m really proud of you for coming out and I know that you will be the champions that you are already,” he told students. Acting Dean of Students, Ms Nonkosi Tyolwana, said events like these were crucial in helping people to speak out. “I call on you fellow sons, brothers, fathers, to pledge your support. Commit and don’t stay silent. Speak out in support of gender equality, academic equality and also against injustice. Your voice will make a difference in the lives of our CPuT community.”
Ms Agnes Phiri from uN Women said heForShe aimed to mobilise one billion men across the globe to accelerate the achievement of gender equality. She said since the launch
in 2014, hundreds of thousands of men had committed to gender equality.
The men at the event also recited the CPuT Men’s Forum Pledge. This forum aims to involve men in being part of the solution in the fight against gender-based violence. The forum, as well as CPuT’s Institutional Position Statement on Gender-Based Violence, was launched in August.
RESEARCH REPORT 2018 65
Students recite the CPuT Men’s Forum pledge during the heForShe branch launch
Student Counselling Ms Elisabet Smit

Student Counselling provides a comprehensive range of services to registered and prospective students. These services are provided at different levels of engagement, ranging from individual counselling and therapy sessions, to support groups, skills development workshops (aimed at the development of leadership skills, work preparedness skills and holistic well-being) and wellness promotion. The department’s core services include individual counselling and psychotherapy, career development, advocacy and learner support, skills development, a peer helper programme, research, community outreach, a wellness programme, student welfare, marketing and promotion, professional staff development, and the training and supervision of interns.

As part of their contact with students, the professional staff members regularly gather information on how students evaluate their services, through qualitative and quantitative
methods. The results are presented as either informal (annual reports and newsletters) or formal (workshops, journal articles, conference papers and poster presentations) research output. Several staff members have also engaged in personal research and presented the results in the form of conference papers and accredited journal articles. For example, Dr Charlene Petersen published ‘Reconstructing adolescent identity within the context of family violence’ in the Southern African Journal of Social Work and Social Development, and Mrs Estelle Wranz presented a prepared conceptual paper titled ‘PERMA: Cultivating a wellness culture’ at the SAACDhE Conference in September.
Research output
2018 PuBLICATIONS (SuBMITTED TO ThE DhET IN MAY 2019) uNITS
Journal articles (audited) 0.33



RESEARCH REPORT 2018 66
smite@cput.ac.za ACADEMIC SUPPORT
CPUT Research Focus Areas
The CPUT focus area programme is one of the outcomes of our ten-year strategy for research and innovation, as described in the Research and Technology Innovation (RTI) 10-year Blueprint of 2012.
In order to build critical mass and make effective use of limited resources, CPUT has resolved to develop clear areas of focus over a period of ten years. Our research, technology and innovation efforts and resources are concentrated on these focus areas. each of these areas provides a basis upon which research and innovation niche areas are developed within faculties, centres of excellence and units.
The choice of these focus areas and associated niche areas has been informed by
• CPUT’s strengths
• Areas likely to make the strongest contribution to strategic imperatives and national priorities
• A need to support a multidisciplinary approach to research and innovation
The seven focus areas identified in the RTI 10-year Blueprint are
1
BIO-eCONOmY & BIOTeChNOLOGY
2 sPACe sCIeNCe & TeChNOLOGY
3 eNeRGY
4 CLImAGe ChANGe & eNVIRONmeNT
5 hUmAN & sOCIAL DYNAmICs
6 eCONOmIC GROWTh & INTeRNATIONAL COmPeTITIVeNess
7 DesIGN FOR sUsTAINABILITY

67
BIO-eCONOmY & BIOTeChNOLOGY
Introduction by Prof Jeanine Marnewick

Biotechnology-based research and innovation at CPUT is guided by the objectives of our RTI Blueprint, and aims to contribute towards the south African Bio-economy strategy. This will be achieved through knowledge production that is aimed not only at benefiting our local and national communities, but also at supporting the growth and development of a global bio-economy. The goals of the south African Bio-economy strategy are to address health challenges; food nutrition and security; clean water; clean renewable energy with a reduced reliance on fossil fuels; a shift from a resource-based economy to a knowledge-based economy with sustainable resource management; and protection of our biodiversity. Through our research, we aim to enhance our strategic partnerships, facilitate knowledge exchange and capacity building, and stimulate socio-economic development in these target areas.
South Africa has vast natural resources and a wealth of indigenous knowledge. Biotechnology, as part of this focus area, will play a key role in the development of the ‘Farmer-toPharma’ value chain – developing bio-based products from these natural resources while ensuring that the rights of indigenous peoples are respected. The scope of our research is wide and entails several multidisciplinary niche areas.
Through these niche areas, we are addressing a number of of the the United Nation’s Strategic Development goals:
Goal 2 - Zero hunger
Goal 3 - Good health and wellbeing
Goal 5 - Gender equality
Goal 9 - Industry, innovation and infrastructure
Goal 12 - Responsible consumption and production
Goal 14 - Life under water (biodiversity management)
Goal 15 - Life on land (biodiversity management)
In addition, our niche areas are addressing the South African National Development Plan:
Chapter 3 - Economy and Employment
Chapter 10 - Promoting health
The niche areas that form part of this Focus Area include:
• Biocatalysis and enzyme production
• Biomarker development
• Chemoprevention
• Functional foods
• Mycotoxicology
• Nanotechnology

• Oxidative stress in health and disease development
• Phytochemistry & phytomedicine
• Proteomics
• Sport performance and supplementation
• Wastewater bioremediation and beneficiation
I NSTIT u TE OF B IO MEDICAL & M IC ROBIAL B IO TEC h NO LOGY ( IBMB) RESEARCH REPORT 2018 68
1 marnewickj@cput.ac.za
Institute of Biomedical & microbial Biotechnology (IBmB)
IBMB comprises several research entities and functions across various CPuT faculties:
• Oxidative Stress Research Centre
• Biocatalysis and Technical Biology Research Group
• Chemoprevention Research Group
• Mycotoxicology Research Group
• Proteomics Unit
• Animal Ethics Research Committee
The focus area and relevant niche areas within the IBMB are aligned to address CPuT’s 10-year Research, Technology Innovation & Partnerships (RTIP) Blueprint. The focus area: Bio-economy & Biotechnology is featured within the IBMB via the following niche areas:
• Biocatalysis and Actinomycete Biology
• Chemoprevention
• Mycotoxicology
• Oxidative Stress in Health and Disease Development
• Phytochemistry and Phytomedicine
• Proteomics
• Nanotechnology
• Water, Wastewater Bioremediation, Beneficiation and Quality (within the focus area: Climate Change & Environment)
The leader for CPuT’s Bio-economy & Biotechnology focus area, Prof JL Marnewick, also resides within the institute.
Mandate of IBMB
The IBMB’s mandate is to conduct world-class multidisciplinary research in biotechnology aimed at reducing health risks in South Africa associated with food and water safety, mycotoxicology, oxidative stress, community health and chemoprevention. The IBMB seeks to encourage the development of key scarce skills in areas such as biocatalysis and nanobiotechnology, in the realisation of South Africa’s bio-economy strategy.
Message from the Acting Chair: ProfJL Marnewick

Innovative research approaches form the basis of our institute. The dynamic nature of our scientists is key in developing specific niche areas which are envisaged to establish CPuT as a recognised leader in the field of biotechnology. 2018 marks another year where we have contributed towards securing funding and knowledge transfer as well as the postgraduate student experience. Of specific importance are our research activities that span across and beyond the borders of the university to strongly promote CPuT’s brand name through our research and community activities.
In summary, we produced 22 DhET-accredited articles and secured R2.8 million in external funds. We also successfully supervised five master’s studies, and are currently supervising 16 master’s and six PhDs from the CPuT community
marnewickj@cput.ac.za
RESEARCH REPORT 2018 69 BIO-ECONOMY & BIOTEC h NO LOGY 1
Prof JL Marnewick (Acting Chair)
A number of our scientists have acted as reviewers of manuscripts submitted to recognised scientific journals (also on the DhET’s list); been elected to serve on international editorial boards of various international journals, societies and councils; serve as expert advisors to national and international working groups; and serve as members
of various organising and/or scientific committees for local and international conferences. Our scientists also function as members of the Institutional Animal Ethics Committee, the Faculty of health & Wellness Science’s Faculty Research Committee and human Research Ethics Committee, the Senate Ethics Committee, and as members of the
Faculty of Applied Sciences’ Biotechnology Advisory Board. IBMB Scientists have also actively been involved in serving as institutional review panel members.
We are particularly proud of our researchers who have been newly rated and those who have retained and improved their NRF rating status. Congratulations!
degradation of the fumonisin mycotoxins during commercial dry milling of maize under experimental
conditions
M
African
degradation of lignocellulose by using expansins and enzymes –SYNDEX
JL
MarnewickCPuT
Oxidative stress in health and disease: A rooibos perspective
enhanced visible light photocatalysis
PJ
In situ testing of sustainable integrated systems for the treatment of winery wastewater at small wineries in the Western Cape
survey of filamentous bacterial populations in activated sludge
RESEARCH REPORT 2018 70 BIO-ECONOMY & BIOTEC h NO LOGY 1 I NSTIT u TE OF B IO MEDICAL & M IC ROBIAL B IO TEC h NO LOGY ( IBMB)
PRINCIPLE INVESTIGATOR FuNDER PROJECT TITLE TIME FRAME TOTAL IN RANDS Departmental Budget CPuT 2440 2018 834 008 Dr JF Alberts Maize TrustEnzymatic
2017-2019 750 000 Dr S Abel NRF Incentive Funding for
Researchers2017-2018 60 000 Dr h-M Burger Maize
2016-2018 840 000 Prof WCA GelderblomNRF Incentive Funding for Rated Researchers2016-2021 400 000 Prof WCA Gelderblom and Dr S Abel South
Rooibos Council The
2017-2019 367 080 Dr M Le Roes-hill NRF Synergistic
2017-2021 1 392 619 Dr
Lilly
2015-2018 900 000 Prof
2015-2019 5 000 000 Dr T MthethwaWRC Plasmon
2017-2019 343 000 Dr JP Rheeder NRF Incentive Funding for Rated Researchers 2018 50 000 Prof GS ShephardNRF Incentive Funding for Rated Researchers2016-2021 400 000 Dr PJ Welz Winetech
2017-2019 991 780 Dr PJ Welz WRC National
2015-2018 1 500 000 Dr
Welz WRC
O VERVIEW OF F u ND ED PR OJECTS 2018-2022 1 823 500
Rated
TrustFood safety in rural South Africa: Integrated strategies to reduce mycotoxin exposure
interactions between herbal tea polyphenols and fatty acids in the regulation of inflammatory responses during skin carcinogenesis
Maize TrustProteomic and transcriptomic analyses of molecular mechanisms associated with fumonisin production by Fusarium verticillioides MRC 826 in maize
Prestigious Project
Integrated biological system for concurrent wastewater treatment, solids reduction and resource recovery from tannery wastewater
Funding
Research output
New Research Chair: Biotechnology
The new Research Chair of CPuT’s Institute of Biomedical & Microbial Biotechnology (IBMB) plans to take the institute to the next level over the next five years. Prof Jeanine Marnewick is no stranger to the IBMB, having previously functioned as co-chair to Prof Wentzel Gelderblom. She also heads up the Oxidative Stress Research Centre in the Faculty of health & Wellness Sciences, and made headlines in 2011 when her clinical trial revealed that drinking six cups of rooibos per day held definite health benefits, specifically helping to reduce oxidative stress in the body and improving the cholesterol profile – all aspects that modulate the development of heart disease.

Prof Marnewick elaborated on the institute’s main focus this year. “The institute will be reviewed by international reviewers and with that, we will also devise the new business plan for the next five years,” she said. “We have to see that the research we are doing is correctly focused. Apart from our own RTI Blueprint, a big role player is the uN-driven sustainable development goals initiative. They recognise 17 goals as important for sustainability. We are aligning our research to these goals.”
Prof Marnewick feels strongly that the institute’s research should be able to be “applied and not just research for the sake of doing research – our communities have to benefit and that is our biggest driving force.”
The institute has six NRF-rated scientists, two of whom are B1-rated, and is encouraging all its researchers to obtain their rating, ensuring that postgraduate students have access to the best in the field.
“Our research output has also been very good over the past four years. We’ve had an average of about 20 journal articles per annum and conference attendance averaged about 15 national and 15 international conferences,” said Prof Marnewick. “We are always striving for a good balance, 1:1:1 between
national conferences, international conferences and publications. We’ve grown international collaborations significantly, including with institutions in hungary, France and Germany and the uS while we have established good relationships with local industry.”
For more on the IBMB visit http://www.cput.ac.za/ research-technology-and-innovation/centres/ibmb
RESEARCH REPORT 2018 71 BIO-ECONOMY & BIOTEC h NO LOGY 1
Conference funding (ConfCom) 34 737 Industry funding 1 886 811 National Research Foundation (NRF) 833 906 Research Exchange Programme (REP) 69 473 university Research Fund (uRF) 412 838 Total 3 237 765
2018 PuBLICATIONS (SuBMITTED TO ThE DhET IN MAY 2019) uNITS Conference proceedings (submitted) 0.20 Journal articles (audited) 7.81 Total 8.01
Prof Jeanine Marnewick
A. The Oxidative stress Research Centre (OsRC)
(Faculty of h ea lth & Wellness s ci ences)
http://www.cput.ac.za/academic/faculties/healthwellness/research/oxidative
The main aim of the OsRC is to contribute to existing knowledge regarding the role of oxidative stress in health promotion and disease development. It focuses on devising innovative strategies for the prevention of diseases associated with oxidative stress, with the ultimate goal of improving our population’s health status. emphasis is placed on the use of indigenous medicinal plants or derived phytochemical bio-actives to achieve this. The centre currently has four niche areas within the focus area of Bio-economy & Biotechnology. The year 2018 is our fifth as part of CPUT’s IBmB research institute. The partnership is a very fruitful one, providing access to new research expertise, collaborations and international exposure opportunities for our scientists and students.
OSRC Research Niche Areas:
(i) Oxidative Stress in h ea lth and Disease
Leader: Prof JL Mar newick
Our research focus is on elucidating the mechanisms involved in the development of certain lifestyle diseases in which oxidative stress plays a role, and on using the indigenous herbal tea rooibos as an innovative prevention strategy. In recognition of our research expertise, two of our members, Prof Marnewick and Dr Van der Westhuizen, served as expert advisors on an Eu-funded project, while further recognition was conferred by the local industry to Prof Marnewick when she was elected as Technical Advisor to the South African Rooibos Council.
highlights for 2018 include outputs stemming from our strategic partnerships within CPuT, with specific reference to the Faculty of Applied Sciences’ Department of Environmental health, with a multidisciplinary publication focussed on using oxidative stress biomarkers to assess environmental-induced damage within a specific marine organism, as a way to monitor the health of the relevant environment. Another collaborative project with Stellenbosch university resulted in a multidisciplinary publication exploring the use of grape polyphenols as anti-ageing intervention, highlighting the important role of the maintenance of a redox balance.
We were active on the research uptake front with an invited talk by Prof Marnewick to a number of representatives of Japanese beverage companies interested in the bio-activities of rooibos. She was also interviewed by Mr Jerome Garro, a French journalist based in Abidjan, on ‘The health promoting effects of rooibos: A heart advantage’ for a French television station, TF1, a major TV news programme in Europe. Stemming from the numerous research uptake contributions over the past five years, Prof Marnewick was selected as an official finalist for the National Science & Technology Forum (NSTF) Awards, the 2017/2018 NSTF-South32 Awards, in the category Communication for Outreach and Creating Awareness of SET and Innovation Award.
(ii) Biomarker Development
Leader: Dr Liana van der Westhuizen

The current focus of this niche area is integrated with the ‘Production of a rooibos-based product with enhanced antioxidant

RESEARCH REPORT 2018 72 BIO-ECONOMY & BIOTEC h NO LOGY 1 I NSTIT u TE OF B IO MEDICAL & M IC ROBIAL B IO TEC h NO LOGY ( IBMB)
R ese ARC h C e NT R e
capacity’ and the ‘Bioavailability’ projects within the CPuT Prestigious Project: Rooibos and heart health. Dr Van der Westhuizen has retained her C2 NRF rating. In continuation of the collaboration with Prof Melinda Kovács from Kaposvár University in Hungary on an EU GINOP mycotoxin exposure assessment and oxidative stress project, Mr Gábor Mihucz from the Mycotoxins in the Food Chain Research Group of Kaposvár University received training in laboratory oxidative stress analyses here at OSRC.
In terms of capacity building, Dr Van der Westhuizen successfully completed the DIES/CREST online training course for supervisors of doctoral candidates at African universities, presented by the Centre for Research on Science and Technology (CREST) at Stellenbosch university She is the co-chairperson of the Institutional Animal Ethics Committee and also serves on the Faculty of health & Wellness Sciences’ Research Ethics Committee. In these capacities, Dr Van der Westhuizen attended the Annual National health Research Ethics Council (NhREC) meeting for human and Animal Research Ethics Committees held at the National Department of health in Pretoria, and participated in the South African Association for Laboratory Animal Science Workshop on Animal Research Ethics Committee training held at Onderstepoort in Pretoria.
(iii) Phytomedicine and Phytochemistry
Leader: Prof OO Oguntibeju

The members of this research group are Prof Oluwafemi Oguntibeju (leader), Dr Nicole Brooks and Mr Wonga Pantsi. The focus covers medicinal plants, diabetes and reproductive health (phytomedicine). Our research group has contributed significantly to knowledge generation, research growth and capacity building at CPuT
Diabetes presents challenging health problems for people in South Africa and also Africa as a whole. This has prompted the exploration of the vast reserves of medicinal plants such as Garcinia kola, Moringa species and other plants for their anti-diabetic, anti-inflammatory, antioxidant, antigenotoxic hepatoprotective and reproductive activities. These plants could possibly be effective in the treatment of diabetes and its complications.
During 2018, group members published four scientific publications in DhET-accredited journals as well as four book chapters. Six further journal articles were accepted for submission to the DhET. Our researchers participated in six conference presentations and two scientific visits. Ten manuscripts are under review by various journals. One master’s student and two doctoral students completed their research work in 2018. Currently, eight doctoral and six master’s students are registered and conducting their research activities in our research group.
(iv) Experimental Biology
Leader: Dr Dirk Bester
Focused specifically on cardiovascular health, our research studies involve mostly dietary supplementation with potential medicinal plants such as red palm oil, buriti oil, rooibos, and extracts of kolaviron, using experimental animal models and measuring cardiac function and biochemistry. This includes signalling pathways, such as PKB/Akt, MAP-kinases and oxidative stress markers. highlights for 2018 include the publication of a paper from the kolaviron project in Drug Research. Manuscripts from the buriti oil and rooibos projects are in preparation to be submitted for publication.

RESEARCH REPORT 2018 73 BIO-ECONOMY & BIOTEC h NO LOGY 1
B. The Biocatalysis & Technical Biology Research Group (BTB)
Leader: Dr M Le Roes-Hill
The year 2018 was once again a very productive one for the Biocatalysis & Technical Biology (BTB) Research Group. members of the various research niche areas were successful in sourcing research funds, research uptake took place, and international ties were strengthened. As in 2017, there were three main research niche areas: Actinobacteria, oxidative enzymes and biocatalysis (Leader: Dr m Le Roes-hill), Nanotechnology (Leader: Dr T mthethwa), as well as Wastewater bioremediation and beneficiation (Leader: Dr PJ Welz).
BTB Research Niche Areas:
(i) Actinobacteria, Oxidative Enzymes an d Biocatalysis
Leader: Dr M Le Roes-Hill
In 2018, Dr Le Roes-hill was involved in various activities. In February, a highly successful joint workshop for three of the twelve national DST/NRF-funded SA-Germany bilateral projects (NOVBIOSuRF, SLAC, and SYNDEX) took place at CPuT’s Granger Bay Campus. The workshop was organised and hosted by Dr Le Roes-Hill and co-hosted by Prof T Kudanga of Durban university of Technology (DuT). Researchers from the Technical university of Munich (TuM), Fraunhofer Institute IGB (Straubing branch), the university of Stuttgart (uST), and the university of hohenheim joined their South African research partners and collaborators for this three-day workshop. Local universities represented included CPuT, DuT, Rhodes, Stellenbosch and uWC.

Dr Le Roes-hill also hosted a range of international students for completion of their studies (mostly linked to the DST/NRF SAGermany bilateral project): Mr Gerassimos Kolaitis (TUM) visited for three months; Mr Alexis Murat (université Paris-Est Créteil, uPEC) visited for ten weeks; Ms Maike Gräff (uST) for ten days, and Ms Rima Maibeche (university of Bejaia, Algeria) for three months. Dr Le Roes-hill also visited the laboratories of Prof Boucherba Nawal at the university of Bejaia, Algeria in September.
This year, Dr Le Roes-hill continued to work closely with CPuT’s Faculty of health & Wellness Sciences and was involved in the revision of the Terms of Reference and Standard Operating Procedures of the health & Wellness Sciences’ Research Ethics Committee. She also had a strategic meeting with Mr Molati Nonyane, a representative of ACGT and the Department of Science & Technology (DST) to discuss the DST’s plan to develop a metagenomics flagship programme, which will ultimately allow for the networking of South African researchers involved in metagenomics studies. This was also in light of the new NRF grant that she was awarded: A Marine and coastal research grant to explore the biosynthetic potential of actinobacteria found in marine sediments, their role in the environment (metatranscriptomics) and an analysis of their contribution to the overall microbial population found in these sediments (metagenomics) (R2 400 000).
RESEARCH REPORT 2018 74 BIO-ECONOMY & BIOTEC h NO LOGY 1 I NSTIT u TE OF B IO MEDICAL & M IC ROBIAL B IO TEC h NO LOGY ( IBMB)
Dr Le Roes-hill graduated four students in 2018: Mr B Nemadziva – MSc Applied: Biotechnology, DuT; Mr E Mabande – MSc: Pharmaceutical Sciences, UWC; Mr G Kolaitis – MSc: Biotechnology, TUM; and Mr T harris – MTech: Food Technology, CPuT cum laude. She also coauthored seven publications and a book chapter, and presented her research at two prestigious conferences: Bergey’s International Society for Microbial Systematics (oral presentation in Muldersdrift in April) and the 9th International Congress on Biocatalysis – Biocat (oral presentation and co-author on two posters in hamburg, Germany in August).

(ii) Nanotechnology
Leader: Dr T Mthethwa
In 2018, Dr Mthethwa hosted a reference group meeting for the Water Research Commission (WRC) of South Africa funded project: ‘Design of the efficient plasmon assisted semiconductor photocatalysts and their application in visible photocatalytic wastewater treatment’. She reviewed a number of research proposals for WRC in 2018 and also took part as a reference group member for the WRC project ‘Electrochemical unit operations in industrial wastewater treatment: The development of electrocoagulation and photo-electrochemical oxidation reactors based on novel nanocomposite electrodes’ in Pretoria.
Dr Mthethwa has also received NRF Thuthuka funding for 2019 for a project titled ‘Material design and photocatalytic treatment of textile dyes’. This funding came with two grant holder linked bursaries for BTech and master’s students. As part of staff development, Dr Mthethwa attended a workshop on academic career research planning at CPuT

(iii) Wastewater bioremediation and beneficiation
Leader: Dr PJ Welz

A number of postgraduate students from the Engineering & the Built Environment and Applied Sciences faculties are involved in this research niche area. Research projects range from bioremediation of domestic, industrial and agro-industrial effluent, to anaerobic digestion of different forms wastewater sludge.
Funding for research activities and student bursaries in 2018 was provided by the Water Research Commission (WRC) and Winetech: WRC Project K5/2471/3 ‘National survey of filamentous bacterial populations in activated sludge’ (R1 500 000), WRC project K5/2841/3 ‘Integrated biological system for concurrent wastewater treatment, solids reduction and resource recovery from tannery wastewater’ (R1 823 500), and Winetech project ‘In situ testing of sustainable integrated systems for the treatment of winery wastewater at small wineries in the Western Cape’ (R913 000). CPuT’s ConfCom supplemented funding for congress attendance.
Four manuscripts were published in inter national DhET-accredited peerreviewed journals in 2018, and two students graduated with MEng (Chemical Engineering) degrees, Mr A Ndobeni and
RESEARCH REPORT 2018 75 BIO-ECONOMY & BIOTEC h NO LOGY 1
Mr A Mpofu (cum laude). Dr Welz served as a reference group member on four WRC Projects. Collectively, Dr Welz and the students delivered ten oral presentations at five international and two local congresses, including the International Water Association World Water Congress and Exhibition in Tokyo (Mr G holtman), the 7th Inter national Congress on Engineering for Waste and Biomass Valorisation in Prague (Mr W Ngoie and Mr A Mpofu), the South African Society for Microbiology Congress in Krugersdorp (Dr PJ Welz), and the Water Institute of South Africa congress in Cape Town (Mr G holtman), where a further three students also presented posters.
Mr W Ngoie (DEng candidate in Chemical Engineering) received the best poster award at the DSTunesco Engineering Conference at CPuT for his presentation titled ‘Mineral processing wastes and edible oil wastewater sludge, towards sustainable resources recovery’. Amongst a number of other research activities, Dr PJ Welz, Prof OO Oyekola (Chemical Engineering) and postgraduate students (Mr A Mpofu, Mr A Ndobeni, Ms V Kibangou and Ms E Horne) visited an industry partner, the Southern Cape Ostrich Tannery in Mossel Bay. This visit provided the students with invaluable insight into the industry on which their research projects are based.
The main academic collaborators during 2018 were Prof OO Oyekola (Chemical Engineering), Prof R haldenwang (Civil Engineering), Dr M Lilly and Dr M le Roes hill (IBMB), and Dr C uys (CPGS). Exter nal collaborators included Dr JB Ramond (university of Pretoria), Dr R van hille (Disa Scientific), Mr N van Blerk (East Rand Water Care Company), Dr S Kumari (DUT), Dr N De Jongh (University of Aalborg) and Ms N Meyer (university of Alberta).
Research project workshop a great success
CPuT hosted a successful workshop for South African and German researchers collaborating on three bilateral research projects. NOVBIOSuRF, SLAC, and SYNDEX, were among 12 South Africa–Germany bilateral research projects launched last year. Their focus ranged from topics such as wastewater, to the production of new compounds, and mainly aimed to allow for the exchange, training and development of young researchers and PhD-level students.
The three-day event was held in February at the Granger Bay Campus’ hotel School, and encouraged the exchange of ideas and the development of new collaborations and networks. It was organised and hosted by Dr Marilize Le Roeshill, head of the Biocatalysis & Technical Biology Research Group in CPuT’s IBMB research institute. The workshop was co-hosted by Prof Tukayi Kudanga from the Department of Biotechnology &

Food Technology at DuT. The guest speaker was Prof Emile van Zyl from Stellenbosch university, who presented on the lessons learned from working in the ‘bioethanol production’ and ‘enzyme expression in yeast’ space. Progress on each of the three research projects was presented during the course of the workshop.
“To all of those who attended the workshop, which also included other researchers and students from CPuT, DuT and uWC, it was a great success, allowing for the free exchange of ideas and the stimulation of in-depth discussions. Potentially new collaborations were established and the workshop team as a whole, are looking forward to future joint workshop meetings,” said Dr Le Roes-hill.
The projects were jointly funded by the DST (South Africa) and the German Federal Ministry of Education Research.
RESEARCH REPORT 2018 76 BIO-ECONOMY & BIOTEC h NO LOGY 1 I NSTIT u TE OF B IO MEDICAL & M IC ROBIAL B IO TEC h NO LOGY ( IBMB)
South African and German participants at the hotel School
C. Chemoprevention and mycotoxicology Research Group
Research Niche Areas:
i) Chemoprevention Leader: Dr S Abel
This group focused specifically on growing its strategic partnerships with both local and international leaders in their fields. In terms of local activities, collaboration with Prof Marina Rautenbach (Department of Biochemistry, Su) on lipidomics progressed well. Dr Celeste Abrahams, postdoctoral fellow within this group will co-ordinate with Su on standardising lipid extraction methods between the two laboratories (Su and CPuT). Collaboration with the newly established Proteomics unit under Dr Mariska Lilly was strengthened, utilising bioinformatics to analyse proteomics and super-array data derived from keratinocyte cell cultures treated with herbal tea extracts.

Prof WCA Gelderblom and Dr S Abel attended a meeting with Dr C Muller, Mr K van der Merwe and Mr T Swart at the Dundonald farm near Swellendam, on continued collaboration regarding research on Fleckvieh milk, particularly with reference to conjugated linoleic acid and its potential health properties. Another postdoctoral fellow from this group, Dr S Samodien, assisted a Grade 11 pupil, Ms Bashierah Omer, from Norman henshilwood high School with job shadowing at the MCRG. This formed part of the pupils’ Life Orientation curriculum to engage in a Work Shadow Programme through which they are exposed to the world of work via lessons, research projects and work placement in a career of their choice. Ms Omer was introduced to cell culturing techniques, certain assays and the interpretation of the results.
From further abroad, the research group also hosted three students from the université Paris-Est Créteil (uPEC, Paris), for their annual ten-week inter nship at our institute. Two CPuT postdoctoral fellows and one PhD student within the group supervised them. Links were established with Prof Damien Destouches (uPEC, Research Laboratory of Cell Growth, Tissue Repair and Regeneration) regarding international research collaboration on utilising lipidomics to determine lipids in prostate cancer cells and exosomes.
Three manuscripts were published in 2018.
(ii) Mycotoxicology Leader: Dr JF Alberts

The Mycotoxicology Research Group published nine papers in international scientific journals as first and/or corresponding authors during 2018. Prof GS Shephard and Dr JF Alberts were invited speakers at various prestigious international conferences, including the Max Rubner Conference on Fungi and Mycotoxins in Food and the International Conference of the World Nutrition Forum. Prof Shephard served on several international committees on setting safe regulatory mycotoxin levels in food intended for human consumption in Africa.
The group is also actively involved as project leaders and collaborators in international collaborative projects (Enzymatic reduction of fumonisins in maize; Phylogenetic characterisation of Fusarium strains; mycological/mycotoxin surveillance studies in northern Namibia; and Computational predictive climate change models) with BIOMIN in Austria; the united States Department of Agriculture (uSDA); the university of Namibia; and the university Cattolica Del Sacro Cuore in Italy.
Our researchers have played an important role in the establishment and validation of advanced analytical methods (i.e. multiple mycotoxin urinary biomarker LC-MS method, and multiple mycotoxin LC-MS analyses from maize)
RESEARCH REPORT 2018 77 BIO-ECONOMY & BIOTEC h NO LOGY 1
in South African analytical laboratories; the determination of human exposure of rural communities to mycotoxins in their dietary staples; and the development of mycotoxin reduction strategies. Two field studies were conducted in subsistence farming communities: (i) in the Eastern Cape (Dr h-M Burger) and (ii) in the Oshana region of northern Namibia (Dr JP Rheeder). These studies address the relationship between mycotoxin exposure and infant/young child growth in rural areas of the Eastern Cape, and food safety concerns in northern Namibia, respectively. Dr Burger contributed as a key role-player in CPuT’s ethical committee matters and the compilation of a series of ethical research policies. Our researchers also held positions on several international scientific societies, boards and committees.
(iii) Proteomics Platform
Leader: Dr M Lilly
The main aim of this platform is to develop proteomic research (within the IBMB) as an important niche focus area at CPuT, thereby contributing to South Africa’s bio-economy drive. In 2018, the Proteomics Platform expanded its national and international collaborations on existing and new projects. Projects include the investigation of molecular mechanisms of fumonisin biosynthesis by F. verticillioides with studies including the proteomic and transcriptomic analyses on the molecular mechanisms of fumonisin B production by F. verticillioides MRC 826 as well as molecular analyses of F. verticillioides MRC 826 subculture strains and a new project on ‘The investigations on Fusarium verticillioides-maize interactions related to fumonisin production under drought stress conditions: A proteomic and selected metabolomics approach’.
Collaboration also includes projects on a proteomic and selected transcriptomic assessment of the chemoprevention properties of rooibos and honeybush herbal teas against uVB-induced skin damage and determining the chemopreventive effect of polyunsaturated fatty acids of the n-6 and n-3 families by utilising proteomic and lipodomic assessment methods. Bioinformatic collaborations with the Institute of Infectious Diseases and Molecular Medicine, Proteomics Laboratory at uCT and the Department of Microbiology and CBCB (Centre for Bioinformatics and Computational Biology) at Su were also strengthened.
International collaborations include Dr Rh Proctor and Dr M Vaughan at the uSA’s Department of Agriculture’s Agriculture Research Service on whole genome expression analyses of different strains of F. verticillioides. Dr Lilly also received the Erasmus+ staff mobility grant from université Paris-Est Créteil Val de Marne (uPEC) for staff teaching assignment within the framework of Erasmus+ international credit mobility programme and lectured at the university in Paris, specifically on research topics ‘Fusarium and mycotoxins’ and ‘Polyphenols and herbal teas’. Two international students from université Laval and university of Paris (uPEC) in France also completed their internships under the supervision of Dr Lilly.
Other highlights include (i) Dr M Lilly attended the 10th MaxQuant Summer School in Barcelona on Computational Mass SpectrometryBased Proteomics, as well as the Global Conference on Plant Science and Molecular Biology in Rome. She also gave an oral presentation on ‘Comparative proteomic analyses of two clonal Fusarium verticillioides MRC 826 strains with varying fumonisin biosynthetic potential in maize cultures’; (ii) Dr Lilly received a SABINA travel grant and together with Prof WCA Gelderblom visited the university of the North-West (Potchefstroom) and the university of Johannesburg to establish new research collaborations within the SABINA network regarding omics research; (iii) Dr Lilly also co-authored a paper titled ‘Differential modulation of gene expression encoding hepatic and renal xenobiotic metabolising enzymes by an aspalathin-enriched rooibos extract and aspalathin’, which was published in Planta Medica; (iv) A business plan for the newly established proteomics unit has been submitted to the different faculties within CPuT;
(v) Dr Lilly serves as an advisory board member for the Biotechnology programme in the Faculty of Applied Science.

RESEARCH REPORT 2018 78 BIO-ECONOMY & BIOTEC h NO LOGY 1 I NSTIT u TE OF B IO MEDICAL & M IC ROBIAL B IO TEC h NO LOGY ( IBMB)
D. Animal ethics Committee (AeC)


Chairperson: Dr D Bester
Co-chairperson: Dr L van der Westhuizen


CPuT’s AEC is located within the IBMB. The committee was approved by Senate in 2015. Since then, the AEC has embarked on the journey to comply with all relevant regulations and laws in order to be accredited by the National health Research Ethics Council (NhREC). In 2018, the AEC received substantially more applications for ethics review, from both staff and student researchers, than in previous years. This resulted in the first ethics approval letter being issued in 2018. The AEC was also involved in developing a CPuT position statement regarding new South African Veterinary Council regulations in this year.

BIO-ECONOMY & BIOTEC h NO LOGY 1 RESEARCH REPORT 2018 79
BIO-ECONOMY & BIOTEC h NO LOGY 1
Te C h NOLOGY sTATION
Agrifood Technology station
he ALT h & W e LL N es s sC I e NC es
The Agrifood Technology station (ATs) is a platform that provides a range of interdisciplinary technological services to the agrifood sector, focusing on existing smaller and medium enterprises, with a view to improving competitiveness, innovation, and research and development capacity in a sustainable manner. It is funded by the TIA initiative of the DsT. This technology station is located on the Bellville Campus, and includes a pilot plant with various processing areas, general and cold stores, and a number of laboratories.
highlights of 2018
Mr Larry Dolley dolleyl@cput.ac.zaa

The ATS conducts its work against a Service Level Agreement with the TIA. During 2018, as opposed to the previous two years, good progress was made toward meeting targets in terms of number of SMMEs, service, training conducted, product and process improvement effected, and also new product development.
During the financial year, a number of funded projects were allocated to the station. The first was a DST-funded project (R680 000) for the establishment and running of an Indigenous Knowledge Systems Documentation Centre (IKSDC) hosted in the station. The setting up of the system is in progress and will match other such centres at other institutions in each province. This is an annually renewable project and it is trusted that information collected will benefit the owners of such indigenous knowledge.
TIA had also allocated R310 000 to ATS together with an SMME (Gourmet Grubb) toward the development and commercialisation of an insect-based ice cream. In this instance, larvae of Black Soldier Flies are used to produce a milk as primary product and then convert this to an ice cream or gelato. Presently, the larvae are being used for animal consumption. Significant progress has been made and the intention is then to follow this up with nutritious products aimed at lower LSM categories. This insect contains good quality protein and fats.
ChEC awarded the station with R65 156 toward the development of a framework for establishing and using a Grey Knowledge Database. In essence, this relates to listing recently retired food industry professionals toward using their skills and knowledge to assist SMMEs in the agro-processing sector in the Western Cape. This project has been concluded with the involvement of the Provincial Government of the Western Cape. It is expected that this database will grow with time and that it will eventually be converted to a web-based access system.
RESEARCH REPORT 2018 80 BIO-ECONOMY & BIOTEC h NO LOGY 1 I NSTIT u TE OF B IO MEDICAL & M IC ROBIAL B IO TEC h NO LOGY ( IBMB)
FACULTY OF
A number of projects initiated by ATS with SMMEs have been converted to postgraduate studies in Food Science & Technology and in Analytical Chemistry. Examples of this are a research project using kelp as a raw material for food products together with an SMME (CMD Industries). At present, this is a joint project with ThRIP funding from the DTI. Other parties involved in the project are CMD Industries itself, Stellenbosch university, ATS and CPuT’s Food Science & Technology Department. A number of postgraduate studies are taking place under this project. It involves a biorefinery concept with analysis and utilisation of the components extracted.

As part of its strategic planning, the unit has partnered with an SMME. The company concerned, Fruity Flair, has placed a bottling line in the pilot plant for an indefinite period and at no cost to CPuT. Considering that a number of beverage-based projects are in progress, this addition to the total array of equipment is considered to be extremely valuable.
As part of its mandate to encourage entrepreneurship and innovation, ATS is partnering with alumni and existing graduate students and other young people to establish businesses based on their product ideas. Presently, this involves a ginger beer with a modified production process, baked products with enhanced nutritional value, and the production of kombucha as well as another health drink. This goes hand in hand with ATS being involved with the capstone new product development project run by Food Science & Technology via assistance with analysis and training.
Future developments include the establishment and certification of the station with ISO 9001:2015. Another project with Food Science & Technology includes that of equipping the microbrewery with an array of sensors way beyond those that a standard brewery would have. This will allow the research conducted in this field to generate significant data toward controlling the process.
Based on all these activities, and those yet to be announced, ATS faces 2019 with enthusiasm.

BIO-ECONOMY & BIOTEC h NO LOGY 1 RESEARCH REPORT 2018 81
Bioresource engineering Research Group
FACULTY OF APPLIeD sCIeNCes
Prof Karabo S Ntwampe
ntwampes@cput.ac.za
This year, the Bioresource engineering Research Group celebrated its 9th birthday with an increase in its number of outputs. This most productive year in the history of the research group included:
- Delivery of 20 oral presentations at the 10th International Conference on Advances in Science, Engineering, Technology & healthcare (ASETh-18) in Cape Town
- A visit to Zagreb, Croatia, where five presentations were delivered at the meeting of the International Water Association Young Water Professionals
- A visit to Salerno, Italy, where an oral presentation ‘Diversity and performance of sulphate reducing bacteria in acid mine drainage remediation systems’ was delivered
Collaborations with the NWu’s Water Pollution Monitoring and Remediation Initiatives Research Group and uCT’s CeBER, led to a further two oral presentations in Zambia and Namibia for the 19th WaterNet/WARFSA/GWP-SA Symposium and the Sustainable Minerals ’18: Towards a Circular Economy, respectively

Funding secured included the NRF’s Equipment-related Travel and Training and the Knowledge Interchange and Collaboration (KIC) mobility grants to host a scientist. Furthermore, 2018 was also the final year in which the research group received the Research and Technology Fund for Patulin Detection and Treatment in collaboration with a local SMME/juice producing company. The project led to one of the research group postgraduate students receiving a second master’s degree, in nanoscience and molecular nanotechnology, during an upskilling exchange programme for a thesis titled ‘Remediation of patulin by adsorption and heterogenous Fenton oxidation using (CE)nZVI’ from the of university of Alicante, Spain. This resulted in a visit to South Africa by Prof Andrès Fullana Font, director of the upskilling programme and the thesis.
The research group graduated the largest group of females in a cohort – seven female students received their master’s degrees either with cum laude or summa cum laude, with one being as a result of collaborative work with colleagues at the university of Ghana.
The year was also the first year in which a paper was produced as a result of collaboration between the research group and colleagues in the following institutions: university of Douala in Cameroon, Nelson Mandela African Institution of Science and Technology in Tanzania, hohai university in China, university of Zimbabwe, and university of Göttingen in Germany, as a strategy to achieve an international footprint.
RESEARCH REPORT 2018 82 BIO-ECONOMY & BIOTEC h NO LOGY 1 I NSTIT u TE OF B IO MEDICAL & M IC ROBIAL B IO TEC h NO LOGY ( IBMB)
-
R ese ARC h e NT ITY
highlights of 2018
• Ms Melody Mukandi was among the first to receive the Mwalimu Nyerere African union Scholarship for 2018, a scholarship aimed at female applicants for master’s and doctoral programmes
• The research group hosted a SUMO (full featured wastewater process simulator software) workshop/ training session conducted by Dr Szabolcs Szilveszter, of Sapientia hungarian university of Transylvania in Romania, who is a specialist in the area of anaerobic digestion in wastewater treatment plants
• The research group hosted Dr Sandis Dejus of the Riga Technical university in Riga through the Erasmus+ & Teaching Staff Mobility Grant
• The first graduate of the research group in 2010, Dr Moses Basitere, received his doctorate in Chemical Engineering this year

Students in the spotlight 2018
1) Yasheemah Williams from Cape Town was awarded her master’s degree in Chemical Engineering summa cum laude, having completed her studies in one and a half years, with rearch into the treatment of poultry slaughterhouse wastewater. She has written, presented and been part of numerous conference manuscripts. She is currently lecturing at CPuT as a mathematics lecturer in FID.
2) Zainab Rinquest from Athlone in the Western Cape was awarded her master’s degree in Chemical Engineering cum laude. Research from her study on the treatment of poultry slaughterhouse wastewater was presented at the 8th International Young Water Professionals Conference (IYWPC) in 2017 and published in the Journal of Water Process Engineering (CiteScore = 4.00). She intends to pursue her DEng degree in Chemical Engineering in the near future.
3) Melody Ruvimbo Mukandi, born in harare, was awarded her master’s degree in Chemical Engineering cum laude, having completed the degree in record time, with research into the treatment of poultry slaughterhouse wastewater through modelling. Currently she is pursuing her DEng degree in Chemical Engineering with the hope of finishing her studies before the age of 30. Melody is also one of the first awardees of the Mwalimu Nyerere Scholarship at CPuT.

RESEARCH REPORT 2018 83 BIO-ECONOMY & BIOTEC h NO LOGY 1
Prof Ntwampe, Prof Basitere and Prof Sheldon
At the Athlone Wastewater Treatment Works with Dr Szabolcs Szilveszter and Dr Sandis Dejus
Cardiometabolic health
Research Unit
FACULTY OF heALTh & WeLLNess sCIeNCes
The mission of the Cardiometabolic health Research Unit is to create an environment for groundbreaking cardiometabolic disease research.
In this unit, a team of researchers collaborates to provide an integrated research programme focusing on obesity, cardiovascular risk, metabolic syndrome, chronic kidney diseases and diabetes, all with respect to inflammation, genetic, epigenetic and oxidative mechanisms. The unit strives to use optimal research tools to achieve excellent, accurate results that can be translated to healthy lifestyles, early diagnosis, and cost-effective prevention and management of these diseases. Much of the group’s work comprises community-based studies, specifically the Cape Town suburb of Bellville South, including ‘The Bellville South Africa Study’.
Prof Tandi Matsha

matshat@cput.ac.za
The Cardiometabolic health Research unit is a research facility that includes infrastructure such as a laboratory, rooms for clinical examinations and oral health assessments of participants, and work space for research fellows and graduate students. It provides researchers with much needed characterised cohorts and biobanks to carry out novel and technologically advanced research.
Our spectrum of research is broad, covering epidemiology to discovery-based laboratory science. Much of the work is interdisciplinary, integrating with the following research entities: the Department of Dentistry, uWC; the Non-Communicable Diseases Research unit (NCDRu), SAMRC; the Department of Pathology, Su; the Department Interdisciplinary health Sciences, Su; and the South African National Bioinformatics Institute, uWC International collaborations include the Centre for Cardiovascular Genetics at the British heart Foundation Laboratories; the Institute of Cardiovascular Science at university College in London; the Department of Pathology and Molecular Medicine at McMaster university in Canada; and the Institute for Clinical Chemistry, Mannheim university in Germany.
The research unit is involved in studying phenomena such as periodontal disease, immune activation, hepatic steatosis, vitamin D deficiency and insufficiency, pollution, and genetic and epigenetic novel risk factors for cardiometabolic traits in mixed ancestry South Africans. This research is funded by the South African Medical Research Council, the NRF and CPuT.
Major achievements during 2018 include the DST-NRF-Nedbank SARChI Chair being awarded to Prof Matsha, and the graduation of three master’s fellows. The unit published 11 manuscripts and members of the group presented research findings at various international conferences.
RESEARCH REPORT 2018 84 BIO-ECONOMY & BIOTEC h NO LOGY 1 I NSTIT u TE OF B IO MEDICAL & M IC ROBIAL B IO TEC h NO LOGY ( IBMB)
R ese ARC h e NT ITY
The South African Research Chairs Initiative (SARChI) was established in 2006 by the DST and the NRF. The main goal of the Research Chairs initiative is to strengthen and improve the research and innovation capacity of public universities for producing high-quality postgraduate students and research and innovation output.

The head of the Biomedical Sciences Department was awarded the prestigious accolade of the SARChI Research Chair in Cardiometabolic health in April. Prof Tandi Matsha, the founder and lead researcher of CPuT’s Cardiometabolic health Research unit, is the first recipient of a SARChI Research Chair in the Faculty of health & Wellness Sciences. Prof Matsha said she felt privileged to have been recognised. her current research focuses on diabetes and cardiovascular risk in the coloured community of Bellville South, which, she said, was being expanded to include other population groups.

Prof Matsha said the highlight of her career up until this point was when she was awarded a R8.3 million research grant in 2013 from the Medical Research Council’s (MRC) Flagship Project followed by a grant of more than R6 million in 2016 from the MRC’s Strategic Initiatives. “This was important
as it has allowed our unit to do the research we’re doing,” she said.
The Acting Dean of the Faculty & health and Wellness Sciences, Prof Penelope Engel-hills, said Prof Matsha had worked tirelessly over a number of years to develop the research unit.
“The research area aligns with the uN’s Sustainable Development Goal Number 3: Good health and Well-being,” she said. “Through this award, Prof Matsha and her team have been acknowledged for their potential to make a significant contribution to the production of new knowledge in a field that is of great importance to the well-being of individuals and that will impact on the public health agenda internationally.”
She added that Prof Matsha has created a research environment where postgraduate students from a number of disciplines could be successful. “We look forward to a growing number of master’s and doctoral students and post-docs being exposed to good research practice in her research unit.”
Over the past five years, the Cardiometabolic Research unit has maintained a publication average of 10.5 units per year, and the faculty anticipates that the award offered the opportunity to maintain and escalate this average, as the number of publications and scholarly research output would increase.

RESEARCH REPORT 2018
Prof Tandi Matsha awarded SARChI Research Chair
BIO-ECONOMY & BIOTEC h NO LOGY 1
Prof Tandi Matsha is the first NRF SARChI Research Chair in the Faculty of health & Wellness Sciences
environmental Chemistry, Toxicology & Remediation FACULTY OF APPLIeD sCIeNCes
The focus of this niche area embraces the themes of chemical and biological assessment and monitoring, the development of remediation techniques to address the problem of environmental pollution and management, as well as environmental and human health risk assessment. The assessment and monitoring research projects focus on the identification, characterisation, monitoring and effects of chemical (inorganic and organic) and microbial pollutants in the environment. The remediation research projects focus on the development of appropriate techniques to remediate and manage polluted sites. An additional component in this niche area deals with the communication of research findings to the general public and the different levels of government in south Africa.
Prof James Odendaal odendaalj@cput.ac.za
The aim is to contribute to the development of environmental policy, legislation, and environmental guidelines and standards for South Africa. This research group has a number of research projects which are led by staff members. Postgraduate students at master’s and doctoral levels also participate in the group’s research activities. Investigations into a host of environmental pollutants take place in coastal, riverine and terrestrial environments. Topics for these studies include a variety of subjects ranging from, for example, the effects of metal pollutants on invertebrate communities in a river system to the use of sentinel organisms to assess the health of metal contaminated forest pockets in the Western Cape.

RESEARCH REPORT 2018 86 BIO-ECONOMY & BIOTEC h NO LOGY 1 I NSTIT u TE OF B IO MEDICAL & M IC ROBIAL B IO TEC h NO LOGY ( IBMB)
R ese ARC h e NT ITY
Functional Foods Research Unit
FACULTY OF APPLIeD sCIeNCes
The Functional Foods Research Unit (FFRU) is pleased to report the following highlights for 2018:
Student supervision
During 2018, three MTech students were supervised by FFRu staff members.
Omega Caro-E
Batch sales of Omega Caro-E capsules from 2013 to present, amounting to R2 380 000 in revenue, will be paid into Research and Innovation Fund of this unit. We are pleased with the successful commercialisation of Omega Caro-E. This stream of income has now been terminated with the licensing of the product to Sozo Foods (Pty) Ltd in 2018.
oppermanm@cput.ac.za
External income
Technology Innovation Agency (TIA) seed fund grant 2016-2018 –R493 000
Awaiting feedback from TIA regarding another seed fund grant applied for in December 2018 –R650 000
FFRU laboratory income
Prof Spinney Benade was in charge of the laboratory and analytical procedures up until April, when he sadly passed away. The income for 2018 was ±R15 000 – the figure has seen a decline due to his passing. We are looking for additional projects of laboratory income during 2019.
Further education and training
Prof Marietta Opperman is currently studying towards her Master of Business Administration (MBA) 2017-2019 through Stellenbosch university’s Business School.
Research & business collaboration
• Development of a fortified milk beverage to supplement the
diet of toddlers and pre-school children, together with the Department of Biotechnology & Consumer Science and the Department of Food Science & Technology
• Clinical trial on the consumption of street food among taxi drivers at selected locations around Cape Town, their metabolic profile and concomitant blood omega-3 fatty acid, carotenoid and vitamin E statuses, together with the School of Public health, uWC (continuing into 2019)
• Licensing agreements in progress on collaboration with Freshsoil Foods for new product development involving fish oil and turmeric (continuing into 2019)
Committees
Internally, Prof Opperman is a member of CPuT’s Senate. Externally, she is a member of the Complimentary Medicines Committee of the South African health Product Regulatory Authority (SAhPRA) (October 2014-present), as well as Branch Chair of the Western Cape branch of the Nutrition Society of South Africa.

Additional responsibilities
Prof Opperman is currently the head of the FFRu, and in charge of the administration and budgets of this unit. In addition, she is an internal moderator for the subjects Nutrition 3, Nutrition 4, Food and Nutrition Project 4, and in charge of general administration of the Consumer Science Programme at the Bellville Campus (with a focus on postgraduate students). She is also involved with the selection of and communication with prospective Advanced Diploma, PGDip and master’s students, and class mentor for several master’s students.
RESEARCH REPORT 2018 87 BIO-ECONOMY & BIOTEC h NO LOGY 1
Prof Maretha Opperman
R ese ARC h e NT ITY
First DVC Innovation Award
The inaugural DVC Innovation Award, sponsored by IP law firm Spoor and Fisher, was jointly bestowed on Prof Maretha Opperman and Prof Spinney Benade (posthumous) for their research into a portfolio of nutraceutical and food supplement products. In his address at the awards ceremony, Dr Revel Iyer, TTO Director, said the award was a new initiative to recognise the contribution of CPuT researchers to technological innovation stemming from research. The award was presented on World Intellectual Property Day on 26 April. “In choosing the recipient of the award, we look beyond the simple creation of innovations. The requirement is that the technology must be packaged in a translational form such that it has a tangible effect on the society and economy. Preference is given to innovations making an impact in South Africa,” explained Dr Iyer.
Acting DVC: RTIP, Prof Marshall Sheldon, pointed out that the 2018 World Intellectual Property Day campaign celebrated the brilliance, ingenuity, curiosity and courage of women who are driving change in our world.

“Everyday women come up with game-changing inventions and life-enhancing creations that transform lives and advance human understanding from astrophysics to nanotechnology and from medicine to artificial intelligence and robotics. At CPuT we have a number of women whose research is directed at innovation that has created intellectual property,” said Prof Sheldon.
Prof Opperman said she and Prof Benade worked together for 13 years, and established the Functional Food Research unit in 2009. They worked on various projects including three which yielded patents for an omega-3 capsule called Omega Caro-E; Nutri Caro-E nutritional supplement premix containing carotenes, vitamin E and minerals known to be deficient in groups of people consuming a starch-heavy diet; and a soon to be released emulsion version of Omega Caro-E for children. “I am working with Food Technology to develop the taste,” she said of the emulsion.
Their initial focus on community research, conducting clinical trials to determine the optimum daily level of fatty acids needed by people, was a model they replicated ever since as they developed different nutraceutical and food supplements. “Prof Spinney always said ‘You don’t just do research for a publication to sit on your shelf. If you can’t apply it, you don’t do it’. That was a very big motivation for me,” Prof Opperman remembered.
An associate professor in the Department of Biotechnology and Consumer Science, Prof Opperman is also in her second year of study for an MBA from Stellenbosch university’s Business School to help her manage an NGO she is starting that will distribute the Omega Caro-E emulsion to local preschool children.

Prof Benade worked on carotenes his whole career, and the nutritional supplement premix
containing carotenes was the last project he worked on at CPuT his most recent research entailed investigating the use of the premix in a biscuit to mitigate the effects of vitamin A deficiency in children. “The other interesting thing is vitamin E. Prof indicated that in the population they were testing, 70% of the children were deficient in vitamin E which is important for brain development. It also protects your blood against oxidation and damage to arteries,” said Prof Opperman. “After these biscuits were given to the children, their deficiency declined to 10%, their school attendance improved, their levels of inflammation decreased. Then, they withdrew the biscuits for six months to see what happened, and all their levels turned back to deficient. I think he did really good research in that regard. The publications are not 100% finished yet, so I asked his wife if she wanted me to continue, and she said I must.”
While working on what would eventually become Omega Caro-E capsules, the two professors did extensive research into various omega-3 supplements available on the South African market and they passed on their results to the Registrar of Medicines at the Medicines Control Council, which led to an invitation for Prof Opperman to sit on their Complementary Medicines Committee. There she is collaborating on the writing of new regulations for complementary medicines and overseeing the writing of the guidelines on fatty acid supplements for the South African market.
RESEARCH REPORT 2018 88 BIO-ECONOMY & BIOTEC h NO LOGY 1 I NSTIT u TE OF B IO MEDICAL & M IC ROBIAL B IO TEC h NO LOGY ( IBMB)
Mrs Retha Benade accepting the award on behalf of her late husband, Prof Spinney Benade, from Prof Marshall Sheldon, and alongside Prof Maretha Opperman
Prof Spinney Benade and Prof Maretha Opperman started the FFRu in 2009
sPACe sCIeNCe & TeChNOLOGY

Introduction by Prof Robert van Zyl
Over the past decade, south Africa has become increasingly dependent on space-based applications to manage its national resources and security objectives. space science is indeed one of the five Grand Challenges defined by the Department of science and Technology to be addressed in its 10-year Innovation Plan. The establishment of the south African National space Agency (sANsA) has signalled a formal and coherent approach to the development of space-based research, engineering and technology innovation in south Africa. Within this context, this focus area serves as a catalyst for expanding current research to other niche areas to fully leverage the societal benefits to be derived from multidisciplinary, space-based services.
The focus area is informed and guided by national and regional developmental imperatives, primarily the National Development Plan (NDP). Operation Phakisa is an initiative by the South African government to fast-track the implementation of critical solutions that address issues highlighted in the NDP. The first initiative of Operation Phakisa focuses on the South African ocean economy and is sub-divided into four areas, one of which focuses on Marine Protection Services and Governance. The main thrust of research within this focus area is therefore towards creating space-based solutions to enhance the ‘maritime domain awareness’ (MDA) of the South African exclusive economic zone.
ZACube-2 was the first mission to validate technologies for MDA. The satellite was launched in 2018, and this project represents a precursor mission for an ambitious constellation of nanosatellites –the MDASat constellation – that is now under development.
The generic implementation of the comprehensive space programme at CPuT, as guided
by its ZACube-1 mission five-year development plan, is summarised below:
• Phase 1 - Development of technological capability
• Phase 2 - Leveraging off the capability to derive research benefits
• Phase 3 - Development of production capability
• Phase 4 - Development of a sustainable vehicle for research through nanosatellite technology
• Phase 5 - Managing a constellation of nanosatellites to the benefit of CPuT and South Africa

The focus area has now reached phase 5 of its development.
Key institutional arrangements providing a solid foundation for growth of this focus area are:
• The French South African Institute of Technology (F’SATI), which has emanated from a partnership between the governments of South Africa and France
• The Africa Space Innovation Centre (ASIC) hosted by F’SATI, which serves as an innovation hub to take research
RESEARCH REPORT 2018 89
2 vanzylr@cput.ac.za
2 to the marketplace through its international industry partnerships
• The South African Research Chairs Initiative (SARChI) Chair in Innovative Small Satellite Technology and Applications for Africa, which embodies the approach set out in the focus area
• Amaya Space, which is a spin-out company of CPuT to commercialise the intellectual property developed in the CPuT satellite programme, primarily within ASIC
The focus area comprises the following research niche areas and staff:
Space Segment
Prof Robert van Zyl, Prof Robert Lehmensiek, Mr Francois Visser, Mr Clive Whaits, Mr Charl Jooste, Mr Nyameko Royi and Mr Leon Steenkamp
Space Applications
Prof Robert van Zyl, Prof Roger Ceschi, Mr Siddique Motala and Mr Kevin Msungu
ICT for Space
Dr Laban Mwansa, Prof Elmarie Biermann, Mr Angus Brandt and Dr Vipin Balyan
Industrialisation of Space
Prof Stephen Bosman, Prof Mellet Moll, Prof Graham Oliver and Ms Patricia Khwambala
Space Science
Dr Kessie Govender and Mr Rory Pentz
One of our highlights for 2018 was that ZACube-2, the second satellite developed by CPUT, was launched on 27 December. ZACube-2 was contracted by the South African National Space Agency with funding from Department of Science and Technology.

The mission is a precursor to MDASat, a constellation of nanosatellites to provide maritime domain awareness services to the South African government.

RESEARCH REPORT 2018 90 SPACE SCIENCE & TEC h NO LOGY
Minister Mmamoloko Kubayi-Ngubane (DST) and Mr Nyameko Royi share in the farewell celebrations of ZACube-2
Prof van Zyl with ZACube-2 in the CPuT satellite laboratory cleanroom prior to send-off
French– s outh African Institute of Technology
( F’ s AT I)
FACULTY OF eNGINeeRING & The BUILT eNVIRONmeNT
The F’sATI Postgraduate Programme in satellite systems engineering at CPUT was established in 2009 with funding from DsT and NRF to develop the human capacity and skills required by the south African space industry. F’sATI hosts the CPUT Focus Area in space science & Technology. The programme is primarily aimed at postgraduate research and training and offers international master’s and doctoral programmes in partnership with French institutions. hands-on training is facilitated through the nanosatellite platform known as Cubesat, and typically spans four phases: Theory, Research, Development and Innovation. These last two phases take place within AsIC, a centre hosted by F’sATI to facilitate technology innovation in a professional environment of contracted employment.
Prof Robert van Zyl vanzylr@cput.ac.za

The vision of the institute and its innovation centre is to become a world-class innovation and support hub in Africa, with an end-toend capability in the design and manufacture of nanosatellites and nanosatellite components, space operations and ground-based support. The institute also undertakes data acquisition and handling for the provision of cost-effective satellite-based solutions tailored to the continent’s specific socio-economic needs. Among the relevant applications are space weather research, marine vessel tracking, wildfire detection and monitoring, and communications and technology validation. F’SATI at CPuT developed Africa’s first CubeSat in space, TshepisoSAT, which was launched on 21 November 2013 and has seen six years of activity in orbit.
During 2018, F’SATI continued to broaden its research activities by enrolling 56 postgraduate students, maintaining a steady student throughput (ten MEng and two DEng graduates), through its research publications (seven journal articles, nine conference papers and two book chapters), and its inclusion in local and international research networks.
In addition to its research and innovation activities, F’SATI also continues to create awareness and enable further networking and collaborations through its participation as an exhibitor at numerous international and local events, among them the International Astronautical Congress in Bremen in Germany, the African Leadership Conference in Abuja in Nigeria, Scifest Africa in Makhanda (Grahamstown), and the DST Budget Vote Debate exhibit at the Iziko South African Museum.
RESEARCH REPORT 2018 91 SPACE SCIENCE & TEC h NO LOGY 2
R ese ARC h I N s TI TUT e
highlights for 2018
New F’SATI model and MoA
A new model for F’SATI was established which was formalised by the signing of a new Memorandum of Agreement by CPuT, Tshwane university of Technology and university Paris-Est Créteil in France on 16 November.
Establishment of F’SATI as an RTI institute
F’SATI was formally established as a research & technology innovation institute within CPuT. This is in recognition of the prominent role that F’SATI continues to play in the RTI ecosystem of CPuT.
Back into the seminar space
The CPuT Satellite Programme has signed an Mou with Airbus Defence and Space regarding presenting technical seminars on the university campus. The programme’s partnership with the organisation dates back to 2009, when the it was first established with government support through the DST. F’SATI Director, Prof Robert van Zyl, explained that under first Mou, Airbus Defence and Space (then EADS Astrium) presented technical seminars by their senior engineers during the F’SATI Space Industry Seminar series. The most recently signed Mou will facilitate the continuation of these industry seminars.
The two parties wanted to revise their agreement to include that they would work together in the frame of the CPuT Space engineering and CubeSat programmes. The agreement sets out the terms under which the two parties will co-operate to perform activities for the education and training of the next generation of South African space engineers, promote the satellite engineering programme, and support the setting up and implementation of the South African space mission.
MoU with Airbus Defence and Space
The relationship between Airbus Defence and Space and the CPuT node of F’SATI dates back to 2009. A new Mou was signed on 16 November.

“The seminars have been very popular, attracting participants from all spheres of the industry, namely academic, industry, government, and not only from South Africa, but the region as well,” said Prof Van Zyl.
The Satellite Programme has matured into an internationally recognised and nationally strategic centre that develops skills vital to the national and regional space industries. CPuT’s second nanosatellite, ZACube-2, was launched into space in December 2018.
“Africa is also at an exciting junction of its space programme, having adopted the African Space Policy and Strategies. Formalising partnerships with a global leader in the space industry such as Airbus strengthens our ability to provide our students with an international perspective, and exposes our space industry to global technology trends,” said Prof Van Zyl. he thanked Airbus for their continued commitment to F’SATI and CPuT, as well as the industry at large and added, “We also want to take this opportunity to thank DST and its agencies for their unwavering support.”
RESEARCH REPORT 2018 92
SCIENCE & TEC h NO LOGY 2
SPACE
Dr Jean-Paul Toutain of the French Embassy with Prof Marshall Sheldon and Mr Martin Sefzig of Airbus Defence and Space
F RENC h–S O u T h A FR ICAN I NS TIT u TE OF T EC h NO LOGY
Africa space Innovation Centre (AsIC)

FACULTY OF eNGINeeRING & The BUILT eNVIRONmeNT
AsIC was established as a formal RTI research centre within CPUT in 2013. It has since evolved into a vibrant innovation hub, where our graduates and engineers develop cutting edge nanosatellite technologies in new high-tech facilities to support space-based applications such space weather research, marine vessel tracking, wildfire detection and monitoring, communications and technology validation. Over the past five years, the AsIC team of engineers have developed a suite of communications products – with proven space heritage on a growing number of missions. These products span VhF, UhF, s- and X-band for telemetry and payload data communications.
Prof Robert van Zyl vanzylr@cput.ac.za

ASIC is also responsible for the full lifecycle development of nanosatellite missions. Its second satellite, ZACube-2, was launched on 27 December 2018 from the Vostochny Cosmodrome in Russia. The ZACube-2 mission is a strategic contributor towards our government’s Operation Phakisa and its oceans economy and biodiversity initiatives. This mission will soon be followed by a further three nanosatellites, which are the first of the MDASat constellation.

All IP developed in ASIC is licensed to Amaya Space, the first spin-out company of CPuT
The ASIC engineering team members are: Prof Robert van Zyl, Mr Francois Visser, Mr Nyameko Royi, Mr Charl Jooste, Mr Leon Steenkamp, Mr Stephen Cupido, Mr Donovan Cogan, Mr Etnard Louw, Mr Morné Roman, Mr Kanyisa Mtshemla, Mr Arthur Mabunda, Ms Lilie Leopold and Mr Sinamandla Maqina.
RESEARCH REPORT 2018 93 SPACE SCIENCE & TEC h NO LOGY 2
ZACube-2 in the clean room of the CPuT satellite facilities
ZACube-2 in the clean room of the CPuT satellite facilities
R ese ARC h C e NT R e
Centre for Instrumentation Research (CIR)
FACULTY OF eNGINeeRING & The BUILT eNVIRONmeNT
The CIR has a long-standing history within the Department of electrical, electronic & Computer engineering. The centre is based in the new electrical engineering Research Building on the Bellville Campus and operates under the umbrella of the F’sATI. The centre is lead by Dr Kessie Govender. Over the last few years, the centre has grown in terms of active staff members and postgraduate students.
Currently, the main focus areas of the CIR are: a) Industry Application/Energy; b) Space Science and Technology; c) Emerging Technologies-Photonics.
Dr Kessie Govender
govenderk@cput.ac.za
In the category of Industry Application/Energy, the main project areas are novel electronics for high frequency ultrasonic condition monitoring of transmission lines and high voltage insulator cleaning, and direct current technology. Active staff members in this area are Mr B Groenewald and Mr J Wheeler. A 350V direct current house project is in process, funded by Erasmus+. This is a collaborative project involving a number of local and international partners including De haagse hogeschool Delft and Technische Universiteit Delft in the Netherlands, Katholieke universiteit Leuven in Belgium, and industrial experts in the Netherlands. household appliances are moving towards direct current, which makes the conversion from alternating current to direct current unnecessary and wasteful. The CIR has developed a focus group doing research into a DC micro-grid and 350V direct current house model that will hopefully set the trend for the future domestic landscape.
This research group hosts several master’s students, one of whom graduated in 2018. In addition, a number of accredited journal and conference papers were been produced.
Also based within the centre is the Quantum Physics Research Group headed by Dr Kessie Govender. This group forms part of the Emerging Technologies-Photonics focus area of the CIR and conducts research into quantum technologies and quantum communications (please see report below on the Quantum Physics Research Group).

RESEARCH REPORT 2018 94 SPACE SCIENCE & TEC h NO LOGY 2
R ese ARC h C e NT R e
Quantum Physics Research Group
The Quantum Physics Research Group was established within the Department of electrical, electronic & Computer engineering in 2014. The group, led by physicist Dr Kessie Govender, currently conducts investigations and develops expertise in quantum-based technologies. A quantum optics laboratory has been introduced for the purpose of cooling atoms and the subsequent development of quantum information processing components.

In October 2018, the group reached one of its major milestones in the cooling of a cloud of Rubidium atoms to an ultra-low temperature of approximately 17 micro-Kelvin. We are one of only two research groups in Africa to have achieved this. These ultra-cold atoms will be used to study the generation of entangled photons for quantum communications and quantum computing, as well as quantum sensors.
Dr Kessie Govender
govenderk@cput.ac.za
more information on the activities of the group can be found at: http://www.cput.ac.za/ academic/faculties/engineering/ research/quantum_physics
The group has established collaborations with researchers at the Laser Physics group at Stellenbosch university, the National Metrology Institute of South Africa (NMISA) and the Quantum Physics research group at UKZN. The group is being funded through an NRF Thuthuka grant, a CSIR-NLC laser rental pool grant, and the CPuT research office. Financial support is also provided by F’SATI.
In 2018, students in the group presented their work at the annual conference of the SA Institute of Physics held at the university of the Free State. Two refereed conference papers were published in 2018. Three master’s students – Ms Meena Patel, Mr Adrian Wyngaard and Mr James Stubbs – graduated in April 2018, two of them obtained cum laude passes. Two doctoral and two master’s students are currently active in this research group.
RESEARCH REPORT 2018 95 SPACE SCIENCE & TEC h NO LOGY 2
R ese ARC h C e NT R e
Breakthrough for Quantum Physics Group
Physicist Dr Kessie Govender, leader of the CPUT Quantum Physics Research Group, succeeded in cooling a cloud of rubidium atoms to around 17 micro Kelvins, which is approximately 273 degrees Celsius below zero. The research group managed to obtain an approximately 3mm square cloud of cold Rubidium 87 atoms in October 2018. The group included doctoral students, Adrian Wyngaard and Rory Pentz, and master’s student Victory Opeolu, all of whom are actively involved in this project. “We are one of a few groups to achieve this in South Africa and possibly Africa,” said Dr Govender about this first step in developing components for quantum computing locally.
Dr Govender started the Quantum Physics Research Group in 2015 to investigate laser cooling of atoms and the development of quantum information processing components. “There are many platforms for doing quantum computing and we’ve chosen a particular one where we use lasers to cool down atoms,” he said. “You can do a lot of things with cold atoms. For example, you can make atomic clocks, which is something I want to do because we work closely with the F’SATI satellite programme.” The idea was to shrink it

down to be used in the nanosatellite, he added. “Data is sent from one satellite to the next and all the data needs to be tagged with a time stamp. The atomic clock’s margin of error is a lot smaller than that of any similar instrument.” Dr Govender said he was pleased he had got this far with his research, which was based on a set-up that the research group assembled themselves.
Over the past three years, the research group have built and grown their own electronic setup, spending six months in 2018 optimising the system’s parameters. The system, positioned on two optical tables, comprises saturated spectroscopy set-up to control the cooling and re-pumping lasers, plus a vacuum chamber where the atoms are cooled. The vacuum chamber is an octagonal chamber, from Kimball Physics, with a large view port in front and a number of small view ports on the sides. Next they have to think about how to expand the system as they continue their experiments. “We still need to characterise the cloud and do experiments on them, move them into little traps. Then we have to move on to creating a Bose-Einstein Condensate,” Dr Govender said.
RESEARCH REPORT 2018 96 SPACE SCIENCE & TEC h NO LOGY 2
Dr Kessie Govender and doctoral candidate, Mr Adrian Wyngaard
3eNeRGY
Introduction by Prof Raynitchka Tzoneva

Focus Area: Energy is one of the outcomes of the CPuT 10-year strategy for research and innovation, as described in the 10-year RTI Blueprint. The aims of the focus area are as follows:
• Introduction and development of international best practices and transfer of knowledge in the field of energy and power systems
• Production of research and innovation outcomes relevant to the social and economic development needs of South Africa
• Building a critical mass of researchers at CPuT and making effective use of limited resources
The focus area’s research is multidisciplinary, innovation oriented and problem-solving driven to address national and international challenges in the energy field.
ReseARCh CeNTRe/UNIT
Centre for Distributed Power & electronics systems (CDPes)

Centre for substation
Automation & energy management systems (CsAems)
The research investigations are aligned with two of the DST’s key Research and Development (R&D) areas: Energy Security, and Frontiers of R&D. The industry-related activities, and knowledge and technology transfer, are aligned with two of the DTI’s priority areas for growth in South African industry: the development of industrial partnership for research, and engineering scarce skills development.
Members of the focus area are research centres and units from the Faculty of Engineering & the Built Environment. Their research activities and projects vary from producing biofuel to building a smart grid. The members and their foci of research are listed in the table below:
Energy efficiency, renewable and alternative energy technology, distributed system technology, predictive control of power converters and electrical drives, and MEMS energy sensor technology.
Contribution to and addressing the need in SA for research infrastructure development that supports human capital development, and research and innovation in the field of metering, monitoring, protection, automation and control of power systems, paying particular attention to current and emerging standards in the field.
Direct current research
Micro-DC grid investigation for a sustainable household power plant; optimal use of sustainable power sources; conversion of AC installations to DC installations; DCgrid safety in households.
RESEARCH REPORT 2018 97
tzonevar@cput.ac.za
FOCUs OF The ReseARCh WORK LeADeR
Prof T Khan
Prof R Tzoneva
Mr B Groenewald
ReseARCh CeNTRe/UNIT
energy Institute
FOCUs OF The ReseARCh WORK
Organisation of two international conferences: Domestic use of Energy and Industrial & Commercial use of Energy.
LeADeR
modular solar Powered Aquaponics
Development of modular solarpowered aquaponics to encourage entrepreneurship to benefit society. Working with impoverished communities by introducing renewable energy projects that favour the upliftment of such communities.
Modelling of power stations
Modelling of power stations to assist in decision making for operational, maintenance and capital decisions. The longer term focus will be on training Eskom’s technicians using models of the full plants.
Renewable Energy Recovery from Waste Materials

Producing biogas from wastes to be used to replace or supplement fossil fuels in power generation. Investigation of Anaerobic Digestion (AD) as an energyefficient and environmentally beneficial technology for bioenergy generation.
Real-Time Distributed Systems (RTDS)

Development of novel models, design methods, software, hardware and their integrated application for real-time monitoring and control in proper areas of application and research.
Future steps in the Focus Area: Energy will involve collaboration between members and the integration of their research activities, as well as the undertaking of joint projects on national and international levels. The focus area’s activities will be aligned with the National Development Plan 2030 and sustainable development goals. Collaboration with Eskom, based on extension of the Eskom Power Plant Engineering Institute, will facilitate the solution of real industry problems and produce better-prepared and more knowledgeable master’s and doctoral postgraduates.
RESEARCH REPORT 2018 98
3
ENERGY
Prof T Khan
Mr F Ismail
Prof S Bosman
Prof I Omoregbe
Prof R Tzoneva
energy Institute
FACULTY OF eNGINeeRING & The BUILT eNVIRONmeNT
Prof mohamed Tariq Kahn joined the energy Institute in an oversight role in 2017, in order to provide continuity. The energy Institute was placed under directorship of Prof Kahn in July 2018. he is also head of the Centre for Distributed Power & electronic systems.

Prof Kahn brings to the Energy Institute an overarching approach of the evolution of the Energy landscape and the confluence of technologies in the vision of the Fourth Industrial Revolution. Prof Kahn’s research areas include energy efficiency, renewable and alternative energy technology, distributed energy system technology, predictive control of power converters and electrical drives and MEMS / IoT (Microelectromechanical systems / Internet of Things) energy sensor technology.
Prof Mohamed Tariq Kahn
khant@cput.ac.za
The Energy Institute has thus inherited researchers in Energy from Electrical & Power Engineering, as well as bringing together researchers in Mechanical Engineering, Chemical Engineering, Civil & Built Environment Engineering under this banner.
The institute now boasts the prestigious Master in Energy (MEng Energy) degree, which has been fully accredited by the Council on higher Education. This is an extension of the accredited programme developed by Dr Marco Adonis of the Centre for Distributed Power & Electronic Systems as the MTech Energy in 2016.
RESEARCH REPORT 2018 99 ENERGY 33
R ese ARC h I N s TI TUT e
Centre for Distributed Power & electronic systems (CDPes)
FACULTY OF eNGINeeRING & The BUILT eNVIRONmeNT
CDPes’s research areas include energy efficiency, renewable and alternative energy technology, distributed energy system technology, predictive control of power converters and electrical drives, and mems energy sensor technology.
Through its research, the CDPES aims to:
• Develop power conversion systems for renewable energy sources and investigate the interconnectivity of distributed resources with microgrids, electric power systems and the smart grid
• Apply such technology in multidisciplinary applications in the energy sector, including commercial, industrial and agricultural
Prof Mohamed Tariq Kahn

khant@cput.ac.za
To find out more about our centre, please visit http://www.cput.ac.za/academic/ faculties/engineering/research/ centre-for-distributed-power-andelectronic-systems-cdpes/staff
• Investigate and apply optical fibre and wireless communication techniques over large-scale power systems and distributed systems for telemetry control and security
• Improve control schemes for power converters, machines and drives in energy efficient applications
• Investigate alternative energy sources, including nuclear energy, environmental protection and sustainable development solutions pertaining to distributed systems
CDPES strives to find ways to improve the systems integration relationship, using networked sensor technology, ubiquitous computing, ambient intelligence, and associated electronic communication systems developments in the energy sector. using the latest software techniques, based on Etap, Digsilent, Matlab/Simulink and Opal RT, the centre has excellent resources to keep its 78 postgraduate students busy. Power electronics, communication and embedded systems are used in many of our Power System applications.
Some highlights of 2018
BTech Conference
The 2018 BTech Conference organised by the CDPES and Mr hermann Oelsner of Oelsner Wind Africa (co-founder of Afriwea) as guest speaker. Mr Oelsner delivered a thought-provoking presentation titled ‘Darling offshore wind and wave powered water desalination plant’. The topic resonated very well with
RESEARCH REPORT 2018 100 ENERGY 3
R ese ARC h C e NT R e
the audience and provided a clear overview of the developments in water desalination efforts on South Africa’s west coast. The conference was a success and encouraged student participation in research and conference presentation. Several parallel sessions were held, with topics ranging from solar energy, wind energy, and renewable energy, to microgrids, power electronics and smart grids. The centre’s master’s and doctoral students functioned as session chairs.
CDPES OPAL-RT laboratory launch
OPAL-RT is the world leader in the development of PC/FPGA-based real-time simulators, hardwarein-the-loop (hIL) testing equipment and rapid control prototyping (RCP) systems to design, test and optimise control and protection systems used in power grids, power electronics, motor drives, automotive, trains, aircraft and various industries, as well as R&D centres and universities.

In October 2018, CDPES established its own realtime simulation and hIL laboratory. The lab features six OPAL-RT hardware test units. CDPES has acquired three OP4510 and 3x OP4200 simulators. The OP4510 is a compact simulator that combines all of OPAL-RT’s strengths in high-performance RCP and hIL simulation. The OP4200 RCP/hIL system offers hIL, RCP, data acquisition and I/O expansion capabilities in a desktop-friendly package. The simulator supports power electronics, electric drive and other real-time applications for industry and academia. It comes equipped with a Xilinx Zynq® All Programmable SoC, featuring a Kintex™-7 FPGA and dual-core ARM® Cortex processor, and the same class-leading FPGA-based I/Os and real-time solvers provided throughout OPAL-RT product line.

The laboratory at CPuT now has the flexibility to meet all microgrid real-time simulation needs as well as power system design and power system protection simulation needs.


RESEARCH REPORT 2018 101 ENERGY 3
Energising research for alternative power sources
CDPES is proud of its two doctoral and five master’s graduates who were among the students capped at CPuT’s 2018 Summer Graduation. The students studied Electrical Engineering. Dr Ayonkunle Oluwaseun Ayeleso and Dr Gunjan Gupta were Doctor of Electrical Engineering graduates supervised by the centre.
Dr Ayeleso’s research for his DEng Electrical Engineering focused on a novel alternative energy conversion and generation system based on Magnetohydrodynamics (MhD) and the fourth state of matter known as plasma. he built a prototype MhD system and published seven accredited journal articles and conference papers for the work that led to his thesis titled ‘An improved plasma energy conversion system for electric power generation’.
This focus on alternatives is a big focal point of CDPES, headed by Prof Tariq Kahn, who supervised Dr Ayeleso. “The energy sector is at the forefront of everyone’s mind. Do we have a solution for a seemingly dystopian future? On the one hand there is space exploration, but that would be pretty useless if you go into space but Earth falls apart. Spaceship Earth has limited resources and the allocation from our current lifestyle simply uses too much. The world has to adjust, and new forms of energy generation are needed,” said Prof Kahn.
Prof Kahn, who is also Director of CPUT’s Energy Institute, said while they realised the need to encourage students to research alternative energy sources, they could not ignore fossil fuel mix. he said that the gas reserves of Mozambique and Namibia needed investigating. The Western Cape’s dire water situation also meant relooking at how steam is utilised in power stations with an eye on desalination technology.
Another important focus area is power grids, featured in Dr Gupta’s DEng Electrical Engineering
thesis titled ‘An analysis and improvement of selected features of power quality of grid-tied alternative energy systems’. Dr Gupta, supervised by Prof Wilfred Fritz, has published her simulation results in two journal publications and six conference proceedings.
Dr Atanda Raji supervised Mr Gideon Joubert’s master’s thesis titled ‘Advanced technological solutions to the negative perceptions of nuclear power plants’. Mr Joubert, who graduated summa cum laude, looked at how nuclear technology has evolved into a safer and cleaner alternative method of power generation since it was first introduced.
Like Mr Joubert, Mr hlonela Gesha completed the new MTech Energy coursework, a master’s course that runs parallel to the regular MEng Electrical Engineering one. Mr Gesha was supervised by Prof Kahn for his thesis, ‘An analysis of the environmental impacts of biomass application hybrid microgrids in South Africa’.

Mr Tariq Lameen, also supervised by Prof Kahn, wrote the master’s thesis, ‘Development of a photovoltaic reverse osmosis fogging demineraliser for improved gas turbine generation output’.
Mr William Murray, who graduated MEng Electrical Engineering summa cum laude, was supervised by Dr Marco Adonis for his thesis, ‘Energy wheeling viability of distributed renewable energy for industry’. he investigated the economic viability and technical concerns of transporting electricity generated by an independent power producer directly to an industrial consumer.
Supervised by Dr Wilfred Fritz and Prof Kahn, Mr Nkusi Emmanuel graduated MEng Electrical Engineering having written the thesis, ‘Modelling of harmonic stability and voltage distortion between electrical grid and renewable generation technologies’.
RESEARCH REPORT 2018 102 ENERGY 3
Prof Tariq Kahn (right) with two lecturers and three students from CDPES
Centre for mechanics & Technology (CmT)
FACULTY OF eNGINeeRING & The BUILT eNVIRONmeNT
The Centre for mechanics & Technology focuses on both fundamental and applied research in the field of mechanics. It is led by Prof Bohua sun, a member of the Academy of science of south Africa (Assaf).

During 2018, the centre published four DhET accredited journal articles:
• Bohua Sun: ‘Kepler’s third law of n-body periodic orbits in a Newtonian gravitation field’ in Sci. China-Phys. Mech. Astron. https:// doi.org/10.1007/s11433-017-9154-0
• Bohua Sun: ‘Capillary wrinkling scaling laws of floating elastic thin film with a liquid drop’ in Sci. China-Phys. Mech. Astron. https://doi. org/10.1007/s11433-017-9116-5
• Bohua Sun & Elaine S Oran: ‘New principle for aerodynamic heating’ in National Science Review https://doi.org/10.1093/nsr/nwy035
• Hui Hu & and Bohua Sun: ‘New development in near-wall PIV measurements’ in Sci. China-Phys. Mech. Astron. https://doi. org/10.1007/s11433-018-9248-x
sunb@cput.ac.za
One DTech, three MTech and three BTech students were supervised at the centre during 2018.
Prof Bohua Sun won CPuT’s Platinum Award for Research Publications this year.
RESEARCH REPORT 2018 103 ENERGY 3
Prof Bohua Sun
R ese ARC h C e NT R e
Centre for Real-Time Distributed systems (CRTDs)
FACULTY OF eNGINeeRING & The BUILT eNVIRONmeNT
The CRTDs team members are Prof Raynitchka Tzoneva (leader), mr Carl Kriger (deputy leader), Dr mkhululi mnguni, Dr Quinton Bart, Dr senthil Krishnamurthy, mrs Nomzano Tshemese, mr mukhove Ratshitanga and Dr Y mfoumoulou (postdoc).
The centre strives to make a theoretical and application-based contribution to advances in real-time distributed systems. It is concerned with the development of novel models, design methods, software, hardware and their integrated application for real-time monitoring and control. It also aims at insightful and focused determination of proper areas of application and research through appraisal and reappraisal of emerging control technologies.
The core activities of the centre are:
Prof Raynitchka Tzoneva

tzonevar@cput.ac.za
• Design and implementation of nonlinear controllers
• Distributed control based on the IEC61499 standard for function block programming
• Design and implementation of networked control systems
• Optimisation of complex distributed systems and development of algorithms for parallel computation
highlights of 2018
1. Novel methods developed
- A decomposition co-ordinating method for the solution of a multi-area power system dynamic optimisation dispatch problem was developed by DEng student Mr L Mbangeni
- A method for the design of a nonlinear adaptive controller based on Lyapunov’s theory for the control of interconnected networked processes was developed by DEng student Mr Y Mfoumboulou, and implemented in realtime using a PLC and the Compact Rio Labview controller
- A novel method for model reference Lyapunov functionbased nonlinear control of synchronous generators in multiarea power systems was developed by MEng student Mr P Banga-Banga, and implemented in real-time using RTDS and an SEL computer
- A method for design of decentralised controller for an interconnected flotation process was developed by the DEng student Ms N Tshemece (who is also a staff member)
RESEARCH REPORT 2018 104 ENERGY 3
R ese ARC h C e NT R e
2. Collaboration with yildis Technical University, Department of Automation and Control
- Through the Erasmus+ Credit exchange project for staff and students exchange, three staff members and two PhD students visited the CRTDS
3. Funding secured
- Eskom TESP programme: R100 000

- NRF funding for DEng student Mr Y Mfoumboulou: R110 000
NRF funding for DEng student Mr L Mbangeni: R110 000
4. Degrees awarded DEng: Electrical Engineering – Yohan Mfoumboulow ‘Design and implementation of an adaptive networked controller’ (supervisor: Prof Tzoneva)
DTech: Electrical Engineering – Ntuthuko Marcus Dube ‘Development of methods for modelling, parameter, and state estimation for nonlinear processes’ (supervisor: Prof Tzoneva)
MEng: Electrical Engineering, summa cum laude – Giresse Djiepkop ‘A feeder reconfiguration scheme with integration of renewable energy sources using a particle swarm optimisation method’ (supervisors: Dr Krishnamurthy and Prof Tzoneva)

RESEARCH REPORT 2018 ENERGY 3
-
105
Centre for substation Automation & energy management systems (CsAems)
FACULTY

OF eNGINeeRING & The BUILT eNVIRONmeNT
The CsAems team members are Prof Raynitchka Tzoneva (leader), mr Carl Kriger (deputy leader), Adj Prof Alexander Apostolov, Dr senthil Krishnamurthy, Dr mkhululi mnguni, Dr Quinton Bart and mr mukhove Ratshitanga.
The centre seeks to contribute to addressing the need in South Africa for research infrastructure development that supports human capital development and research and innovation in the field of the metering, monitoring, protection, automation and control of smart power systems, paying particular attention to current and emerging standards in the field.
Core activities concentrate on contributions to the theory and practice of substation automation and energy management systems, including:
• Interpretation, modelling and implementation of the IEC61850 standard functions at all control, protection and automation levels of smart grids
• Integration of distributed energy resources (DERs) to power grids
tzonevar@cput.ac.za
• Development of innovative protection schemes for different applications
• Real-time simulation and innovative solutions to energy management problems in the conditions of smart grids
• Development of test-bench facilities for the testing of ideas, project solutions, and new developments in the field of power systems
• Training and knowledge transfer through equipmentorientated courses, yearly industrial seminars on IEC61850, and organisation of the international biannual PAC World Africa Conference
• Development of a new MEng (Electrical Engineering) in Smart Grid qualification under the Erasmus+ K2 DAMOC project
highlights of 2018
Achievements in 2018 in research, development, and applications of the IEC 61850 standard and technology to power and smart grids included:
1. New and innovative theoretical approaches and methods, algorithms, and their implementation using computers, intelligent electronic devices, communication switches, controllers, PLCs, and a real-time digital simulator: These were designed, developed, built, tested and validated by various postgraduate students, including four MEng (one staff member) and three DEng (three staff members). These solutions were also part of the Prestigious and TIA projects.
RESEARCH REPORT 2018 106 ENERGY 3
Prof Raynitchka Tzoneva
R ese ARC h C e NT R e
They were tested and validated in real-time by hardware in the loop test beds and showed excellent performance in comparison with conventional solutions.
Ou tputs that resulted:
- No vel methods, algorithms software and a h IL w ith RTDS test bed for the real-time adaptive implementation of load shedding by Dr M Mnguni
- An h IL with RTDS test bed for the real-time implementation of the developed IEC61850 standard-based protection of the CP u T reticulation network by Mr M Ratshitanga
- Ne w method and test bed for the real-time implementation of schemes for transformer protection by Mr MC Elenga
- Ne w methods for synchrophasor estimation and their implementation on FPGA platform for building a PMU device by Dr Q Bart
- Ne w optimisation methods for reconfiguration of distribution power networks and their implementation using parallel cluster optimisation problem solution by Mr G Djieokop
- No vel methods, algorithms, software and hardware for h IL with RTDS implementation of a new IEC61850 standard logical node for a condition monitoring system of an electrical motor by Dr C Kriger - Ne w methods, guidelines, software, hardware and test bed implementation of a fully interoperable protection system using IEDs from various by Mr N Mguzulwa
2. erasmus+ K2 capacity building and K1 credit mobility international projects:
- Capacity building DAMOC project: PQM clearance for the new MEng in Smart Grid qualification was obtained and documents for accreditation were submitted to HEQC and ECSA; registration of a new stream of MTech: Electrical Engineering in Smart Grid at CPuT was completed
- Credit mobility with Yildiz Technical university, Turkey; a staff and student exchange programme was implemented
3. Collaboration with the electricity departments at government and municipalities of the Western Cape:
- hands-on training course on the programming, testing and implementation of IEC61850 standard compatible protection schemes was developed for a group of engineers from the Durban Municipality
- Agreement between the CSAEMS and the electricity department of CCT for joint work on some of their projects was completed
4. Application for a new specialisation Centre in smart Grid at the CsAems: This was submitted to the Eskom Power Plant Engineering Institute (EPPEI) programme and joint work with the Specialisation Centre for Renewable Energy was performed by supervision of EPPEI and CPuT students.
5. Funding secured:
- Eskom TESP programme: R100 000
- CPuT Prestigious Project: R1 000 000
- NRF/ThRIP project: R1 485 000
- Industrial Partners EtalumiSe Pty Ltd and MBSA
Consulting: R742 500
- Erasmus+ K2 DAMOC project for purchase of equipment: R1 323 325
- EPPEI project collaboration with Stellenbosch university Specialisation Centre: R90 000
6. Degrees awarded:
meng: electrical engineering
- Bwandakassy Baningobera, summa cum laude ‘The IEC61850 standard-based protection scheme for power transformers’ (supervisors: Dr Krishnamurthy and Prof Tzoneva)
- Ncedo Mguzulwa, summa cum laude ‘Investigation of interoperability of IEC 61850 protection functions’ (supervisors: Prof Tzoneva and Dr Mnguni)
- Mukovhe Ratshitanga, summa cum laude ‘Investigation and design of an integrated monitoring, protection and control system of a power reticulation network’ (supervisors: Prof Tzoneva and Dr Mnguni)
Deng: electrical engineering
- Carl Kriger ‘Development of IEC61850 standard-based object models for condition monitoring’ (supervisors: Prof Tzoneva and Prof A Apostolov)
- Mkululi Mnguni ‘IEC61850 standard-based adaptive load shedding scheme for distribution power networks (supervisors: Prof Tzoneva and Dr Krishnamurthy)
- Quinton Bart ‘Synchrophasor estimation algorithms for optimal implementation on a digital platform’ (supervisor: Prof Tzoneva)
RESEARCH REPORT 2018 107 ENERGY 3
CSAEMS students graduate with distinction

Four MEng Electrical Engineering graduates working in the CSAEMS graduated summa cum laude in December. This meant both their examiners awarded them more than 75% in their final assessments. The four are part of a cohort of 29 Electrical Engineering postgraduate students studying under the supervision of the centre, a state of the art substation automation laboratory under the directorship of Prof Raynitchka Tzoneva. Created in 2011, CSAEMS came about because the International Electrical Commission (IEC) put in place the IEC 61850 standards that govern the building, implementation and operations of substation automation systems.
Supervised by Dr Senthil Krishnamurthy, Mr Bwandakassy Cedrick Elenga Baningobera’s thesis ‘Implementation of an IEC 61850 standardbased harmonic blocking scheme for a power transformer’ won him second best presentation at CPuT’s 2018 Postgraduate Conference. The 30-year-old from Brazzaville, Congo wants to continue with his DEng studies to develop a novel protection scheme in the power hIL simulation environment.
Dr Krishnamurthy also supervised Mr Franck Noudjiep Djiepkop’s thesis ‘A feeder reconfiguration scheme with integration of renewable energy sources using a particle swarm optimisation method’. This research focused on the development of solutions for feeder reconfiguration problems to increase the flexibility, reliability and efficiency of electrical distribution systems. Optimising the feeder reconfiguration and distributed energy resources in a distribution network could provide additional power to a grid and improve the operation of the distribution
system. Mr Djiepkop is looking for opportunities to pursue further research at a doctoral level.
Supervised by Prof Tzoneva, Mr Ncedo Mguzulwa worked part-time over four years to complete his study ‘Investigation of interoperability of IEC 61850 protection functions’. Mr Mguzulwa, 33, works for the City of Cape Town in the Electricity Generation and Distribution Department. he investigated the IEC61850 protocol that allows for communication between protection relays. “Procurement is a big part of engineering, and utilities and municipalities have to be careful and not be locked into one vendor or service provider in order to ensure bids are fair and competitive. Therefore this research evaluated how different vendors and manufacturers of protection relays can be interoperable as the communication protocol has already been standardised,” Mr Mguzulwa explained.
Mr Mukovhe Ratshitanga was also supervised by Prof Tzoneva for his thesis ‘Investigation and design of an integrated monitoring, protection and control system of a power reticulation network’, which he developed part-time over three years under the CPUT Khula project. Ratshitanga, 35, is a lecturer at CPuT, assisting with research and development within CSAEMS and intending to study further. his research showed a reduction in costs of installation, operation and maintenance in substations.
“All four postgraduates implemented the developed in their theses’ solutions in real-time test beds, achieving excellent operation and performance. The high quality and novelty in their theses will be presented by publications in leading recognised journals in the field,” said Prof Tzoneva.
RESEARCH REPORT 2018 108 ENERGY 3
Mr Mukovhe Ratshitanga, Mr Ncedo Mguzulwa, Mr Frank Giresse and Mr Cedrick Elenga
4

CLImATe ChANGe & eNVIRONmeNT
Introduction by Prof Beatrice Opeolu

The Climate Change & environment Research focus area promotes research and activities that aim to avert or mitigate climate change and environmental issues. The research, teaching and community engagement activities of this focus area are closely aligned to the UN’s sustainable development goals (sDGs) and south African National Development Plan (NDP) themes. A number of sDGs focus on economic development and socially responsible societies. Poverty, unemployment and inequality are some of the challenges faced by south Africans; they are also priority issues that government works towards alleviating. The impact of climate change also exerts additional pressure on natural resources available for developing countries’ economic development. exploration and exploitation of these resources negatively affects humans and ecological systems. Water scarcity, pollution, disease, food insecurity, resource depletion and ecological disruption are some of the adverse outcomes of development. societies now have to find a sustainable balance between resource use, socio-economic development and the environment.
In 2018, the focus area organised week-long events to celebrated World Environment Day (5 June) and World Oceans Day (8 June). The events were jointly hosted with the Faculty of Applied Sciences. The theme for 2018 World Environment Day was ‘Beat Plastic Pollution’. The World Oceans Day’s focus also involved preventing plastic pollution and encouraging solutions for a healthy ocean. This topic is important at a time that recent studies have provided empirical data that proves the high occurrence and negative effects of plastic in aquatic systems.

A few highlights of activities for the focus area in 2018
• A symposium themed ‘Beat plastic pollution’ took place with six speakers from academia, gover nment and an NGO. Over 40 staff members and students attended the event. The symposium provided valuable information on plastic pollution sources, effects and control strategies. It also opened up networking opportunities between the various stakeholders.
RESEARCH REPORT 2018 109109
opeolub@cput.ac.za
Some participants at the World Environment Day Symposium
• Over 180 staff, students and invited guests participated in a clean-up exercise on the District Six Campus and in its vicinity. The aim of the activity was to create awareness about plastic pollution among staff, students and District Six community members. It was also a community engagement effort of the Climate Change & Environment research focus area, the Faculty of Applied Sciences and the Green Campus Initiative group. Staff and students from across CPuT’s faculties and units participated in the exercise. The event was used to sensitise students and the entire CPuT community to the menace of plastic pollution and ways of that they may contribute to reducing the associated challenges.
• Invited guests met with staff and students of the Faculty of Applied Sciences on the District Six Campus. Research experiences and challenges were shared with attendees. The event further opened up discussions on possible future collaborative efforts between the guests and the CPuT community
• A CPUT public lecture followed by a panel discussion at the SARETEC Building on the Bellville Campus took place to commemorate World Oceans Day.
• Dr Tara Sabo-Attwood visited CPUT. She was a guest lecturer for the Water Quality Management class for BTech Environmental health and Environmental Management students. She was a speaker at the Women in Science Chat Room – a discussion forum for women academics that also took place during her visit to CPuT. Other speakers at the event included CPuT’s Director: Institutional Transformation, Social Cohesion & Diversity, Ms Nonkosi Tyolwana, and CPuT’s Director: Strategic Initiatives & Partnerships, Prof René Pellissier. Dr Sabo-Attwood also delivered a faculty seminar.
• The CPUT Waste Management Strategy inaugural meeting took place. The assembly attempted to define the purpose and objectives of the strategy as well as current waste management practices.
New partnerships and collaborations within and outside CPuT were fostered during the year.
The focus area welcomes ideas on projects and initiatives that may be pursued from within and outside CPuT for the good of the environment.

RESEARCH REPORT 2018 110 CLIMATE C h AN GE & ENVIRONMENT 4
CPuT guests, staff and students during World Environment Day clean-up activity
Visiting lecturer gives a fresh perspective

A guest lecturer from America, Dr Tara Sabo-Attwood, co-facilitated a Women in Science Chatroom on District Six Campus in September. Invited by Focus Area: Climate Change & Environment Research leader Prof Beatrice Opeolu, Dr Sabo-Attwood also delivered guest lectures in the Faculty of Applied Sciences. Dr Sabo-Attwood is an associate professor and Chair of the Department of Environmental & Global health and a member of the Centre for Environmental and human Toxicology and Emerging Pathogens Institute at the university of Florida.
Prof Opeolu facilitated the chatroom alongside Dr Sabo-Attwood, after the two met at a similar forum. “Tara and I, together with another colleague from Europe, Dr Gertie Arts, previously facilitated a workshop for women at the SETAC Africa meeting in Nigeria last year, and it was a huge success,” explained Prof Opeolu. Dr Sabo-Attwood and Prof Opeolu were joined by CPuT’s Director:
Institutional Transformation, Social Cohesion and Diversity, Ms Nonkosi Tyolwana, and CPuT’s Director: Strategic Initiatives & Partnerships, Prof René Pellissier. Prof Opeolu hoped to replicate a similar effect at CPuT to the previous workshop, with each of the women providing their unique perspective on how they dealt with positions of leadership and navigated work challenges and their personal lives.
The visiting academic also taught a Water Quality Management Class for BTech Environmental health & Environmental Management students, presenting a lecture titled ‘Novel in vitro approaches for aquatic monitoring of emerging contaminants’. During the lecture, she discussed the use of in vitro assays for water and wastewater management practices. Prof Opeolu said Dr Sabo-Attwood’s presence introduced a new context to the classroom, saying the way she taught was different. This enriched the delivery of the curriculum and what the students took out
Energy and Water SETA pledges R9 million in bursaries
of the class. The guest lecturer added value to students’ learning experience by bringing a new perspective to the class. It was also an innovative way to step aside from routine classroom teaching and helps students to build their own networks in the process of learning.
During her time at CPuT, Dr SaboAttwood also delivered a faculty seminar for staff and students on ‘Nano-evolution: Balancing safety and applications of nanotechnology in aquatic systems’.
The Energy & Water Sector Education & Training Authority (EWSETA), a skills development authority for the energy and water sectors, has awarded 150 students with bursaries to the value of R9 million. EWSETA has been funding academically achieving students in Environmental health, Civil Engineering and Electrical Engineering since 2015. “CPuT is an institution that has consistently received bursary grants from EWSETA and that is largely due to the fact that CPuT students are
such determined, passionate and committed youths, who know what they want and are driven to achieve it,” said EWSETA’s Western Cape Provincial Manager, Ms Renecia Wilson.

In 2015, the SETA committed R2 million towards bursaries for 40 diploma students in Environmental health & Environmental Management. Impressed by the high calibre of the 2015 awardees, the SETA more than tripled their funding and handed over a cheque of R7.2 million to assist 123 CPuT students in 2017.
In expressing gratitude for the funding, CPuT’s Director: Advancement, Mr Calvin Maseko, encouraged students to work hard so that the SETA can continue increasing its investment to CPuT year by year. “We appeal to the current bursary recipients to maintain the high standard of performance that EWSETA has come to expect from CPuT learners and not let the bar drop,” said Mr Maseko.
Ms Wilson added that when the awardees completed their studies, they would like to see the graduates gainfully employed in the water and energy sectors. “This will allow them to contribute towards our country’s scarce skills, which we are currently sourcing from other countries,” she said. “If they can accomplish this they will be contributing to making South Africa a globally competitive economy.”
RESEARCH REPORT 2018 111 CLIMATE C h AN GE & ENVIRONMENT 4
Guest speaker, Dr Tara Sabo-Attwood
Some of the students awarded bursaries by EWSETA
What is in our water?

World Environment Day is not just about oceans, it’s about everything to do with the environment, whether it is water or the food that we grow or the soil or the air. The theme in 2018 was ‘Beat plastics pollution’, to make people more aware of the harmful effects of plastic on the environment.
The Extended Curriculum Programme co-ordinator in the Faculty of Applied Sciences, Prof Beatrice Opeolu, drives activities to create awareness around climate change and the environment as the leader of the Climate Change & Environment Research focus area. She teaches water quality management to Environmental Management and Environmental health BTech students, and recently she started focusing more on environmental toxicology. “This is the study of poisons in the environment,” explained Prof Opeolu.
For the past decade, Prof Opeolu’s research has concentrated on monitoring different kinds of pollutants in water and food samples, searching for the presence of heavy metals, phenols and polycyclic aromatic hydrocarbons (PAhs), perfluorinated compounds and pharmaceuticals. The dominant sources of PAhs in the environment are human activities such as wood-burning or combustion of biofuels, and improper waste disposal.
She started off researching how the PAh level in food changed depending on how it was processed – fats are converted to PAh differently when food is grilled versus fried or boiled – and then moved on to checking
PAh levels in freshwater systems. She discovered PAh levels were higher in the sediments than in the water, which meant different effects for organisms that live and feed on sediment materials versus others in the water column. Now she is moving from purely monitoring water to looking at the entire cycle of exposure. Specifically, she concentrates on various pollutants in water, figuring out at what levels these pollutants become toxic to the environment. Not only does she want to investigate what pollutants are present but she wants to figure out what this means for the environment and what remediation can be effected. “So the long-term plan is to be able to develop a material that we can use, as individuals and on an industrial scale, to remediate a combination of the pollutants. I’ve done research into heavy metals, several organic compounds including pharmaceuticals; so it would be great to have a single material that can remediate up to four pollutants because that would be more cost-effective,” said Prof Opeolu.
Prof Opeolu is currently setting up a laboratory space on the Bellville Campus in the horticulture department where she can oversee two or three postgraduate students. here she will expose organisms such as Daphnia (planktonic crustaceans specifically bred to be used in the laboratory), microalgae and bacteria to various pollutants in controlled environments. Eventually, she wants to be part of a Water Institute on campus so that she can draw on the expertise of colleagues in various fields to develop water remediation systems and solutions.
RESEARCH REPORT 2018 112 CLIMATE C h AN GE & ENVIRONMENT 4
We need to become more aware of plastic’s harmful effects on the environment
Oceans economy and the Centre for sustainable Oceans FACULTY OF APPLIeD sCIeNCes
The Centre for sustainable Oceans has been registered as a CPUT entity within the Faculty of Applied sciences, contained in a research niche area of Oceans economies and Governance under the university’s environment & Climate Change Research Technology & Innovation focus area, with extensions into other focus areas.

findlayk@cput.ac.za

Expansions of national and regional oceans economies are occurring around the world as countries turn to their ocean-exclusive economic zones (EEZs) to foster economic growth and provide food, energy and employment security for their increasing human populations. Tied to such growth is the need to underpin oceans economies with ‘blue’ economy approaches to management and governance – and these must parallel ‘green’ economies in incorporating natural capital accounting, sustainability, social equity and inclusiveness. Sustainability and the uN Sustainable Development Goals (including SDG14 – Life below water) are pivotal in future ocean governance at both authority and industry sector levels. Oceans provide humans with a myriad of earth-system, ecosystem and environmental goods and service benefits, and sustainable governance requires the balance of oceans economies and ocean health.
Informed decision-making is required to drive appropriate ocean governance policy, and three research focus areas underpin the research niche area of Oceans Economies & Governance. These research areas are local in nature, however they aim to address national as well international imperatives, such as the African union’s African Integrated Maritime Strategy 2050 and the South African Operation Phakisa Oceans Economy initiative of Marine Protection Services and Governance.
1. Ocean resource use conflict is often spatial in nature, and marine spatial planning and other spatial management systems require resource-use valuations (across economic, social and environmental domains) to resolve such conflict. The centre is developing decisionsupport for marine spatial planning, oceans economies and governance using natural capital accounting, ecosystem service
RESEARCH REPORT 2018 113 CLIMATE C h AN GE & ENVIRONMENT 4
Prof Ken Findlay
R ese ARC h C h AI R
4 valuation and geographic information systems mainly centred on Table Bay and Walker Bay.
2. Changes in ocean system processes arise from expanding and emergent oceans economy sectors within the African EEZs. Conflict between required national protected area initiatives under national commitments to international treaties (e.g. the Convention for Biodiversity) and developmental industries in the energy sector (offshore oil and gas) remains a strong component of this key focal area.

3. New and emergent ocean science technologies including data and information collection and knowledge development lead to advances in integrated ocean governance in the South African seaspace. Innovative aspects of the Fourth Industrial Revolution provide significant development of knowledge bases required for ocean governance. The
centre is under the South African National Antarctic Programme SCALE project, continuing to deploy deep-water oceanographic moorings for the monitoring of ocean acoustics.
Translation of this threetiered research framework to academic publications and then uptake to policy remained a central focus of the centre for 2018. The centre has also embarked (though post-doctoral appointment) on an international externally-funded collaborative project centred on ocean climate change. The Research Chair and the centre have become prominent in leading research around the oceans economy and governance in South Africa and Oceans Phakisa, which is exemplified by numerous requests by various governmental (DST, National Department of Tourism, SANBI, SAEON) and non-government (SAIIA, IORAG, IID) organisations for conference addresses and/or project participation.
Other recent collaborative projects include the very successful co-hosting of the
2018 South African National Antarctic Programme Biennial Symposium in August.
Academic outputs produced by the Research Chair in 2018 include co-authorship of four peer-reviewed publications and two book chapters, and a further two book chapters and three papers accepted for publication. Eight presentations were made at national and international research meetings, while one further international conference (the Sustainable Blue Economy Conference in Nairobi) was attended. A further five reports were co-authored for presentation at various meetings.
Prof Findlay is currently supervising seven MTech students and co-supervising one MTech student. Other recent collaborative projects include the co-hosting of the 2018 South African National Antarctic Programme Biennial Symposium in August, and research projects into ocean climate (with South African and Australian partners), Marine Protected Areas (local and international partners) and Marine Spatial Planning (local partners).
RESEARCH REPORT 2018 114 CLIMATE C h AN GE & ENVIRONMENT
O CEANS E CO NOMY AN D T h E C EN TRE FO R S u STAINABLE O CE ANS
Centre for Water supply & sanitation Research (CWsR)
The Centre for Water and Sanitation Research (CWSR) is the hub of CPuT’s water and sanitation research and focuses on:
• Identification and establishment of water-related activities based on regional and national priorities
• Facilitation and execution of interdisciplinary projects which generate research, income and postgraduate opportunities
• Development and maintenance of partnerships on behalf of CPUT in the water sector regionally, nationally and internationally
In 2018, CWSR continued collaboration with the Breede-Gouritz Catchment Management Agency (BGCMA), Framework for Research, Education and Training in the Water Sector (FETWATER III), and also pursued new partnerships..
‘Living LAB’ projects: BGCMA partnership
a. Institutional support to emerging farmers for improved livelihoods
The project facilitated five farmer information roadshows addressed about 200 smallholder farmers:
lagardiena@cput.ac.za
• Oudtshoorn Roadshow, 19 September
• Mosselbaai Roadshow, 20 September
• Ceres/Worsley/De Doorns Roadshow, 24 October
• Robertson Roadshow, 25 October
• Cape Agulhas Roadshow, 1 November
b. Reducing pollution from informal settlement waste streams

The project carried out sanitation activities in Villiersdorp in collaboration with Violence Prevention through urban upgrading (VPuu).
c. FeTWATeR III
Prof Lagardien continued co-ordinating FETWATER III. Key activities included facilitating the 4th Annual National Workshop, which engaged stakeholders in curriculum development for sector occupations under the banner of the Quality Council for Trades and Occupations. A series of workshops to build the capacity of expert practitioners were also held.
Current research commissions
a. Water Research Commission (WRC) Project 2530: ‘Water allocation for productive use – policy and implementation: A case study of the black emerging farmers in the Breede-Gouritz Catchment Management Area, Western Cape, South Africa’
• Completed project and submitted final report
b. WRC project 2716: ‘Improving smallholder farmer livelihoods through developing strategies to cope and adapt during drought periods in South Africa’
• Submitted Report 2: ‘Report on smallholder farmer characteristics and livelihood strategies in rural Limpopo and Western Cape provinces’
RESEARCH REPORT 2018 115 CLIMATE C h AN GE & ENVIRONMENT 4
Prof Alvin Lagardien
R ese ARC h U NIT
4
• Submitted Report 3: ‘Report on coping and adaption strategies for agricultural water use adopted by farmers during drought periods’
c. WRC 7153: ‘Capacity building for water monitoring and assessment’
• Completed Water Regulation Practitioner Delivery schedule questionnaires 1-4 and held workshops
Conference/workshop hosting and presentations
• Prof Lagardien co-ordinated the FETWater 4th Annual National Workshop in February
• Dr Bongani Ncube presented a seminar at the uWC Institute for Poverty, Land and Agrarian Studies in March
• Dr Ncube was a member of the International Review Panel: Long-term Eu–Africa research and innovation partnership on food and nutrition security and sustainable agriculture (LEAP–Agri) from February to April
• Dr Ncube attended the Water Institute of Souther n Africa (WISA) Biennial Conference with two postgraduate students in June
• Dr Ncube chaired a session at the U6 Inter national Conference at CPuT in September; postgraduate students Olwethu Pili, Mercy Fanadzo and Awelani Sadiki presented at the conference
• Dr Ncube chaired a session at the South African National Committee on Irrigation and Drainage (SANCID) Symposium help in Mpumalanga in November
Publications
• B Ncube: ‘Constraints to smallholder agricultural production in the Western Cape, South Africa’ in Physics and Chemistry of the Earth
• M Fanadzo and B Ncube: ‘Challenges and opportunities for revitalising smallholder irrigation schemes in South Africa’ in WaterSA
• B Ncube: ‘Insights into indigenous knowledge strategies for coping and adapting to drought in agriculture: A Karoo scenario, South Africa’ in Indilinga African Journal of Indigenous Knowledge Systems
• B Ncube, W Mupangwa and A French: ‘Precision agriculture and food security in Africa’ in Systems Analysis Approach for Complex Global Challenges
Postgraduate degrees conferred during 2018
• Two PhD and five master’s students were affiliated with CWSR in 2018
• Ms Sinazo Mnyaka graduated with a Master in Environmental and Water Science at uWC in April
New research commissions
WRC Project 2869: ‘Development of a Farmer Information Pack and Web Application’ (R300 000) was was signed 2018, with implementation to start in 2019.
Research income in 2018
Research output
RESEARCH REPORT 2018 116 CLIMATE C h AN GE & ENVIRONMENT
CLAIM/ INVOICE PROJECT COMPANY/ INSTITuTION AMOuNT WRC 922530WRCR90 000 WRC 932716WRCR100 000 WRC 947153WRCR250 000 WRC 952530WRCR140 000 WRC 962716WRCR400 000 Total R980 000
2018 PuBLICATIONS (SuBMITTED TO ThE DhET IN MAY 2019) uNITS Book chapters (submitted) 0.59 Conference proceedings (submitted) 2.50 Total 3.09 C EN TRE FO R WAT ER S u PP LY & S AN ITATION R ES EARC h (CWSR)
Crystal engineering Unit
FACULTY OF APPLIeD sCIeNCes
The Crystal Engineering unit conducts research in the field of solid crystalline inclusion compounds. Its main thrust is understanding the molecular recognition that occurs between molecules in the crystalline state. In particular, projects are aimed at understanding the various secondary interactions which lead to particular structures, and to correlate these with the macro-properties of the compounds under study. The crystal structures are elucidated by X-ray diffraction, and the stability and energy of the materials formed are studied by thermal, optical and kinetic measurements.

Staff members in the unit are Prof L Nassimbeni, Prof A Jacobs, Prof N Bathori and Dr M Wicht. There are a number of DTech, MTech, BTech and WIL students working on various projects at present. The projects focus on supramolecular host-guest systems, the mechanism of enantiomeric resolution whereby left- and right-handed molecules are separated, and pharmaceutical co-crystals.
nassimbenil@cput.ac.za

RESEARCH REPORT 2018 117 CLIMATE C h AN GE & ENVIRONMENT 4
Prof Luigi Nassimbeni
R ese ARC h e NT ITY
Radiochemistry and Ion exchange Chromatography
FACULTY OF APPLIeD sCIeNCes
Prof Nico van der Walt

vanderwaltt@cput.ac.za
Research projects that were started or continued:
• Separation of Nb, 88Y and 85Sr using respectively 91m, 92mNb, 88Y and 85Sr as tracers
• Nb was quantitatively separated from 88Y and 85Sr in 2.0 M hF, 88Y and 85Sr were finally eluted with 7.0 M hCl
• Separation of Zr and 88Y using respectively 88Zr and 88Y as tracers
• Zr was quantitatively separated from 88Y in 0.5 M h2SO4; 88Y was finally eluted with 7.0 M hCl
• Determination of distribution coefficients for Sc, Y, La, Ti, Zr, Nb and Ta in aqueous hydrochloric acid solutions on the macroporous cation exchange resins Dowex Marathon MSC and Amberlyst 15
• Adsorption of nickel(II) on polyacrylonitrile nanofiber modified with 2-(20-pyridyl)imidazole
Postgraduates continuing with their research projects:
• G Fennessy-Yon: Separation of Zr and Y in tartaric medium and the separation of Mg from Li, Na and Be on AG 50W-X4
• S Adonis: The optimisation and implementation of a separation technique for the isolation of Tb-isotopes from irradiated Gdtargets
• ARL Spies: Column ion-exchange chromatography with a stationary phase polymer containing a complexing agent as functional group

RESEARCH REPORT 2018 118 CLIMATE C h AN GE & ENVIRONMENT 4
R ese ARC h e NT ITY
5
hUmAN & sOCIAL DYNAmICs
Introduction by Prof Janet Condy

The human and social Dynamics research and innovation focus area at CPUT intersects with United Nations sustainable Development Goals
1, 2, 4, 5, 8, 10 and 16. These all aim to address an array of social, economic, political, scientific and technological issues, so as to stimulate multidisciplinary thinking to challenge south African researchers, industry and policy developers to answer existing questions, and to create new disciplines and develop new technologies.

This focus area aims to contribute to a greater global understanding of shifting social dynamics, to support multidisciplinary collaborative research, and to respond to the vulnerable and marginalised groups in society. Its challenge is to integrate strong theoretical and empirical links, enabling the ensuing multidisciplinary research to:
• Promote and support humanity and humaneness in the 21st century
• Create spaces where researchers collaborate and conduct research in a trans/multi/interdisciplinary manner across all faculties and units at CPuT
• Develop a capacity to deconstruct boundaries and interrogate the ways in which society may intersect and reinforce each other
• Create a social justice orientation which enables work towards a transformed society
• Create critical diversity literacies where the personal, societal and environmental are interwoven
In addition, and more specifically, in ‘One Smart CPuT’, the word ‘technology’ in our brief provides us with a special focus in research into human and social dynamics. ‘Technology’ necessarily entails a close relationship between the university and society, including working life, creating a sense of human-centredness while technology enables this new description. Social science research in a uoT would then, firstly, serve to problematise and improve the relationship between university curricula and practices and those of broader society, for example through work-integrated learning
initiatives such as practicums and projects. Secondly, research can highlight how technology and new ideas may be taken up by society in different ways (for example, accepted, changed, shelved or rejected), and how changes in technology and organisation can be harnessed for the benefit of society.
Potential research niche areas
• Connecting societies: Crossing boundaries, inside and outside the university, developing bridging people and social cohesion
- Sustainable Development Goals: 1, 4, 5, 8, 10, 16 and 17
- National Development Plan chapters: 8, 9, 10, 12, 13 and 15
• Empowerment: Purposive agency, care and the ethics of care, services and practices, transformation and 21st century literacies
- Sustainable Development Goals: 1, 3, 4, 5, 8, 10, 16 and 17
- National Development Plan chapters: 8, 9, 10, 11, 12, 13 and 15
• Human Rights: Freedom, equality, dignity, ubuntu, access to service and justice, ethics
- Sustainable Development Goals: 1, 2, 3 4, 5, 8, 10, 16 and 17
- National Development Plan chapters: 3, 8, 9, 10, 11, 12, 14 and 15
RESEARCH REPORT 2018 119119
condyj@cput.ac.za
4 Focus Area 5’s leader and champion: Prof Janet Condy
Prof Condy obtained her Doctorate of Philosophy in Education at uCT in 2006. The title of her thesis was ‘The development of an enabling selfadministered questionnaire for enhancing reading teachers’ professional pedagogical insights’.
Prof Condy has taught many subjects in CPuT’s Faculty of Education’s undergraduate and postgraduate programmes, i.e. Inclusive Education, First and Second Language Literacy, Education and Professional Studies, Research Methodology, and Introduction to Research. She conducted extensive research within the Professional Studies course and published a book titled Telling Stories Differently: Engaging 21st Century Students through Digital Storytelling as one of the deliverables from an NRF Teacher
Retiring DVC leaves a lasting legacy
DVC: Teaching & Learning at the Cape Peninsula university of Technology, Prof Anthony Staak, retired from the institution in December after 36 years of service. Prof Staak has enjoyed a stellar academic career spanning from the time he was a top learner at South Peninsula high School to later having the distinction of being awarded both the coveted Rhodes and Fulbright scholarships.
It was this academic prowess that first caught the attention of former Peninsula Technikon Rector, Prof Brian Figaji who head-hunted him while Prof Staak was completing a Rhodes scholarship in Oxford. “I am particularly proud because I actually recruited Prof Staak. I called his mother and then contacted him in England. I told him, ‘Staak you have a job when you get home’, and many years later this is the result,” said Prof Figaji at a farewell dinner hosted for Prof Staak.
Prof Figaji also praised Prof Staak for being selfless in his academic achievements because, despite his earlier undergrad and post-grad qualifications in Engineering, he opted to do a master’s in Economics to expand his world view. Prof Staak later made another unconventional career choice when he was awarded a Fulbright Scholarship and opted to do a master’s in the still relatively unknown
Development Grant (2011 to 2014). CPuT’s RTI vision is to ‘unlock the potential of staff, students, and partners to excel in research, technology, and innovation that offers solutions to the needs of our society’. This book does just that, bringing together lecturers from various faculties and units. It became a platform where academics conducted small research projects and published their work – many for the first time.
Prof Condy has graduated three doctoral students and eight master’s students to completion. She is currently supervising nine master’s students and one doctoral student. She has examined 23 master’s studies and two doctoral studies. In 2016 Prof Condy received a C2 NRF rating. In 2017 she was invited to lead the Focus Area 5 human & Social Dynamics. In April 2019, she will take up the position as Research Chair of CPuT’s Literacy Research unit.
area of Technology Transfer at MIT. “So it wasn’t about Anthony, but it was about what he needed to do his job better and what would serve the institution,” Prof Figaji said.
CPuT’s VC, Prof Chris Nhlapo, said Prof Staak’s legacy was imprinted into the DNA of CPuT and that his foresight into IP and policy meant the former Peninsula Technikon was ahead of its time. “Prof Staak understands exactly what we are trying to achieve here at CPuT, which is reviving the dream of being the MIT of Africa, and of course he speaks from experience having been a student there. Thank you very much Prof Staak, it is indeed sad to have someone of your stature leaving the team,” he said.
In his farewell speech, Prof Staak had the crowd in stitches recalling how memo pads and typewriters were preferred to the first generation computers in the 1980s. he also reflected on Peninsula Technikon’s role in the anti-apartheid struggle of the time. “We refused to implement the quota system and accepted students from across the country and neighbouring states as well. In fact we battled to keep the police off our campus,” he recalled. Prof Staak, who joined the then-Peninsula Technikon as the head of Electrical Engineering Department in 1982 and later became the Dean in 1998, said he was always very proud to be part of the Faculty of Engineering & the Built Environment, which spearheaded much of the innovation taking place at the institution – this included early internet connections and unique laboratory style learning spaces. “It was also quite unique at the time to have laboratories as classrooms, because the norm at the time was office space, classroom space and laboratory space,” he said. “We did everything in the labs.”
he said he was looking forward to indulging his passion for running and enjoying the company of his three grandchildren during his retirement.

RESEARCH REPORT 2018 120 CLIMATE C h AN GE & ENVIRONMENT
120 5
Prof Anthony Staak with colleagues at his farewell dinner
CPUT academic advocates the rise of isiXhosa and other national languages

Prof Xolani Sikhomo Mavela was born and raised in Stutterheim, attending village schools Nomathemba Primary, Mlungisi Senior Primary and Jongile Nompondo high School. he is the middle child in a family of six boys. his mother, Mrs Nokhuselo Priscilla Mavela, was a domestic employee for a timber factory owner, and his father, Mr Ngqayimbana Livingstone Mavela, a bus driver. Prof Mavela’s high school was eight kilometres from the village, meaning learners walked 16 kilometres a day, crossing two rivers and a forest, to get an education.
Prof Mavela was a top matric pupil in the Stutterheim district in 1992, achieving prizes for isiXhosa and Agricultural Science. he completed his BA humanities degree in 1995, and his higher Education Diploma in 1997 (both from uWC), as well as his BA honours cum laude and his master’s in African Languages and Literature cum laude (both at Stellenbosch university), in 2000 and 2003 respectively. he then taught as a junior lecturer (contract post) at Stellenbosch, leaving in 2006 to teach isiXhosa first additional language at Edgemead high, and in 2008 he joined Westerford high. he went back to Stellenbosch for a full time post, winning two teaching excellence awards in 2009 and 2010 respectively. In 2012, he joined CPuT’s Wellington Campus. Since then, he has been teaching isiXhosa Communication and Methodology at CPuT, taking students to the townships and the villages in the Eastern Cape for cultural enrichment.
he first wrote his research proposal in English as this was a requirement from the academic and ethics committees at all the universities. Once the proposal was approved, he communicated to his supervisor and the respective committees the importance of writing the thesis in isiXhosa. his reasons were, firstly, because he was investigating a problem about the teaching and learning of isiXhosa literature, so the theses would serve the needs of isiXhosa teachers and students; and secondly, since joining CPuT’s Wellington Campus, he had learnt more about the importance of mother tongue based education. Most of the students in the Faculty of Education were Afrikaans mother tongue speakers who were taught mainly in their mother tongue, wrote in their mother tongue and did subject-related research activities in their mother tongue. This resulted in excellent academic achievement and excellence in the quality of teachers coming out of CPuT
“One of the things I have learnt in this area is the pride people have in their Afrikaans language and this is why everyone is so united. I have visited the Afrikaans Taal Museum and Afrikaans Taal Monument in Paarl, and this motivated me to write to different language bodies and government departments to ask for the possibility of establishing isiXhosa Literary Museum somewhere in the Eastern Cape, where the majority of people speak isiXhosa,” he said. “IsiXhosa has been written since 1849, it is therefore vital to preserve that long history of writing somewhere, including these current research outputs which are in isiXhosa, for future generations to cherish and to know that their language is alive.”
Prof Mavela’s achievements have encouraged the African languages departments at South African universities to motivate students to write their research outputs in their mother tongue. But it won’t be easy to try and develop a language when the younger generation is swayed by the economic and political gains associated with English. Prof Mavela believes the first step is to digitise isiXhosa because young people love working with phones, tablets and laptops.
his journey has had many obstacles, including sacrificing family time, as well as issues at some of his research sites where educators thought he was a departmental watch dog. Even his initial path to university was difficult as family didn’t have money to send him to study. “Then God and the Ancestors sent an angel, the then MEC for Education in the Eastern Cape. Mrs Nosimo Bhalindlela, and her husband, organised the upfront payment for me. This is the reason why I am speaking to the schools in my hometown to identify students I can adopt in order to try and help with their initial fees, while also planning to sponsor isiXhosa awards – for best achievement in the language – at the three schools in my hometown,” Prof Mavela said.
“This achievement means that my poor and humble family’s flag has been lifted sky high; it means my small town is on the map. It is therefore not my achievement, but it is for the isiXhosa speaking masses, it is also a recognition of the substantial work done by old isiXhosa writers like SEK Mqhayi, JJR Jolobe, LK Siwisa, and many more,” said Prof Mavela.
And his advice to students? “First things first; organise your time optimally; never stop reading; surround yourself with positive and creative people; and always stay humble.”
RESEARCH REPORT 2018 121 hu MAN & SOCIAL DYNAMICS 5
Prof Mavela says, “Love yourself, love your language, and you will fly high in life!”
CPUT academics obtain doctorates from Rhodes
Three CPuT academics were awarded degrees as language doctors at Rhodes university’s 2018 graduation season. This was thanks to CPuT’s Prof Monwabisi Ralarala (co-supervisor), who was instrumental in the formation of a collaborative relationship between CPuT’s Language unit and Rhodes university’s School of Languages, headed by Prof Russell Kaschula (main supervisor). The Teaching and Development Grant financed all three studies. Dr Sithembele Marawu, a lecturer in the Faculty of Business & Management Sciences, and Dr Xolani Mavela and Dr Zakhile Somlata from the Faculty of Education, were all excited about their graduation.

The title of Dr Somlata’s thesis was ‘A critique of language policy and implementation strategies used in selected institutions of higher learning in South Africa’. It evaluated the language policy implementation strategies used in selected South African universities, as most universities have their language policies, but the dilemma lies in their implementation. “The overarching aim of the study was to evaluate how a university uses language policy for access and success of the students and to assess the language policy implementation strategies, monitoring and evaluation,” said Dr Somlata. “My knowledge on language policy implementation in higher education will be useful for me to play a role in breaking all the language
barriers that disadvantage the majority of South African students in higher education.”
Dr Mavela’s thesis was written in isiXhosa and titled ‘uphando-nzulu lweeMpendulo eziBhaliweyo zaBafundi bamaBanga aPhezulu eMfundo kuNcwadi lwesiXhosa’. his study investigated the causes of poor performance in written responses on isiXhosa literature assessments by FET home Language and First Additional Language students. The researcher used a mixed-method approach to gather his data and also provided measures to improve learner performance in isiXhosa literature assessments in both isiXhosa home Language and First Additional Language levels. “I am so happy to hear from various stakeholders that the study will contribute immensely towards a better pedagogy in isiXhosa literature and will easily spread to other African Languages as well,” said Dr Mavela. he was profiled in the Is’olezwe lesiXhosa newspaper for this achievement.
Dr Marawu’s thesis was titled ‘Code-switching as pedagogical strategy in classroom settings: The case of a township in a South African metropolitan municipality’. his research explored the use of this teaching approach in bi/multilingual classroom settings. It was prompted by the widespread use of code-switching in classrooms, particularly in South African rural and township schools.
RESEARCH REPORT 2018 122 hu MAN & SOCIAL DYNAMICS 5
Dr Zakhile Somlata, Prof Monwabisi Ralarala, Dr Xolani Mavela, Prof Russell Kaschula, Dr Sithembele Marawu and Dr Mhlobo Jadezweni
R ese ARC h C h AI R
Centre for International Teacher education (CITe) (NRF sARChI Chair) FACULTY OF eDUCATION
The sARChI Chair in Teacher education and the Centre for International Teacher education (CITe) with Prof Yusuf sayed as its director successfully completed its first phase in 2018. The sARChI Chair funded by NRF is housed in the Faculty of education at CPUT. CITe, under the auspices of the Chair, has produced a number of quality outputs that are recognised as such by local and global scholars.
The SARChI Chair in Teacher Education and the CITE team generate knowledge relating to the realisation of quality teaching and learning in South Africa. In doing so, the centre’s work revolves around the professional development of teachers, at the stage of initial teacher education and continuous professional development, both in policy and practice.
Prof Yusuf Sayed
sayedy@cput.ac.za
The centre has invested in the development of research capacity among a pool of emerging and established researchers working in the area. A key aspect of CITE is to build national and institutional research capacity in the field of teacher education.
To achieve its goals, CITE has a number of large-scale research projects that are at various operational stages. Each project is conducted in consultation with multiple stakeholders to ensure project efficacy and impact. CITE team members work across projects to maintain quality standards and the development of multi-skilled researchers.
In 2018, the centre had 15 doctoral candidates and five master’s students who are supervised by the director and the deputy director. Two doctoral candidates and three master’s students completed their theses in 2018. Four doctoral candidates and two master’s students are scheduled to submit their theses by June 2019. Efforts were made to include the centre’s postdoctoral fellows as cosupervisors as a way of building their capacity in student supervision. A key goal and impact of the centre’s work is to assist postgraduate students, postdoctoral fellows, and research associates in building their individual intellectual bases and fieldwork
skills in research, and thus add to academic knowledge and skills development in South Africa. This is one of the foremost achievements sought by CITE over the long term.
The bulk of the research funding for the Research Chair is spent on generating empirical data that allows for the production of research outputs as well as the funding of student bursaries (only some fully funded) for about 15 postgraduate students. In 2018, CITE produced seven accredited journal articles, two technical per policy reports, two books and 14 book chapters. Eight keynote plenary addresses were delivered by the Chair.
Furthermore, a significant allocation of the funding is used to support postgraduate students and postdoctoral fellows to convert their research into research outputs, both in written form and in presentations at national and international conferences. The majority of the postgraduate students attended and presented at a national conference in 2018, with a further six postgraduate students presenting at international conferences (using other external funds generated by the SARChI Chair).
The SARChI Chair, Prof Sayed, received a South Africa Education Research Association (SAERA) Research honours Award in 2018. This award is in recognition of his remarkable contribution made to education as a South African scholar.
The research partnerships established in the southern African region in 2017 were enhanced in 2018, thus advancing the knowledge of teacher education in significant ways which can be seen as a good return on investment.

RESEARCH REPORT 2018 123 hu MAN & SOCIAL DYNAMICS 5
Deepening teacher education research
The NRF has renewed the Research Leadership Chair in Teacher Education for another five years. Prof Yusuf Sayed, Research Leadership Chair in Teacher Education, said the renewed funding was testament to the hard work and effort of all members of the CPuT-based Centre for International Teacher Education. “It is an affirmation of the support we have received from the university and faculty,” said Prof Sayed. “It reflects a deepening of research at CPuT and its commitment and values as becoming a researchintensive university.”

For the next phase, the Chair and CITE will continue deepening their work, which includes developing new knowledge about teacher education, building research capacity and strengthening national, regional and international research partnerships. “We will also seek to continue to actively enhance the impact of our research in the coming phase,” he said.
“I am pleased to communicate that the panel has recommended that funding for the Chair continue for the next five-year cycle and that this recommendation has been
accepted by the NRF,” Dr Rocky Skeef, NRF Executive Director: Reviews and Evaluations, said in a note to CPuT.
CITE was founded in 2014 on the understanding that teacher preparation and teacher classroom performance were
Prof Yusuf Sayed, South African Research Chair in Teacher Education and Director of the Centre for International Teacher Education (CITE), has received the South African Education Research Associations’ (SAERA) honours Award recognising his outstanding contribution to the field of education. Prof Sayed received the award at the SAERA annual conference held in Pretoria in October.
Prof Sayed was ecstatic about receiving this accolade from the largest education research association in South Africa. “It is a testament to the search for equitable and quality education in South Africa and researching the work of teachers, teacher education and teaching,” he said. “Further, it is a recognition of continued and consistent engagement with South African research and policy analysis before and after the advent of democracy in 1994.”
at the heart of enhancing education and ensuring it acts as a vehicle for achieving equity and transformation in society. CITE is a national, regional and international centre of excellence for research and policy dialogue about education policy and teacher education.
he went on to say that the achievement bore testimony to the confidence and support in the research work that has been done and would continue to be done in CITE by staff members, postgraduate students and research partners. “It reflects the fact that CITE is a leading national, regional and global institute and the key to the research architecture of CPuT. The university needs to continue to provide the support and commitment it has shown to date to allow CITE and its members to flourish and grow.” he added that CITE has developed a new five-year research plan starting in 2019, which requires the vision and foresight of all role players in the university and in the broader education sector.
“Congratulations on receiving this prestigious SAERA award that recognises your outstanding contribution to education research in South Africa,” said Prof Marshall Sheldon, Acting DVC: RTIP.
RESEARCH REPORT 2018 124 hu MAN & SOCIAL DYNAMICS 5
excellent education research rewarded
Academic’s
Esteemed academic, Prof Yusuf Sayed, welcomes renewed NRF funding
Literacy Development and Poverty (CPUT Research Chair) FACULTY OF eDUCATION


The purpose of the Literacy Development and Poverty research unit is to investigate, monitor and assess the educational and socio-economic factors that influence learning in disadvantaged communities in the Cape Flats, and to find possible reasons for low scholastic achievement. The project seeks to deepen understanding of the intersectionality of race, class and disadvantage in the context of schooling for poor children. A key objective is to bridge the current policy-practice gap in literacy development in south Africa and contribute to evidenceinformed policy making.
chettyr@cput.ac.za
Milestones include the publishing of two journal articles: hN Phillips & R Chetty ‘Enhancing teacher training skills by strengthening the teaching practice component’ in Education and Training; and GF Joubert & R Chetty ‘The benefits of a gross motor development programme on the lives of rural marginalised multi-grade primary school learners in the Western Cape’ in The Anthropologist. An additional two articles were accepted for publication: R Chetty & L Meyer ‘A holistic approach to personal transformation in the youth sector’ in Alternation; and M Baraldo & R Chetty ‘On-line, off-line identities: Social media, psychological bifurcation and vulnerability to cyberbullying in a Cape Town case study’ in Acta Criminologica
The research unit hosted Prof Baz Dreisinger from the City university of New York (CuNY). In January, she facilitated a seminar at the Mowbray Campus titled ‘Prison to college pipeline: Reflections on
higher education and incarceration’. Dr George Joubert was invited as visiting scholar to Queens College CuNY in April. Prof Chetty was appointed as member of the Subject Expert Group (English) to develop self-directed learning materials for the National Senior Certificate for Adults Qualification and to serve on the Academy of Science of South Africa (ASSAf) Education Peer Review Panel, tasked with the accreditation of education journals.
Prof Chetty also presented a keynote address at the Centre for Conflict Resolution Colloquim on Decolonisation or Development: The role of higher education in South Africa in March. The title of his presentation was ‘The master’s tools cannot dismantle the master’s house’. Three postgraduate students from the research unit graduated in April – two with doctoral degrees (George Joubert and Lucille Meyer) and one with a master’s degree (Jennifer Stead).
RESEARCH REPORT 2018 125 hu MAN & SOCIAL DYNAMICS 5
Prof Rajendra Chetty
R ese ARC h C h AI R
Work-Integrated Learning (WIL) (NRF sARChI Chair)

FACULTY OF eDUCATION AND NOW CPUT As A WhOLe
Prof Christine Winberg
winbergc@cput.ac.za
Prof Winberg was awarded three research grants in 2017 (in addition to the south African Research Chair). she was awarded an NRF/sTINT (swedish Foundation for International Cooperation in Research and higher education) three-year grant for ‘science, technology, engineering and mathematics (sTem) pedagogical competence’ (Ref sTINT 160829186851). she was also awarded a three-year grant on engineeringin-Context under the Department of higher education and Training’s (DheT) existing engineering education Capacity enhancement Programme (eeesCeP), funded by Newton and the Royal Academy of engineers. she was awarded a one-year continuance on her DheT National Collaborative Teaching Development Grant on a National Postgraduate Diploma in higher education Teaching and Learning, and received an NRF incentive grant for rated researchers. In 2018, she was awarded an additional grant for ‘Work-Integrated Laboratory Learning’ from the DheT’s University Capacity Development Grant.

Prof Winberg continued as leader of the Work-Integrated Learning Research unit (WILRu), which celebrated its 16th Anniversary in 2018. She and the WILRu team members serve on a number of scholarly journals’ editorial and review boards, are a part of CPuT and NRF research committees, and undertake the peer review of research applications and journal submissions. WILRu is extremely proud of the work of the postgraduate scholars, who contribute to the development and sustainability of WILRu and whose work is growing the field of Work-Integrated Learning nationally and internationally.
As mentioned in Prof Mda’s section above, the output and impact of this research unit has increased to such an extent that the unit was upgraded to an institute at CPuT early in 2018. This institute will service the whole of CPuT and no longer only the Faculty of Education.
RESEARCH REPORT 2018 126 hu MAN & SOCIAL DYNAMICS 5
R ese ARC h C h AI R
Work-Integrated Learning in TVeT Colleges (eTDP seTA Research Chair)
The eTDP seTA provided funding to CPUT to establish a Research Chair for Work-Integrated Learning (WIL) and Recognition of Prior Learning (RPL) in August 2015. The agreed focus of the Chair was that there would be three research projects up to march 2018:

1) Identification of current WIL practice and staff development needs of TVET college lecturers
2) Research into and facilitation of the development of WIL components of staff qualifications, in response to the researched staff development needs
ndunaj@cput.ac.za
3) Investigation of ETDP SETAfunded RPL practices and processes with the purpose of developing best practice models for RPL in relation to WIL
The first two research projects were conducted from the beginning of 2016 to October 2017 and the RPL research project from November 2017 to January 2018. For the RPL research project, focus group interviews, individual telephone interviews and document analysis were used to gather data from TVET colleges based in four South African provinces (North West, Eastern Cape, KwaZulu Natal and Western Cape). The project was financed by the ETDP SETA and focused on Level 4 qualifications in Early Childhood Development and Community Development in 2015. The documents that were used included students’ portfolios of evidence, project managers’ and assessors’ written reports, and minutes of meetings co-ordinated by the ETDP SETA to discuss RPL issues with staff involved in the project. The research findings indicated that the ETDP SETA adopted a hybrid model
perspective of RPL that suits a variety of different purposes and meets a variety of needs, also that the ETDP SETA’s RPL practice is a good intervention that needs to be improved and supported. Areas of improvement and challenges for the ETDP SETA’s pilot project were identified and recommendations were put forward.
Research on all the three projects was completed and research findings and recommendations were presented in a comprehensive report that was submitted to the ETDP SETA on 23 March 2018 and also to CPuT’s Faculty of Education.
highlights 2015-2018
CPuT was funded by the DhET’s Teacher Education Directorate to co-ordinate and oversee a national research project that would result in the development of a national WIL curriculum framework for TVET staff qualifications. The intention was that the framework would be adapted by the faculties of education of sixteen participating South African hEIs when they develop the following TVET staff qualifications:
1) 120 credit Advanced Diploma in Technical and Vocational Teaching and Training (TVTT) with 8 WIL credits (2 weeks in an industry-based workplace for technical and vocational specialisations)
RESEARCH REPORT 2018 127 hu MAN & SOCIAL DYNAMICS 5 Prof Nothemba Nduna
FACULTY OF eDUCATION
R ese ARC h C h AI R
2) 360 credit Diploma TVTT with 36 WIL credits (9 weeks in an industry-based workplace for technical and vocational specialisations)
3) 480 credit BEd TVTT with 64-80 WIL credits (16-20 weeks in a workplace for technical and vocational specialisations)
CPuT was also requested to develop a WIL curriculum framework for the capacity development of Community College practitioners through the following qualifications:
1) 120 credit Advanced Diploma in Adult and Community Education and Training (ACET) with 8 WIL credits (2 weeks in a relevant workplace)
2) 360 credit Diploma ACET with 36 WIL credits (9 weeks in a relevant workplace)
3) 480 credit BEd ACET with 64-80 WIL credits (16-20 weeks in a relevant workplace)
• The national WIL curriculum framework was completed and presented for input by different stakeholders at the DhET National Indaba in Johannesburg.
• CPUT’s Faculty of Education plans to offer a range of industry-based WIL staff qualifications for TVET and ACET sectors from 2021. Some of these qualifications have already gone through various accreditation processes and RPL is regarded as crucial for the accreditation process. In addition, CPuT plans to offer an Advanced Diploma in Education with a WIL specialisation (ADE-WIL) and a Postgraduate Diploma in Education with a WIL component (PG DIP Ed). CPuT could thus become a national centre for teacher education of TVET and ACET lecturers due to its expertise in WIL capacity development and research.
• Eight papers were presented at the Research Symposium held in Germany in June, at the 2018 WIL Africa Conference in Durban in July, and at the Join Forces Conference in Namibia in October-November.

• The DHET’s Research Directorate invited the Chair to present the research findings at its 5th Annual Research Colloquium ‘Radically Transforming TVET Colleges through Empirical Research’ in East London in September.
• A summary of the presentation was published in the DhET Research Bulletin on Post-School Education & Training No. 7 and in the DhET’s Research Colloquium Proceedings Report (both available at www.dhet.gov.za)
• The project attracted two doctoral candidates to register in the Faculty of Education.
RESEARCH REPORT 2018 128 hu MAN & SOCIAL DYNAMICS 5
W
ORK -I NTEGRATED L EA RNING IN T VET C OL LEGES ( ETDP SETA R ES EARC h Ch AI R )
Centre for Tourism Research in Africa (CeTRA)
FACULTY OF BUsINess & mANAGemeNT sCIeNCes
CeTRA is the research hub for tourism-related research based in the Tourism Department.
CeTRA works in collaboration with three departments within the school of events, Tourism & hospitality (seTh), namely, sport management, Tourism & events management and hospitality management. Its mandate is to highlight CPUT’s contribution to tourism and hospitality teaching and research in Cape Town, the Western Cape, south Africa and internationally. In addition, it facilitates research activities in the tourism, hospitality, sport and events fields. It aims to bring together university researchers and practitioners domestically and internationally in order to find feasible answers to applied research questions. CeTRA is also mandated to encourage focused research clusters incorporating researchers and students from various CPUT departments and from outside the university.
National Department of Tourism research project
The National Department of Tourism (NDT) has appointed CPuT to conduct research. Over the past few years, CETRA has led various projects in this regard. In 2018,

CETRA conducted a study to determine the employment profile of restaurants within the South African tourism sub-sector of hospitality. The study aims to equip tourism stakeholders to gain a better understanding of the geographical spread, employee demographic profile and employment dynamics of the South African restaurant sub-sector. Ms Mandisa Silo is the project director and the lead researcher is Dr Tshinakaho Nyathela.
As part of the NDT research project activities, a number of CPuT postgraduate students and early stage researchers have been supported through student bursaries. In 2018, two master’s students within the Tourism & hospitality programme were awarded bursaries and researchers within the school of SETh received intensive training on how to conduct sensitive interviews. CETRA researchers also attended the annual Tourism Research Seminar hosted by NDT, and postgraduate students presented posters from their studies. The two studies supported by the NDT focus on employees’ reward systems in selected Cape Town hotels (Mzukisi Cwibi) and on staff turnover within the kitchen department of restaurants in the
Cape Metropolitan area (Athi Ntwakumba). The activities are in their final stages and study findings will be presented at international conferences and published in accredited journals.
Collaboration and joint research
CETRA collaboration initiatives continue to attract additional project grants for our staff. In 2018, the centre collaborated with several institutions internationally through its LaTFuRE Erasmus+ programme. The LaFTuRE project is co-ordinated by Danube University Krems and involves 15 European and African partners. LaFTuRE aims to provide systemic and institutional conditions for the establishment of dual studies as an integral part of South Africa and Mozambique’s higher education systems. The project intends to use the postgraduate diploma in tourism management as a pilot programme to align to a dual study structure in order to produce a curriculum that is more responsive to industry needs.
The LaFTuRE project has opened great academic travel opportunities for CPuT staff, who have benefited from local study visits to Johannesburg and Mpumalanga, and international ones to Germany. It has created mutually beneficial connections between universities within the partnership – lecturers identify external examiners for postgraduate students, academics are able to exchange of knowledge, and able to engage in joint publication. As a result of the LaFTuRE project and CETRA’s collaboration with various partners, we are in the process of getting a book ready for publication.
RESEARCH REPORT 2018 129 hu MAN & SOCIAL DYNAMICS 5
R ese ARC h e NT ITY
ntlokon@cput.ac.za
Dr Ncedo Ntloko
human Performance Laboratory (hPL)
FACULTY OF BUsINess & mANAGemeNT sCIeNCes
The human Performance Laboratory (hPL), housed in the Department of sport management, provides the space and cutting-edge technology to pursue research and enhance education and technical training in terms of human performance in sport and related activities, including ergonomics.
Dr Sacha West wests@cput.ac.za

The hPL continues to provide a space for the Department of Sport Management to pursue research and enhance student education and technical training in relation to performance in sport and related activities. Its function can be divided into the following inter-related components:
• Teaching and lear ning
• Research, including interdisciplinary collaborative research
• Facilitation of postgraduate supervision
• Exercise testing and rehabilitation
• Community engagement
Dr Sharhidd Taliep
talieps@cput.ac.za
Third-year Sport Management students remain involved in a community engagement project called Active Kids at underprivileged schools. They learn practical skills in the hPL and then apply these as they engage with the children. The project continues to receive complimentary feedback from the school principals and teachers.
Our collaborative research partnerships continue with uCT’s Exercise Science and Sports Medicine unit, Western Province Cricket Association, Cricket SA, Western Province Rugby and SARu, CPuT’s Department of Emergency Medical Care, CPuT’s Oxidative Stress Research Centre, and the Rooibos Foundation/Council.
A pilot research study has been conducted to investigate rooibos as an ergogenic aid and its effect on exercise performance. The original exercise protocol previously used in the hPL was modified to enhance the physical stress of the participant at both an aerobic and anaerobic metabolic level. As a result of this pilot research work, the new project has received funding support from the Rooibos Council and will be conducted by the hPL in 2019.

RESEARCH REPORT 2018 130 hu MAN & SOCIAL DYNAMICS 5
R ese ARC h e NT ITY

RESEARCH REPORT 2018 131 hu MAN & SOCIAL DYNAMICS 5
eCONOmIC GROWTh & INTeRNATIONAL COmPeTITIVeNess

Introduction by Dr Harry Ballard
The weak prevailing social and economic trends and outlook within south Africa’s macro-environment are reflected in the following selected indicators, namely 60% of the population is urbanised which is estimated to increase by 70 % in 2030. Only 40% of the working age population is employed nationally, compared to the international norm of 60%. Furthermore, the national population growth increased by 35% between 1996 and 2015, with the national median household income calculated at R3 260 per month. The foregoing is manifested with the Gini coefficient (the gap between the rich and the poor) declining from 0,63 (2001) to 0,61 (2013).
To counter these trends and to facilitate positive and sustainable social and economic development and growth, the National Development Plan 2030 (NDP 2030) was issued by the National Planning Commission within the SA Presidency, and it included the following goals: To reduce the unemployment rate from 25% to 14% in 2020 and to 6% by 2030; to increase the labour force participation rate from 54% in 2016 to 65% and to create 11 million industrial jobs by 2030.
The NDP 2-10 has identified the following sectors/resources as critical to reduce unemployment and thereby stimulate and grow the local economy from the target of 5% were identified as small, micro and medium enterprises (SMMEs) and non-retail sectors such as tourism as well as the development of skills.
One of the strategies presented by the NDP 2030 to achieve these challenging goals is to improve education, training and innovation. universities were categorised and included in the post school sub-sector, with the non-negotiable brief to “define their niches to enhance their ability to
contribute to national objectives”. The NDP 2030 further proposes that universities be strengthened to cultivate a culture of research and development and be assisted to access third-stream income from the private sector.
however, there is currently extensive global technological development and innovation so as to increase productivity, to be smarter, to reduce waste and to customise to meet client expectations, referred to by academics as the Fourth Industrial Revolution or the Industry 4.0 concept. This impacts on services and products, business models and markets, work environments and skills development. In the business and management science sphere, research should also include the impact of Industry 4.0 on society, ethics and governance, and the human element within organisations.
In light of this, Focus Area 6, which relates to economic growth and international competitiveness, has been correctly defined, formulated and positioned in the RTI strategy to contribute to the national objectives and imperatives, so as

RESEARCH REPORT 2018 132
6 ballardh@cput.ac.za
to achieve the social and economic development goals. Due to the ever-changing and dynamic macro (global and local), intermediate (society) and micro (CPuT) environment, and with the advent of the Industry 4.0 paradigm, two existing niche areas have been reviewed with the addition of four new niche areas.
The current six niche areas are:
- Intellectual capital (skills development)
- Tourism
- Events and management
- Brand and digital media management
- Business innovation and incubation
- Graduate employability and accounting practices in accounting entities
The six niche areas include 44 registered research projects which have been defined, scoped, designed and planned with formulated indicators and targets. A number of research projects are student-driven within the Faculty of Business & Management Sciences, which is a further attempt to comply with the NDP 2030 proposal that by 2030 over 25% of the university enrolments be at postgraduate level and that the number of graduate and postgraduate scientists be doubled.
Students’ innovation to transform healthcare services

Three CPuT students have started a commercial enterprise aimed at bridging the gap between the public and private healthcare systems by focusing on innovative solutions to transform primary healthcare services. Wela healthcare was founded by third-year entrepreneurship students Ms Naledi Loni, Mr Siyanda Mdukulwana and Mr Phila Zita. The trio said they were determined to provide accessible, affordable, and efficient primary healthcare services in pre-urban areas using innovative methods.
“The shortage of primary healthcare facilities such as clinics has led to overcrowding in hospitals as many patients bypass the former and go straight to the latter without the necessary referral”, said Phila. To solve this problem, Wela healthcare proposes delivering the standard and extent of services offered in private hospitals in pre-urban areas by utilising a medical container clinic converted from shipping containers. The services of the Wela healthcare centre include medical examinations, diagnosis and dispensing over the counter medication.
Wela healthcare has partnered with the Council for health Service Accreditation of Southern Africa for the accreditation of the company’s services to patients, while the Society for Private Nurse Practitioners will help verify the qualifications of the company’s nurses. The Western Cape Public Private health Forum mentored the trio in affirmation of the urgent need for their services.
The Wela healthcare Centre’s purpose is to promote health, and to help prevent illness and further complications through health promotion, early detection, suitable treatment and appropriate referral.
RESEARCH REPORT 2018 133 hu MAN & SOCIAL DYNAMICS 5
Mr Siyanda Mdukulwana and Mr Phila Zita, two of the founders of Wela healthcare
Business success in this digital era requires e-leadership
In order to thrive in this era of ever-changing digital technology, business organisations require leaders who are independent thinkers, and are self-confident, innovative, creative and resultsoriented. This kind of phenomenon is termed e-leadership.
This view was shared by Dr Michael Twum-Darko, academic head of Postgraduate Research at the Graduate Centre for Management, during the Digital Transformation Talk hosted by the CPuTbased Centre for Enterprise Resource Planning in Africa (CERPiA). Dr Twum-Darko said that in addition to e-leadership, technical infrastructure and enterprise architecture were also required. he added that people needed to appreciate that while business content may not have changed over the last couple of years, the context of doing business has evolved. he argued that digital technology and the internet of things were now being used to integrate business process and office automation with industrial processes and factory automation, and that this was a convergence towards the establishment of cyber-production systems.
CERPiA manager, Mr Jerry Ansen, said the centre trained academics from Africa to train others in the SAP software programme. “Our task is to reach out to African universities so that they can skill and train their students,” he said. Since 2012, the centre has trained over 6 000 graduates as well as 575 lecturers and professors in Africa.
Students in the h um an Resources Management Department who recently completed the SAP training were awarded certificates at the event. Mr Ansen added that the graduates, who were nominated to participate in the training by their department, all obtained distinctions during the assessment. Ms Aqeela Dawood, one of the graduates, said the SAP certificate has opened many doors in industry as they have been equipped to handle all the business processes pertaining to h R management.
Advancement Director, Mr Calvin Maseko, thanked Investec for funding the training of the graduates.

RESEARCH REPORT 2018 134 ECONOMIC GROWT h & INTERNATIONAL COMPETITIVENESS 6
Staff members and industry guests with hR management students
Wholesale & Retail Leadership
FACULTY OF BUsINess & mANAGemeNT sCIeNCes
This year has unfortunately been one of limited activity due to a lack of funding. Our endeavours have been financed by left-over funds from the previous W&RseTA contract. Our main focus has been on finalising the publication of journal articles and the distribution of findings from our research to the retail sector. In addition, continuing negotiation with the W&RseTA culminated in the signing of a new two-year contract in November 2018 to continue the Chair until march 2020. Unfortunately, this contract negotiation and signing took most of 2018 to finalise, and so there is now only about a year left to complete all the contract activities.
Prof Roger Mason


masonr@cput.ac.za
Our publication achievements for the year comprised six articles in accredited peer-reviewed journals and 36 short articles in five retail industry practitioner magazines published by SA Media & Digital holdings. These were summaries of past WRLC projects and articles about the Retail Academy, which is moving into its third year of operation.
The Retail Academy has been hugely successful, running an accredited QCTO three-year retail programme and a series of short courses in retail, for managers from the major retailers and retail franchisees.
some students’ comments about the programmes:
“All of this for me has been an absolute life changing experience”
– Retail Manager
“The Stock Management module has helped me change the entire receiving process and layout at my store; productivity is now faster, and we have a lot less shrinkage and damages” – Retail Store Manager
“The programme has helped my confidence immensely and I have grown as a person; I have become a more respected figure in the office” – Retail Operations Manager
“Having applied the knowledge I gained and having made better business decisions, a year and a half into the programme, I was promoted to Regional Manager” –Regional Manager
“I was blown away by what I was learning – every module has had an impact on me” – Retail Store Manager

Our international collaborations with Baden-Württemberg Co-operative State university in Ravensburg continued, with visits of students and staff to Germany and a visit from Prof Dr Thomas Dobbelstein from Ravensburg. Research collaboration with Prof Dobbelstein and Prof Dr Wibke heidig of Albstadt-Sigmaringen university of Applied Sciences in Germany resulted in a publication in a top retail journals.
As in previous years, we sent two staff members for three-week visits to Ravensburg in 2018. Ms Andiswa Mrasi, Manager of the Retail Academy, and Mr Wayne Jooste, a retail lecturer, learnt
RESEARCH REPORT 2018 135 ECONOMIC GROWT h & INTERNATIONAL COMPETITIVENESS 6
R ese ARC h C h AI R
Prof Dr Thomas Dobbelstein Prof Dr Wibke heidig
6 about teaching and learning in a European environment. Furthermore, as part of our exchange collaboration, three retail students visited Ravensburg, and attended their one-term international student exchange programme.

have been important in the development and academic enhancement of two of our doctoral candidates.

On the expectation that the W&RSETA contract would be confirmed and signed, work began on identifying and developing specifications for further research projects. Ten such projects have been identified to meet the industry and W&RSETA requirements. These projects will be conducted in 2019.
Thus, although we have not had funding for two years, through careful financial management and control and judicious selection of activities, the Wholesale & Retail Leadership Chair has continued to operate and maintain a presence in the industry.
Our nGap lecturer, Mr Maphelo Malgas, spent six weeks at the Institute of Retail Studies at Stirling university in Scotland, a collaboration that resulted from a visit to Stirling university by Prof Mason in 2016. One of our lecturers, Ms Nicola Pietersen, spent three weeks at Langara College in Vancouver, which is a Canadian public degree granting institute. These two exchanges
Six papers were published in accredited journals: ‘Critical skills and knowledge to succeed in the township liquor retail industry’ (Journal of Business and Retail Management Research); ‘Preference for a career in retailing: A question of personality’ (International Review of Retail, Distribution and Consumer Research); ‘Transformation in the wholesale and retail sector in South Africa: The role of internships’ (Journal of Business & Retail Management Research); ‘A management model for the economic sustainability of the retail cooperative sector in South Africa’ (International Journal of Applied Business and Economic Research); ‘A model for wholesale and retail assessment centres in regulated occupational learning in South Africa’ (African Education Review); ‘Are cooperative relationships a viable option for accessing resources for female informal traders in South Africa?’ (Journal of Business & Retail Management Research)

RESEARCH REPORT 2018 136 ECONOMIC GROWT h & INTERNATIONAL COMPETITIVENESS
Three retail exchange students participating in an excursion to Switzerland with their German student colleagues
Maphelo Malgas in Stirling, Scotland
ARTICLE CONVENIENCE STORE RETAILER hARDWARE RETAILER FMCG RETAILER INDEPENDENT TRADER PhARMACY RETAILER PETShOP PITSTOP Co-op relationships in informal retail #1 #1 #1 #1 W& R Leadership Academy #2 #2 #2 #2 Strategy alignment of W&R with NDP #3 #3 #3 #3 #3 e-Business and skills in retail #4 #4 #4 #4 Employment equity in retailing #5 #5 #5 #5 SA retail sector & BRICS trading bloc #6 #6 #6 #6 #6 Retail Academy – Short courses #10 #10#10#10#10 Skills shortage in the retail sector #11 #11#11#11#11
Jamie Kayler with Andiswa Mrasi, Mihle Tyala and Siviwe Majali
Wh OL ESALE & R ETAIL L EA DERS h IP Articles published in SA Media holdings practitioner magazines
Website Attributes Research Centre (WARC)

Introduction
WARC does research in the knowledge economy, producing outputs to guide industry on decisions relating to search engines, internet marketing and website design. During 2018, most of WARC’s research work focused on website content and how search engines read and interpret it.
Fake news
Prof Melius Weideman

weidemanm@cput.ac.za





Fake news has received much attention lately, especially since Facebook’s interaction with the 2016 Trump election campaign made headlines the world over. Fake news is basically just some information present on a webpage, which someone considers to be false, incorrect or incriminating.
Research done by WARC has proven that the advances in technology over past decades have made it very easy for any computer literate internet user to create a website, and put any information on it, without this being checked for accuracy. In fact, social media is exactly that – social media platforms like Facebook, Twitter and Instagram simply provide a content management system (CMS) user interface where any member can post any information, pictures, etc., without the content being checked or vetted in any way.
When search engines crawl these social media pages, this information is then listed on search engine result pages, where unsuspecting users can read it, not understanding that everything on the internet should not be
presumed to be the truth. WARC has been contracted to deliver expert witness testimony in a legal matter between a medical practitioner and the health Professions Council of South Africa (hPCSA), regarding content which was found on some business directory services. This content was not verified and incriminated the medical practitioner. This could be considered a another form of fake news.

Research publications and search engines

A number of publications were produced in 2018 focused on finding research publications on the internet in various ways.
Google Scholar has become popular amongst academics and students as a first port of call when looking for academic documents, as opposed to using academic databases such as EBSCOhost and Emerald. Research has exposed the methodology used by Google Scholar, and a system has been proposed to ensure that academics’ publications can easily be indexed by Google Scholar.
The practice of using voice search (instead of typing a search query) has increased dramatically during the past few years. It has been claimed that just under 60% of consumers have turned to voice search to retrieve information on local businesses during 2018. WARC research has established guidelines for researchers to ensure that internet users using voice search on Google Scholar are very likely to find the publications they seek.
RESEARCH REPORT 2018 137 ECONOMIC GROWT h & INTERNATIONAL COMPETITIVENESS 6
OF INFORmATICs & DesIGN R ese ARC h C e NT R e
FACULTY
Past and present WARC postgraduate students who have made contributions to WARC’s research
Technology station: Adaptronics Advanced manufacturing Technology Laboratory (Adaptronics AmTL)
FACULTY OF eNGINeeRING & The BUILT eNVIRONmeNT
Introduction
Prof Oscar Philander

philandero@cput.ac.za
In January 2007, Prof Oscar Philander established the CPuT Adaptronics Advanced Manufacturing Technology Laboratory (Adaptronics AMTL). The primary objective of the unit is to specialise as a national manufacturing, research and educational resource centre for adaptronic technologies in South Africa. Adaptronics is technology that integrates sensor and actuator functions into materials, components and structures so that they may react to environment stimuli thus making them intelligent.
The Department of Economic Development and Tourism (DEDAT) of the provincial government of the Western Cape provided grant funding to establish the Adaptronics AMTL, while the DST through the AMTS, now called the Technology Innovation Agency (TIA), provided grant funding for capital equipment purchases. Based on the technology activities, innovation, and successes of the Adaptronics AMTL, it was officially incorporated into the TIA’s Technology Station programme in March 2013, and became the 18th Technology Station in SA. A vision and mission for the unit was formulated, focusing primarily on developing human capital in scarce skills with a specific drive towards
innovation, technology, and commercialisation for the South African engineering industry.
Vision of the Adaptronics AMTL
• To be at the heart of technology education, research and innovation in Africa for Africa
• To establish an empowering environment that supports the development of socially responsive and accomplished technologists and engineers through workintegrated learning based on mutually beneficial partnerships with industry and the community
Mission of the Adaptronics AMTL
• Develop and sustain an empowering environment where, through teaching, learning, research and scholarship, our students and staff, in partnership with the community and industry, are able to create and apply knowledge that contributes to development
• Create opportunities for students to apply knowledge in real-life situations
• Contribute to socioeconomic development
RESEARCH REPORT 2018 138 ECONOMIC GROWT h & INTERNATIONAL COMPETITIVENESS 6
T e C h NOLOGY
s TATION
CPUT Solar Flyer takes off
CPuT unveiled its entry into the Sasol Solar Challenge 2018 in September, when students, lecturers and learners from Portland high in Mitchell’s Plain gathered to watch team members lift the veil on the CPuT Solar Flyer.

The team comprises students and staff from the Mechanical Engineering and Mechatronics Department at CPuT’s Bellville Campus. The car was fabricated in-house at the TIA Adaptronics AMTL research unit’s workshop, also on the Bellville Campus. The flyer’s frame was made of aluminium and covered in polyfibre composite while the solar array was assembled from commercially available panels. The hub motors were imported kits mounted in motorcycle wheel rims with hydraulic disk brakes.
CPuT students took part in the Sasol Solar Challenge South Africa for the first time this year, but the longterm plan is for the car to be used as a tool to entice
learners into studying engineering. The Sasol Solar Challenge is a biennial event in which more than 20 national and international teams compete to cover the most distance over eight days. The car was taken to Pretoria from where it set off on 22 September on a race to Stellenbosch, arriving there on 29 September.
Welcoming guests at the launch, Prof Anthony Staak, DVC: Teaching & Learning, pointed out that securing funding for the project turned out to be the easier part as the team had only three months in which to build the car in comparison to competitors who had been busy preparing for over a year. “Where others saw insurmountable obstructions, our team simply saw opportunities. As the building progressed, designs were adjusted to ensure deadlines were met,” he said. “In the spirit of most CPuT projects, this solar car project is multidisciplinary and it fits in with the university’s vision to be at the heart of technology education and innovation in Africa.”
RESEARCH REPORT 2018 139 ECONOMIC GROWT h & INTERNATIONAL COMPETITIVENESS 6
CPuT’s Solar Flyer team
6
• Facilitate the integration of community engagement activities with teaching, learning and research in collaboration with relevant stakeholders
Alignment with TIA objectives
The vision and mission of the Adaptronics AMTL, operating as a TIA Technology Station, was formulated to achieve the overall objectives of the Technology Station Programme. The vision and mission have given birth to technology progammes/focus areas that ensure high level skills development in science, engineering, technology and innovation. Programmes include the International Formula Student Academic Motorsport Competition through hosting of P1/P2, the education of BTech and postgraduate students, and the development of knowledge products through postgraduate projects in the aeronautics and maritime sectors. These programmes are primarily student-orientated and guarantee a high level of competence in university graduates taking up positions in academic environments and/ or technology-based SMMEs. Furthermore, the Adaptronics AMTL also engages with industry partners, regional and national government departments, other higher education institutions (hEIs), and national research facilities. These engagements provide technical assistance and technology development focusing on the government’s drive towards localisation.
The management of the Adaptronics AMTL consists of Assoc Prof Oscar Philander, director of the technology station and associate
professor in the Department of Mechanical Engineering; Mr Mornay Riddles, technical manager of the technology station and a senior lecturer in the Department of Mechanical Engineering; and Mr Eugene Erfort, operations manager of the technology station and a lecturer in the Department of Mechanical Engineering. The technology station employs a further 18 technical and administrative staff members. Activity breakdown for the financial year 2018-2019 comprises service delivery (projects, testing, training, product development, etc.), project administration (reports, research, quotations, invoicing, procurement, etc.), and outreach (assessment, audits, marketing, client meetings/ interactions).
The majority of man-hours in 2018-2019 were spent on two projects for the South African Department of Environmental Affairs, Directorate Oceans and Coasts: ‘Development of a coastal observer platform for oceanographic and meteorological sampling along the South African coast’, and ‘Development of remotely piloted aircraft systems for APEX predator monitoring and census taking’. The Adaptronics AMTL also engaged in outreach activities with various communities and SMEs. This deployment served as a sea acceptance trial. Subsequently, 20 work packages (submitted to TIA TSP) were completed to improve the performance of the platform. Once completed in the last quarter of 2018, the platform was redeployed and is undergoing a second threemonth sea acceptance trial. The RPAS project had its own work packages (not yet submitted to TIA TSP). unfortunately, the project was set back by a
burglary in January 2018. As a result, the deliverables of this project were delayed by three to six months.
The allocated funding for these research projects was R5 335 000 for the Coastal Observer Platform Development and R1 665 000 for the RPAS/ Drone development. As mentioned, the latter funds are provided to the Adaptronics AMTL for operational expenses for these projects. upon completion, unused funds will go towards cost recovery for the Adaptronics AMTL. Based on timesheets, the total man-hours for the financial year 2017-2018 spent on these projects amounted to R4 468 160 (R2 792 480 for Coastal Observer and R1 675 679 for RPAS/drones).
RESEARCH REPORT 2018 140 ECONOMIC GROWT h & INTERNATIONAL COMPETITIVENESS
Clothing and Textiles (TsCT)
The BUILT eNVIRONmeNT
The Technology station: Clothing and Textiles (TsCT) is located in the Faculty of engineering & the Built environment on the Bellville Campus. The unit was established to provide innovation support to the clothing and textile industry to improve competitiveness. These specific services are provided to the clothing, textiles and related sectors.
Manufacturing advisory services
Mr Shamil Isaacs

isaacssh@cput.ac.za techstation@cput.ac.za http://active.cput.ac.za/tsct
Examples include manufacturing audits and assessment; industrial engineering services for the improvement of productivity, including process layout, optimising sewing methods and work-study; and advice on the acquisition of new or improved technology.
Technology support centre
The TSCT has a number of specialised technologies available at its Bellville office for research, technology demonstration, prototype development, and small-scale manufacturing. Small businesses can use the technology on an appointment basis, and staff at the TSCT also provide advice on the application and use of these machines. Charges are levied for the use of the equipment, but this is largely subsidised.
Product testing and analysis
The laboratory at the TSCT provides product testing and an analysis service to the clothing, textile and related industries, as well as clothing- and textile-related consulting services, e.g. advice on material use and care, and fabric specification development.
Product development
Services include clothing product development using CAD software for pattern development, pattern grading (sizing), marker making (maximising the material utilisation before cutting), 3D body scanning and 3D simulation on an avatar using data extracted from the 3D body scanner.
Output for 2018
Income for 2018
RESEARCH REPORT 2018 141 ECONOMIC GROWT h & INTERNATIONAL COMPETITIVENESS 6
New businesses supported 87 Repeat businesses supported 117 Tests conducted for business 489 Products developed 105 TIA: Scale-up project SMMEs supported 633
Technology Innovation Agency grants R3 734 000 Cost recovered from SMMEs and other grants R1 804 000
T
C
FACULTY OF eNGINeeRING &
e
h NOLOGY s TATION
Flow Process and Rheology Centre (FPRC)
FACULTY OF eNGINeeRING & The BUILT eNVIRONmeNT
The Flow Process and Rheology Centre, founded in 1995, applies the fundamental principles and techniques of rheology to solve industrial problems such as deformation and flow under different shear, material structure and process flow conditions. since its inception the group has produced more than 100 peerreviewed publications. Prof Fester took over leadership of the group in 2017 in a planned succession development.
The centre’s core activities include:
Prof Veruscha Fester

festerv@cput.ac.za
• Rh eological characterisation and modelling of concentrated emulsions, suspensions, solutions and polymer melts and modelling of the phenomena of micro- and nanostructural evaluation involved in the mixing, pumping, transportation and storage processes of multi-phase systems
• Ul trasound Dopplerbased in-line rheometry technique for enhanced process monitoring and control of industrial suspensions
• Mo delling non-Newtonian flows in pipes, fittings, open channels and pumps
• In strumentation systems to measure in situ concentration and particle velocity in settling slurry and coarse particle flow and visualisation in pipes and complex geometries
The team members are Prof Veruscha Fester, Prof Irina Masalova, Prof Rainer h al denwang, Mr Andrew Sutherland, and Prof Raj Chhabra of the Indian Institute of Technology in Kanpur (adjunct professor).
h ighlights of 2018
Prof haldenwang and his doctoral student in Civil Engineering, Mr Willy Mbasha, made a significant contribution to the production of cement in a research project sponsored by Pretoria Portland Cement. The production of cement is a complex large scale process with many variables. Natural gypsum is ground in a mill with cement clinker to regulate the aluminate phase hydration and consequently the setting of cement systems. During grinding, the temperature increases, and the natural gypsum partially degenerates into hemihydrate, which affects the flow properties and rheokinetics of the cement matrix. The results of this work showed for the first time that the yield stress and plastic viscosity of cement paste increased at higher hemihydrate fractions due to the morphology change, not the quantity, of the ettringite formed. The hemihydrate concentrations within the suspension were also found to strongly affect the strength development of the cement microstructure. The findings can easily be implemented to improve the manufacturing process and quality control.
RESEARCH REPORT 2018 142 ECONOMIC GROWT h & INTERNATIONAL COMPETITIVENESS 6
R ese ARC h e NT ITY
To follow up on initial work done on the application of rheology of wastewater sludge, Prof Fester continued the development of a polymer dosing control system based on the rheology of the sludge and the filtrate suspended solids. If applications for funding prove successful, a prototype polymer dosing system will be developed in an effort to save polymer costs in the wastewater dewatering facilities.

Prof Irina Masalova and her team developed a criterion for the shear stability for highly concentrated emulsions. This model implies that achievement of critical values of these parameters is necessary for opening further possibility of the drop breakup.
Mr Sutherland completed manufacture of the mechanically redesigned version of the bed velocity measurement spool, for which TIA funding had been obtained. The instrument detects the presence and movement of coarse particles at the pipe wall and can measures the absolute velocity of these particles (en masse). The changes were simple, but allowed easier and cheaper manufacture, assembly and wiring of the instrument, as well as easy casting of the insulating and wear-resistant lining (polyurethane) in place around the electrodes. The sensor is finished to the same internal diameter as the pipeline and has two rings of 16 electrodes located around the inside circumference of the pipe, flush with the pipe wall. These electrodes will make contact with the fluid in the pipe. The number of electrodes can be changed depending on customer needs, for example if needed only in the pipe invert to detect settling, only two electrodes need be included. The figure below shows

the instrument’s main components prior to wiring.
The FPRC co-hosted the international SASOR 2018 Rheology Course and Conference in STIAS Stellenbosch from 25-28 September on behalf of the Southern African Society of Rheology. Prof haldenwang and postdoctoral fellows and postgraduate students presented papers. Fourteen staff members and students attended from various departments and faculties in addition to 30 national and international delegates. Prof Veruscha Fester served as the president of SASOR from 2017 to 2018.
Members of FPRC published papers in nine DhET-accredited journals: ‘The influence of grain physicochemistry and biomass on hydraulic conductivity in sand-filled treatment wetlands’ (Ecological Engineering); ‘Rheokinetics of cement paste hydration during the dormant phase’ (Applied Rheology); ‘The influence of variation in cement characteristics on workability and strength of SCC with fly ash and slag additions’ (Construction and Building Materials); ‘Effect of oil type on stability of high internal phase water in oil emulsions with super-cooled internal
phase’ (Chemical Engineering Communications); ‘Shear stability of highly concentrated emulsions’ (Colloid Journal); ‘Emulsification of highly concentrated emulsions: A criterion of shear stability’ (Journal of Rheology); ‘FTIR spectroscopic study of head induced ß lachtoglubulin solution under flow field’ (Asian Journal of Chemistry); ‘Prediction of filtrate suspended solids and solids capture based on operating parameters for belt filter press’ (Chemical Engineering Research and Design); and ‘Biological sand filter system treating winery effluent for effective reduction in organic load and ph neutralisation’ (Journal of Water Process Engineering).
RESEARCH REPORT 2018 143 ECONOMIC GROWT h & INTERNATIONAL COMPETITIVENESS 6
Bed velocity measurement spool components prior to wiring and assembly and the output once installed]
Schematic of bed load velocity measurement system
Nanomaterials Group

FACULTY OF eNGINeeRING & The BUILT eNVIRONmeNT
The vision of the group is to investigate and provide solutions for continuous processing techniques for the large-scale production of nanopowders. The development of particles is aimed at specific applications such as sensor development, water treatment and cancer treatment. An interdisciplinary approach involving instrumentation development and advance manufacturing techniques is employed, with a special focus on technology development and scale-up.
festerv@cput.ac.za
Dr
chowdhurym@cput.ac.za
The group received funding from the TIA to scale-up the continuous flow reactor to 1000 l/hr for instantaneous colour removal of real textile effluent as well as the scaleup of the production of cobalt oxide nano-powders. The 72 l/ hr reactor was tested in Cape Town at ITL Apparel Label Solutions. The reactor was then couriered to Durban and tested at Gelvenor, Frame Knitting Manufacturers and Dyefin Textiles. Excellent colour removal was obtained for all effluents at all the companies. Not only was the colour removed, but in some cases the COD was reduced to a maximum of 65%. The performance of the reactor was dependent on the initial COD of the effluent and could be optimised by adjusting the flow rate. Design of the 1000 l/ hr system and construction of the pilot plant commenced in November. The pilot plant should be commissioned early 2019 to validate the design correlations, which means that the technology will be ready for large scale design should this system be successful. Several master’s and one doctoral student are working on the project.

Dr Chowdhury focuses on the development of high performance ceramic electrode materials for bio sensing and bio energy generation. his research has made significant

progress in developing nonenzymatic bio sensors using cobalt oxide. One of the biggest drawbacks of cobalt oxide is low electronic conductivity. A solution deposited method is used to insert dopant materials into the cobalt oxide lattice to increase its conductivity. A new plasma assisted nitrogen doping technique has been used to improve the electronic conductivity and electrochemical performance (see figure xx). his group currently consists of 13 MEng students and one PhD candidate (based at uWC). Three MEng students completed their degrees this year, and a further three MEng students are due for graduation next year.
Two papers were published by this group in 2018: ‘Solution deposition of Cu doped Co3O4 for electrooxidation of glucose’ (Revised Journal of Material Science); and ‘Co3O4/TiO2 hetero-structure for methyl orange dye degradation’ (Water Science and Technology wst2018383).
RESEARCH REPORT 2018 144 ECONOMIC GROWT h & INTERNATIONAL COMPETITIVENESS 6 Prof Veruscha Fester
Mahabubur R Chowdhury
R ese ARC h e NT ITY
7
DesIGN FOR sUsTAINABILITY
Introduction by Prof Ephias Ruhode

Design for sustainability (Dfs) focuses on the design and development of solutions to economic, environmental and social challenges facing communities. sustainable development is the ability of current generations to meet their own needs without compromising the ability of future generations to meet theirs. The concept of sustainability is also extended to designing solutions that meet human beings’ physical, emotional and social needs. Dfs is therefore design practice, education and research that, in one way or another, contributes to sustainable development. The Information Technology Department and various design disciplines are among the domains in which research is done in this focus area.
Based on assessment of research trends, societal needs and CPuT’s expertise across various disciplines, the following themes have been proposed for the development of research and innovation niche areas:
• Adaptronics
• Biomimicry

• Climate Change
• Eco-Design
• Ergonomics/Human Performance
• Green Economy
• Interaction Design
• Participatory Design
• Renewable Energy
• Service Design
• Universal Design Design and innovation consolidation have given rise to strategic spaces such as Design & Development Incubation, Research Innovation & Partnership Projects, Innovation & Commercialisation, as well as Capacity Development Courses. The two main strategic spaces are presented below.
Strategic Space 1: Research, Innovation & Partnership Projects
This niche involves all the action projects of the different international and regional projects with a project co-ordinator who manages the progress, allocation of resources, relationships and reporting. These active projects fall under this niche:
The International Learning Network of Networks on Sustainability (LeNSin) (2015-2018)
This is an Eu-supported (Erasmus+) project involving 36 universities from Europe, Asia, Africa, South America and Central America, aiming at the promotion of a new generation of designers (and design educators) capable of effectively contributing to the transition towards a sustainable society for all. LeNSin aims to improve the internationalisation, intercultural cross-fertilisation and accessibility of higher education on DfS. The project focuses on Sustainable Product-Service Systems (SPSS) and distributed economies (DE) – considering both as promising models to couple environmental protection with social equity, cohesion and economic prosperity – applied in different contexts around the world. LeNSin connects a multi-polar network of hEIs adopting and promoting learningby-sharing knowledge generation and dissemination, with an open and ‘copyleft’ ethos. CPuT plays a coordinating role for LeNS Africa.
The project activities comprise the following work packages:
• Project preparation (completed in 2016)
• Seminars design and implementation (2016)
• Design of the pilot curricular courses (2016-2018)
RESEARCH REPORT 2018 145 ECONOMIC GROWT 145
ruhodee@cput.ac.za
7
• Design and implementation of sustainability LeNS labs (2016-2018)
• Implementation of the pilot curricular courses (2016-2018)
• Decentralised conference (2019)
Design for Social Innovation and Sustainability (DESIS)
CPuT is one of three universities on the continent with a DESIS laboratory wherein biomimicry principles complement those of design for sustainability. Additionally, CPuT is the anchor hEI in the Africa‐Brazil Dialogues – a South–South initiative that interrogates replicable design interventions (such as community-based tourism) that have a strong socially-conscious focus within majority world contexts.
South Africa–Norway Programme of Research Cooperation on Climate Change, the Environment and Renewable Energy (SANCOOP)
This is a South Africa–Norway bi-lateral NRF/ Norway research project to develop design strategies for scaling up climate change approaches in the countries concerned. Two master’s and two doctoral students from South Africa have visited Oslo School of Architecture and Design (Norwegian: Arkitektur- og designhøgskolen i Oslo, AhO) in Norway. Two professors from AhO have visited CPuT. Seminars and workshops were arranged for the time when the AhO professors visited CPuT
Participatory Development with The youth (PARTy)
PARTY focuses on unemployed youth empowerment through participatory service design. Target groups are students, youth in under-served communities, refugees and unemployed graduates. Research partners include CPuT, university of Leeds, Namibia university of Science and Technology, university of Lapland and the South African SAN Institute.
Darling Intercultural Space Project
This is a collaborative programme for students and research staff from Fontys School of Fine and Performing Arts (Dutch: Fontys hogeschool voor de Kunsten, FHK) and CPUT to engage in a meaningful exchange with local authorities and residents to address the urgency and potential of designing for intercultural exchange. It is supported by Swartland Municipality and will be linked to a regional urban upgrading programme. The objective is to design and execute interventions in public spaces, over a two- to three-year programme, ultimately contributing to Darling’s socio-economic, environmental
and cultural agendas. The relation with Fontys Darling Collection is such that one of the major interventions that will be considered is an open-air theatre space, to accommodate future events such as Darling Collection. Service to the community through collaborative design process results in awareness of design and collaborative processes as well as a usable end product. This provides learning opportunities for CPuT students in a design-build studio.
Live Design, Transform Life: Relevant Technologies and Digital Services for the WellBeing of youth@risk 2017-2019
This is a transdisciplinary action research project, based on collaborative design and use of digital technology to address some of the foremost health and socio-economic challenges experienced by youth in South Africa and Namibia. We aim to work with local vulnerable groups in identifying and addressing areas for social and economic change. Because the challenges faced by youth are multidimensional and interrelated, we are working across numerous disciplines in various application areas of health (maternal health, nutrition and health, e-health for social change, well-being and quality of life) and socio-economic development (sustainable livelihoods and safety and security, especially relating to gender-based violence). While following a situated methodological approach in South Africa and Namibia, we will attempt to evaluate and ensure the transferability of results to the region, continent and eventually the global context. The overall objective of this project is to co-develop technology and digital services with youth@risk communities to improve their well-being, with a special focus on health, sustainable livelihood and safety, and aiming at digital transformation.
Strategic Space 2: Design & Development Incubation
The focus here is to design and develop innovative products, services, applications, etc. This is also the place where students work as interns to develop capacity. Notable developments are:
The Design Garage
The Design Garage at the FID was opened in 2016 to showcase and promote DfS inspired socially conscious design projects for BTech Industrial Design students.
The Kujali Hub [The Living Lab]
This is operated as a Living Lab, with student interns from multidisciplines, of multinationalities, multilevels and multicultures.
RESEARCH REPORT 2018 146
DESIGN FOR S u ST AINABILITY
146
Innovation in society
FACULTY OF INFORmATICs & DesIGN AND FACULTY OF heALTh & WeLLNess sCIeNCes
The Research Chair: Innovation in society was established in the middle of 2017 and dedicates its work to various technological, economic and social trends and their impact on the way societies function.
Prof Thomas Thurner

thurnert@cput.ac.za
A specific focus in 2018 rested on connecting CPuT to large, leadingedge technological installations in order to share our knowledge with technology providers and users and to learn from the latest developments. Many of these installations were guided by engineering considerations, while the convenience and needs of the daily usage often falls out of sight. As such, our interest rests in affordable design interventions that would make a difference for the actual users. One such activity is our work with the astronomy community in South Africa. Together with Mr Christopher hendrickse from the Industrial Design Department, we published a study on the use of design principles to improve the ergonomics of the South African Large Telescope (SALT). Our work was well received by the community, and we were invited to participate in the design of further astronomical installations.
Another great success for the Chair was the publication of a study on cognitive reliability error analysis method (CREAM) as a way to improve the quality management system at the International Thermonuclear Experimental Reactor (ITER) together with a member of the quality assurance team of the Russian project centre ITER. This is one of the most exciting research facilities of the present time, and the opportunity for CPuT to participate in such activities raises our inter national profile.

Electronic gaming was the second focus area of the Chair in 2018. On one hand, electronic gaming is a vibrant breeding-ground for technological development
that will impact greatly on many parts of society. The entire field of augmented/virtual reality – for example, the entertainment content for the self-driving car or fastrising industries like e-sports – is influenced by developments in electronic gaming. On the other hand, Cape Town’s creative environment has attracted a number of talented game developers, and electronic gaming is becoming a source of economic growth for the entire region.
The Research Chair participated in a research project with the Western Cape’s Department of Economic Development & Tourism and the City of Cape Town around a recently developed electronic game in the area of settlement reblocking. This novel approach includes all stakeholders, and allows community members to develop reblocking solutions through a negotiation process that is rules-based and protects existing rights. Also, we were able to secure a major NRF grant spanning the next three years together with Prof Elmarie Costandius from Stellenbosch university for making indigenous stories accessible to the youth through electronic games.
Prof Thurner was an invited speaker at numerous events, like the annual conference of the South African Technology Network (SATN). Most of Prof Turner’s public speeches centre on digitalisation and the future of work. Also, the Chair invited some outstanding researchers to CPuT to provide workshops to university staff in order to upscale our skill-sets. Most memorable was a lecture series by Ms Ekaterina Streltsova, patent expert at the higher School of Economics in Moscow
RESEARCH REPORT 2018 147 DESIGN FOR S u ST AINABILITY 7
R ese ARC h C h AI R
Product Lifecycle management Competency Centre
(PLmCC)
FACULTY OF eNGINeeRING & The BUILT eNVIRONmeNT
The PLmCC was launched in march 2012, and is a partnership between the French ministry of education, Dassault systèmes and CPUT. The PLmCC trains students and professionals in the art of system engineering, product design, and product lifecycle management, as well as hosting and supervising design projects. The centre uses a high-end design, modelling and simulation software suite, CATIA™ V6, to assist in the execution of these core activities.
Team members
Prof Stephen Bosman: Manager (Industrial and Systems Engineering)

Mr Donovan Cogan (Mechanical Engineering)
Mr Dennit Adams (Industrial and Systems Engineering)
Mr Shane Martin (Mechanical Engineering)
Mr Cato Meaker (BTech: Mechatronics)
Prof Stephen Bosman
bosmans@cput.ac.za
Research projects
In 2018, the PLMCC focused on projects that required the modelling of systems and their behaviours. These design projects included a special focus on space technology and additive manufacturing, such as the development of 3D printed structures using alternative materials for the F’SATI satellite programme, the thermal modelling of the ZACube-2 satellite orbital heating, and the attempt to generate a Standard Operating Procedure in the 3D print Lab (health and safety improvement). The design of a trailer for a light aircraft was also conducted by our French interns in a crossborder collaboration effort using the computer-aided three-dimensional interactive application (CATIA) platform. Design of the coal power turbines project as well as a
waste water treatment reactor model were also completed. The additive manufacturing focus began to emerge when extra support capacity in rapid testing and prototyping was needed by F’SATI.
The PLMCC has completed the supervision of one mechatronic BTech student, who was developing a claw system for a hexacopter drone. The student was trained to use CATIA™ V6, as well as CATIA Systems. This project was completed and involved modelling and simulating the claw on CATIA Systems.
The Waste Water Treatment Reactor (WWTR) project was undertaken in collaboration with CoorTech, the Chemical Engineering Department from the District Six Campus, and Prof Veruscha Fester’s textile
RESEARCH REPORT 2018 148 DESIGN FOR S u ST AINABILITY 7
R ese
C e
R e
ARC h
NT
project (the textile dyeing industry uses on average 25 000 litres/ hour of water during the dyeing and washing process, putting pressure on our natural water resources and exacerbating current water scarcity). The project was successfully completed in July 2018.
A trailer in which a light aircraft could be transported by a light motor vehicle on public roads was designed, modelled and strength tested by means of simulations. The project started as a result of a desire to test an international, cross border, design module, whereby French students here in the PLMCC in South Africa, and French students from France, work in collaboration between design labs. The overseas students were part of Supméca, a French university. Two students from Supméca completed a six-month internship at the PLMCC. The chassis was designed in France, the drawings and specifications were then also shared with the South African team, and a completed trailer door, body and wheel system was designed and tested.
Another partnership was with the hochshule Deutschland (hSD), of which is a German university partner with a PLM lab in Dusseldorf. Two students from hSD completed a six-month inter nship at the PLMCC, working in collaboration with F’SATI to help with the detailed setup of the finite element model (FEM) of ZACube-2 to develop a thermal model of the satellite.

An undergraduate Industrial and Systems Engineering student was given a project and completed a standard operating procedure in the 3D print lab. This was done by means of implementing lean

methodologies and practices such as a Five S project, with the intention of improving the health and safety of the lab.
Academic research
Various academic projects were hosted and supervised by the PLMCC in 2018:
• Two EPPEI (Eskom Power Plant Engineering Institute) projects aimed at the modelling of coal-fired turbines (Jeanssy Diankouika, MEng: Mechanical Engineering and Landry Katende, MEng: Mechanical Engineering)
• Additive manufacturing for CubeSat production (Shane Martin, MEng: Mechanical Engineering)



• Technological advances in the rapid construction of housing (Chris Bondo, MTech: Mechanical Engineering)
• Design and development of a quadcopter to supplement crop scouting in agriculture for smallholder farmers (Jonathan Moses, MTech: Mechanical Engineering)
Internships and collaborations
RESEARCH REPORT 2018 149 DESIGN FOR S u ST AINABILITY 7
uNIVERSITY COuNTRY INTERNS Supméca France2 hochschule Düsseldorf Germany 2 CPuT (Mechatronics) sA 1 CPuT (Mechanical Engineering) sA 1 CPuT (Industrial & Systems Engineering) SA 1

Deputy Vice-Chancellor (Acting): Research, Technology Innovation & Partnerships
Prof Marshall Sheldon 021 959 6203
021 959 6002
sheldonm@cput.ac.za Room 228, Administration Building, Bellville Campus
R ESEARC h D IR ECTORATE Director
Prof Dina Burger Director: Research
021 953 8455 burgerd@cput.ac.za CPGS offices, New Library Building, Bellville Campus
Managers
Mr Clement Matasane Manager: Research

021 460 3383 matasanec@cput.ac.za Room 2.8, Administration Building, District Six Campus
Co-ordinators
Ms Luyolo Kamati Co-ordinator: Research Information Management System (RIMS)

021 460 3843 kamatil@cput.ac.za
Room 2.8, Administration Building, District Six Campus
Ms Liziwe Poni Secretary to the DVC 021 959 6242 021 959 6002 ponil@cput.ac.za Room 228, Administration Building, Bellville Campus



Ms Edwina Pedro Secretary to the Director 021 953 8456 pedroe@cput.ac.za CPGS offices, New Library Building, Bellville Campus

Ms Tania holmes-Watts Manager: Research Grants
021 460 4240 021 959 6699 holmes-wattst@cput.ac.za Room 2.8, Administration Building, District Six Campus
Ms Lara Smith Co-ordinator: Research Writing, Information & Publications
021 460 3328 smithll@cput.ac.za Room 2.8, Administration Building, District Six Campus
Dr Patricia Smit Manager: Capacity Development
021 460 3539 021 959 6249 smitpa@cput.ac.za B2.07 New Engineering Building, Bellville Campus
Cheryl-Anne Wyngaard Research Finance Administrator 021 460 8473 wyngaardc@cput.ac.za Room 2.8, Administration Building, District Six Campus




RESEARCH REPORT 2018 151
D IR ECTORATE
Ms Shafeeqa Dramathendricks Research Finance Administrator


021 460 4241 hendrickss@cput.ac.za
Room 2.8, Administration Building, District Six Campus
Ms Pumza Makaula Research Grants Officer
021 460 3895 makaulap@cput.ac.za
Room 2.8, Administration Building, District Six Campus
Ms Bukiwe Sojiji NRF Intern

021 460 8359 sojijib@cput.ac.za Room 2.8, Administration Building, District Six Campus
Ms Ntombenhle Goba Research Grants Administrator





021 460 3241 gobant@cput.ac.za Room 2.8, Administration Building, District Six Campus
Ms hlengiwe Nzama Research Administrator
021 460 3887 nzamah@cput.ac.za Room 2.8, Administration Building, District Six Campus
RTI S TRATEGIC I NI TIATIVES & PAR TNERS h IP S
Prof René Pellissier Director (Acting)
021 460 3402 pellissierr@cput.ac.za
Room 6.18, Administration Building, District Six Campus
Managers
Ms hunadi Mokgalaka Manager: Research uptake
021 460 8311 mokgalakah@cput.ac.za
Room 2.302, Administration Building, District Six Campus
Administrator
Ms Mercia Bosman Administrator
021 959 6595 bosmanm@cput.ac.za
Room 0004, Administration Building, Bellville Campus
Ms Carol Wilson Manager: Internationalisation


021 460 3955 wilsonc@cput.ac.za
Room 0004, Administration Building, Bellville Campus
Ms Zinzi Nkalitshana Capacity Building Projects

021 959 6048 nkalitshanaz@cput.ac.za Room 0004, Administration Building, Bellville Campus
Mr Marvin La Meyer Research Finance Administrator
021 460 3798 lameyerm@cput.ac.za
Room 2.8, Administration Building, District Six Campus
Ms Phathiswa Swaartbooi Research Finance Administrator

021 460 3796 swaartbooip@cput.ac.za
Room 2.8, Administration Building, District Six Campus
RESEARCH REPORT 2018 152
Te am
R ES EARC h
C ENTRE FOR P OS TGRAD u AT E S T u DI ES ( CPGS)
Director
Prof Dina Burger Director: Research

021 953 8455
burgerd@cput.ac.za
CPGS offices, New Library Building, Bellville Campus
Manager
Dr Corrie uys


CPGS Statistician
021 460 3258
uysc@cput.ac.za
Centre for Postgraduate Studies
New Library Building, Bellville Campus
Team
Mr Wendal Koopman CPGS Co-ordinator

021 460 3706
koopmanw@cput.ac.za
Centre for Postgraduate Studies
New Library Building, Bellville Campus
Ms Phaphama Mhlekwa Evaluation & Monitoring Officer




021 953 8462
mhlekwap@cput.ac.za
Centre for Postgraduate Studies
New Library Building, Bellville Campus
Ms Edwina Pedro Secretary to the Director
021 953 8456 pedroe@cput.ac.za
CPGS offices, New Library Building, Bellville Campus
Ms Viwe Lalela Administrator
021 959 8462 lalelav@cput.ac.za
Centre for Postgraduate Studies
New Library Building, Bellville Campus
Ms Mtembukazi Sibindlana Bursary Administrator
021 953 8600 sibindlanam@cput.ac.za
Centre for Postgraduate Studies
New Library Building, Bellville Campus
Ms Ethne Mentoor Finance Administrator
021 959 6505 mentoore@cput.ac.za
Centre for Postgraduate Studies New Library Building, Bellville Campus
RESEARCH REPORT 2018 153
T EC h NOLOGY T RA NSFER O FF ICE
Director
Dr Revel Iyer Director: Technology Transfer Office
021 959 6431
iyerr@cput.ac.za Technology Transfer Office, Bellville Campus
Manager
Mr Marlin Fransman Tech Transfer Manager: Legal



021 959 5605
fransmanm@cput.ac.za Technology Transfer Office, Bellville Campus Team
Ms Jayde Barends Tech Transfer Officer: Marketing
021 959 5871
barendsj@cput.ac.za Technology Transfer Office, Bellville Campus
Ms Nomaphelo Ndindwa Assistant Tech Transfer Officer: Finance

021 959 4311
ndindwan@cput.ac.za Technology Transfer Office, Bellville Campus
Ms Wendy Smidt Assistant Tech Transfer Officer: Admin
021 959 5871
smidtw@cput.ac.za Technology Transfer Office, Bellville Campus
Ms Karen Martin TTO Secretary
021 959 6044 martink@cput.ac.za Technology Transfer Office, Bellville Campus
Ms halimah Rabiu Tech Transfer Officer: Funding 021 959 6879 rabiuh@cput.ac.za Technology Transfer Office, Bellville Campus

Ms Veruscha Naidoo Tech Transfer Officer: Contracts




021 959 5871 naidoov@cput.ac.za Technology Transfer Office, Bellville Campus
Ms Matamela Sigweda Tech Transfer Officer: IP 021 959 5871 sigwedam@cput.ac.za Technology Transfer Office, Bellville Campus
RESEARCH REPORT 2018 154
Acknowledgements
The 2018 Research Report is published by the CPUT Research Directorate. The editors acknowledge, with thanks, the contributions of:
• The Marketing and Communication Department at CPuT for photographs and items retrieved from the News Archive
• Dr André Steenkamp (Faculty of Education), for the Afrikaans translation of the Vice-Chancellor’s message
• Dr Zakhile Somlata (Faculty of Education), for the isiXhosa translation of the Vice-Chancellor’s message
• CPUT researchers, faculties, support units and research institutes
Editorial team
Ms Lara Smith smithll@cput.ac.za
Mr Clement Matasane matasanec@cput.ac.za

Ms Luyolo Kamati kamatl@cput.ac.za
Ms Cheryl-Anne Wyngaard wyngaardc@cput.ac.za


Design
Bridgette hunt bahunt@wol.co.za
Ms Glenda Nevill glenda.nevill@cybersmart.co.za


Ms Michelle Pretorius michellep@ideadesign.co.za
Philip Kannemeyer philip@rsalitho.co.za
Brent Johnson brent@shumanimills.com


RESEARCH REPORT 2018 155
Print

+27 21 959 6767 info@cput.ac.za www.cput.ac.za @cput @wearecput www.facebook.com/cput.ac.za